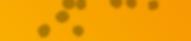

MM4, 22.1.2018 www.migrosmagazin.ch

Zivildienst S. 8 | Transfrau S. 18 | Schneeflocken S. 90
Farben statt Schulnoten –so funktionierts
Seite 78
Roman Camenzind: Wie entsteht ein Radiohit?
Seite 30

Seiten Tipps für Nostalgikerinnen und Romantiker
![]()
MM4, 22.1.2018 www.migrosmagazin.ch

Zivildienst S. 8 | Transfrau S. 18 | Schneeflocken S. 90
Farben statt Schulnoten –so funktionierts
Seite 78
Roman Camenzind: Wie entsteht ein Radiohit?
Seite 30

Seiten Tipps für Nostalgikerinnen und Romantiker


500 PRODUKTE nirgends günstiger

Nicht im abgebildeten Preis inbegriffen: Geschirr, Besteck, Brotkorb, Holzbrett. Details zu den Einzelpreisen finden Sie auf www.migros.ch/m-budget.










Vom 2.1. 2018 bis 29.1.2018 m 2 .1.2018 29.1. 2018



















































Einfach Kassenbon in Ihrer Migros-Filiale, auf migros.ch/win oder in der App einscannen und mit etwas Glück Migros-Geschenkkarten im Gesamtwert von Fr 250 000.– und 100 Millionen Cumulus-Punkte* gewinnen. Gratisteilnahme und Teilnahmebedingungen unter migros.ch/win *Hochrechnung basiert auf Erfahrungswerten.





«Wenn du das nochmals machst, kommst du in ein Kinderheim.» Diese Drohung spach Ändus Vater aus, als er seinen kleinen Sohn dabei erwischte, wie er die Kleider seiner Mutter anprobierte. Heute sagt sein Vater: «Es ist, wie es ist. Ich unterstütze dich.» Andreas heisst heute Andrea. 40 Jahre lang trug er das Geheimnis mit sich herum, bis er als Frau «die Reise in eine andere Welt antrat».
WMeine Kollegin Andrea Freiermuth hat Andrea und ihre Ehefrau Nelly zum Gespräch getroffen. Die Offenheit und Selbstverständlichkeit, mit der die beiden über die Entwicklung von Ändu zu Andrea sprachen (Artikel Seite 18), hat sie beeindruckt. Diese Woche zeigt das Schweizer Fernsehen einen DOKFilm über das ungewöhnliche Ehepaar, das sich nach wie vor liebt. Die alte, bipolare Welt, in der Frauen noch Frauen sind und Männer nur Männer, ist vorbei – und was heutzutage «normal» ist, muss neu verhandelt werden.
Denn als Transmensch ohne Stigma und Diskriminierung aufzuwachsen, ist auch im 21. Jahrhundert immer noch alles andere als normal. Zwei Beispiele: 325 Transgender wurden im vergangenen Jahr weltweit ermordet. Und seit Donald Trump regiert, hat sich das Leben von Transgendern in den USA wieder verschlechtert. Anfang des Jahres machte der Fall von Ashton Whitaker aus Wisconsin Schlagzeilen: Weil er als Mädchen geboren wurde, durfte er in der Schule nicht das Jungenklo benutzen. Zur Überwachung bekam er ein Armband verpasst. Er klagte – und wird nun mit 800 000 Dollar entschädigt.

Transgender- oder Frauenverachter wie Donald Trump beeinflussen die Debatte um die Geschlechter und die Haltung gegenüber Minderheiten. Es ist an der Zeit, im Umgang miteinander das Rollendenken durch einen neugierigen, unvoreingenommenen Geist auszutauschen. Ein Leben in einer Blase bringt niemanden weiter – auch unsere Gesellschaft nicht.
Sabine Lüthi, Mitglied der Redaktionsleitung a.i. sabine.luethi@migrosmedien.ch
8 Diese Woche
Immer mehr Männer wollen lieber Zivildienst leisten als zum Militär. Die Armee weiss, warum
10 Kalter Beruf
Die Skigebiete setzen auf sogenannte Shaper, die Parcours für Snowboarder bauen
17 Bänz Friedli
18 Transfrau Andrea Seltenes Glück: Nellys Liebe blieb, auch als aus ihrem Mann Andreas die Frau Andrea wurde
22 Virtuelle Unterhaltung
Die Genfer Firma Apelab sorgt mit Filmen für Smartphones und VRBrillen international für Furore. Demnächst auch in L.A.
25 Leserforum
30 Roman Camenzind Warum der erfolgreichste Popmusikproduzent der Schweiz auf Mundart setzt
42 Besuch bei Produzenten Eine Reise durch Südspanien führt zu MigrosProduzenten und berühmten Kulturstädten
45 Migusto Allerlei frittiertes Gemüse
61 Frage der Woche 64 Eigenmarken
66 Spinwin Weitere glückliche Gewinner
68 Neuheiten im Regal

71 Neues aus Ihrer Region Aktionen, Reportagen, News
77 Kolumne: «1, 2, oder 3?»
Stress mit dem richtigen Dress
78 Familie
In einer Schule in St. Gallen bekommen die Kinder Farben statt Noten
85 Stadt, Land, Stutz
86 Gesundheit
Mit Polarity die Lebensenergie zum Fliessen bringen
89 Migros Bank
Pensionierungsplanung ab 50
90 Kinder Wie Schneeflocken entstehen
93 Leseraktion Zypern
Eine Reise zu den Highlights der drittgrössten Mittelmeerinsel
95 Rätsel/Impressum (S.99)
100 Cumulus
102 Meine Welt
Der Traum der Slalomläuferin
Denise Feierabend
M-Infoline: Tel. 0800 84 0848 oder Fax +41 800 84 0848 (Ausland). www.migros.ch/kundendienst; www.migros.ch
Cumulus: Tel. 0848 85 0848* oder +41 44 444 88 44 (Ausland). cumulus@migros.ch; www.migros.ch/cumulus
Redaktion Migros-Magazin: Limmatstrasse 152, Postfach 1766, 8031 Zürich, Tel. 058 577 12 12, Fax 058 577 12 08. redaktion@migrosmagazin.ch; www.migrosmagazin.ch
* Normaltarif

Testen von 3 verschiedenen E-Bike-Modellen 3 ausgewählte E-Bike-Etappen im Elsass Wohnen auf der erstklassigen Excellence Allegra
Drei Tage fahren wir durch abwechlungsreiche Landschaften im Elsass und testen drei verschiedene E-Bike-Modelle. Für jeden E-Bike-Typ haben wir eine passende Strecke ausgesucht und kommen in den Genuss von facettenreichen Radstrecken. Jeden Tag steht uns ein anderes Modell zur Verfügung: Der klassische «Flyer», die sportliche Version «TDS Traveler» oder neu das «E-Mountainbike Uproc 1». Begleitet werden wir von unserem Twerenbold Komfortklasse-Bus und und dem fahrenden Hotelschiff Excellence Allegra.


1. Tag: Schweiz–Breisach.
Unser Bus bringt uns zum heutigen Etappenstart und wir lassen uns überraschen, welches Modell wir als Erstes testen und wohin die Velostrecke führen wird. Am späteren Nachmittag erwartet uns die Excellence Allegra zur Einschiffung in Breisach. Wir geniessen bei einem feinen Abendessen die Schifffahrt nach Strassburg und lassen einen geselligen Abend unter Gleichgesinnten ausklingen.
2. Tag: Strassburg–Breisach.
Nach unserem Frühstück starten wir unsere Etappe direkt ab Schiff oder fahren mit dem Bus in die Vogesen Region. Auch heute sind die verschiedenen Velostrecken abgestimmt auf das jeweilige E-Bike-Modell, das wir testen. Auf allen Touren haben wir die Möglichkeit ein individuelles und regionales Mittagessen der elsässischen Küche zu geniessen. Wiedereinschiffung in Breisach auf die Excellence Allegra. Am Abend tauschen wir unsere Tageserfahrungen in der Lounge und beim Abendessen aus. Schifffahrt bis nach Basel.
3. Tag: Breisach–Basel.
Wir geniessen unser Frühstück und verabschieden uns bereits von unserem Hotelschiff in Basel. Heute testen wir das letzte Modell unserer E-Bikepalette und freuen uns auf eine schöne Abschieds-Etappe. Unterwegs stärken wir uns mit einem feinen Mittagessen, ehe wir am späteren Nachmittag direkt nach Rütihof radeln oder mit dem Bus eintreffen. Anschliessend Busfahrt zu Ihrem Einsteigeort.
Schiffsbeschrieb und -plan: www.twerenbold.ch oder auf Anfrage
3 Tage ab Fr.
Reisedaten 2018 Reise 1 Reise 2 26.03.–28.03. 29.03.–31.03.
Unsere Leistungen
·Fahrt im Komfortklasse-Bus mit Veloanhänger ·Mietvelos inkl. Service und Reinigung ·Schifffahrt in der gebuchten Kabine ·2 x Halbpension an Bord ·Alle Velo- und Touristikausflüge gemäss Programm Twerenbold Veloshirt ·Erfahrene Veloreiseleitung und Reisechauffeur
Pro Person im DZ
Alleinbenutzung Standard Mittel-/Oberdeck 115 Alleinbenutzung Deluxe Mittel-/Oberdeck 215 Nicht inbegriffen
Persönliche Auslagen, Getränke, Trinkgelder Annullierungskosten- & Assistance-Versicherung 24 Auftragspauschale (entfällt bei Online-Buchung) 20
Abfahrtsorte
06:10 Wil p 08:00 Baden-Rütihof p 06:35 Winterthur 09:00 Basel 07:00 Zürich-Flughafen p

Darauf freuen wir uns
Ski-Weltcup Der Heimberg in Lenzerheide gilt als eine der schwierigsten Pisten für Frauen. Hier finden am 27./28. Januar zwei Riesenslaloms statt.
Filmfestival An den Solothurner Filmtagen vom 25. Januar bis 1. Februar dreht sich wieder alles um das Schweizer Filmschaffen.

Regula Bührer Fecker (39) ist Mitinhaberin der Werbeagentur Rod Kommunikation und zweifache Mutter. 2017 hat sie das Buch «Frauenarbeit» geschrieben.
Mein Bild der Woche «Beim Entrümpeln bin ich über ein persönliches Jubiläum gestolpert: Diese Woche vor 20 Jahren habe ich mein Maturitätszeugnis gekriegt. Ich dachte sofort an die vielen bis heute aktiven Freundschaften. An die Lehrerinnen und Lehrer. Dabei geriet ich ins Nachdenken: Wie wichtig es doch damals war, die Matura zu packen, das Zeugnis zu kriegen. Aber wenn man es hat, legt man es weg und vergisst es. Und die Noten darin sowieso. Das blaue Zeugnis zu haben, ist schön. Und war mal wichtig. Aber seine Kraft, seine Bedeutung schwinden. Verlöre ich es heute, wäre das vollkommen egal. Die Menschen und Erinnerungen, die ich damit verbinde, habe ich immer bei mir.»

Hörprobe
Entschuldigung, was hören Sie gerade?
Adrien Esseiva (25), kaufmännischer Angestellter, VillarssurGlâne FR
a) «Chop Suey!» von System Of A Down
b) «A Theater Of Dimensions» von Xandria
c) «Sorrow Is Your Tale» von Orden Ogan feat. Joacim Cans
Auflösung: c) «Ich bin ein FanMetal und habe diese Band kürzlich live gesehen. Nun schwelge ich in Erinnerungen.»

Unnützes Wissen Mord und Totschlag
Eine besonders brutale Tötungsmethode der kolumbianischen Mafia heisst «kolumbianische Krawatte».
Laut FBI sind in den USA immer etwa 50 Serienmörder aktiv.
In muslimischen Ländern gibt es weniger Morde, Selbstmorde und tödliche Gewalt als in nicht muslimischen.
Der Hamburger Serienmörder Fritz Honka, der in seiner Wohnung vier Frauen umbrachte und die Leichen dort versteckte, verschleierte seine Taten durch das massenweise Aufstellen von Duftsteinen.
Quelle: Stern/Neon
Ein Zivi unterstützt als Klassenhilfe Schüler während des Unterrichts.

Zahlen und Fakten
1,8
Millionen Zivildiensttage wurden im vergangenen Jahr in der Schweiz geleistet.
4500
Zivildienstleistende waren 2017 durchschnittlich pro Tag im Einsatz.
38
Prozent der Zulassungsgesuche für den Zivildienst wurden 2016 von Männern gestellt, die die Rekrutenschule der Armee abgeschlossen hatten.
Diese Woche
Immer mehr Männer wollen lieber Zivildienst leisten, als zum Militär zu gehen. 6785 neue Zivis wurden im vergangenen Jahr zugelassen – seit Jahren steigt die Zahl. Der Bundesrat will mit einer Gesetzesrevision dagegenhalten.
Text: Lisa Stutz
Ob im Altersheim oder auf der Alp: Täglich sind im Land junge Männer als sogenannte Zivis im Einsatz. Sie haben alle unterschrieben, dass ein Militärdienst nicht mit ihrem Gewissen vereinbar ist. Deshalb setzen sie sich auf andere Weise für die Gesellschaft ein. Die Dauer des Zivildiensts beträgt das Anderthalbfache des theoretisch noch zu leistenden Militärdiensts. Vom Jahr 2011 bis ins Jahr 2017 sind die Zulassungen zum Zivildienst von 4670 auf 6785 gestiegen. Gegen diesen Trend will
der Bundesrat mit einer Revision des Zivildienstgesetzes vorgehen. Vor allem für die Männer, die nach abgeschlossener Rekrutenschule zum Zivildienst wechseln wollen, soll der Zugang erschwert werden, zum Beispiel mit einer Wartefrist von einem Jahr. Und er soll nur möglich sein, wenn noch mehr als 150 Diensttage zu leisten sind.
Die Massnahmen sollen dazu führen, dass wieder mehr Männer der Armee zur Verfügung stehen. Denn im Gegensatz zum Zivildienst hat sie mit zu wenigen Soldaten zu kämpfen. Vonseiten des
Militärs hat man eine Idee, weshalb viele Männer zum Zivildienst wechseln. «Einzelne Befragungen bei den jungen Leuten weisen darauf hin, dass es ihnen in erster Linie um die Flexibilität und persönliche Aspekte geht», sagt Armeesprecher Daniel Reist. «Sie schlafen in der Regel zu Hause und haben fixe Arbeitszeiten. Das ist in der Armee anders.»
Zivildienstleiter Christoph Hartmann erklärt im Interview, warum es möglich sei, dass viele Männer erst nach der Rekrutenschule Gewissensbisse haben.
Christoph Hartmann
«Wir sollten aufhören, Armee und Zivildienst gegeneinander auszuspielen»
Wie erklären Sie sich den stetigen Anstieg der Zivildienstleistenden?
Je mehr Männer sich für den Zivildienst entschieden haben, desto mehr erfahren andere davon. Der Zivildienst ist mittlerweile Teil der Schweizer Landschaft geworden.
Und wird von vielen als attraktiver empfunden als die Armee. Warum? Letztlich wissen wir das nicht ganz genau. Ein Grund mag sein, dass sich die Männer ihre Einsätze grösstenteils selber aussuchen können. Sie haben Einfluss darauf, wann und wo sie ihren Dienst leisten. Es sind also die Bedingungen, die attraktiv sind.
Zu attraktiv?
Das ist schwierig zu sagen. Die Frage ist immer, womit man vergleicht. Offenbar ist der Zivildienst genügend attraktiv, dass junge Männer, die aus Gewissensgründen nicht Militärdienst leisten können, bereit sind, trotzdem einen persönlichen Dienst zu leisten. Obwohl dieser eineinhalb Mal länger dauert als in der Armee.
Wollen diese Männer nicht viel eher einfach die Armee umgehen?
Wir stellen fest, dass bei vielen die Wahrnehmung da ist, frei wählen zu können, und man so zum Beispiel auch nach der Rekrutenschule zum Zivildienst wechselt. Der Bundesrat will mit einer Gesetzesrevision klarstellen, dass das keine freie Wahl ist. Es muss ein Gewissenskonflikt da sein. Bei der Revision geht es deshalb auch darum, den Wechsel nach abgeschlossener Rekrutenschule zum Zivildienst schwieriger zu machen.
Knapp 40 Prozent der Gesuchsteller haben die Rekrutenschule absolviert. Ist es realistisch, dass derart viele Männer plötzlich in einen Gewissenskonflikt geraten?
Das wissen wir nicht. Früher mussten die Männer sich vor einer Kommission erklären. Seit 2009 reicht es, den Gewissenskonflikt durch eine Unterschrift zu bezeugen und den Tatbeweis zu erbringen: Die Männer leisten bei
uns mehr Diensttage als in der Armee und beweisen damit, dass es ihnen ernst ist. Ob alle tatsächlich einen Gewissenskonflikt haben, können wir nicht wissen. Denn wo fängt ein solcher an und wo hört er auf? Es ist daher auch schwierig zu beurteilen, ob jemand wirklich keinen Konflikt hat.
Die Vermutung, dass es so ist, liegt nahe.
Ich habe lange beim IKRK gearbeitet. Im Ausland bin ich erfahrenen Berufsmilitärleuten begegnet, die einen schweren Fall erlebt haben – und dann merkten, dass sie keinen Militärdienst mehr leisten können. Über einen Gewissenskonflikt entscheiden wir nicht nur ein Mal im Leben. Wenn jemand zum Beispiel Vater wird, können sich seine Überzeugungen ändern.
Der Wechsel nach der RS soll also weiterhin möglich bleiben.
Genau. Am Grundsatz, dass Schweizer Männer Militärdienst leisten und bei einem Gewissenskonflikt zu einem zivilen Ersatzdienst Zugang haben, ändert sich auch mit einem neuen Gesetz nichts. Diese Tür soll offen gelassen werden, aber der Einsatz soll höher werden. Es geht darum, die Wahrnehmung wieder zu verändern.
Waren Sie selber im Militär?
Ja, ich war Oberleutnant. Von dieser Ausbildung habe ich profitiert. Ich achte die Armee und den Zivildienst sehr. Wir sollten aufhören, beide Institutionen gegeneinander auszuspielen. Schliesslich haben wir dasselbe Ziel: dass junge Männer einen persönlichen Dienst am Land leisten. Und nicht einfach den «blauen Weg» wählen, also Ersatzabgaben bezahlen.
Werden weiterhin immer mehr junge Männer den Zivildienst wählen?
Eine sichere Prognose ist nicht möglich. Wir müssen davon ausgehen, dass die Zahlen weiter steigen. Darum hat der Bundesrat beschlossen, Massnahmen zu ergreifen. Auch die Armee führt Neuerungen ein, sie wird flexibler und damit attraktiver. MM

Strassenumfrage
Waren Sie im Militär oder im Zivildienst?

Christof Gertsch (36), Bern, Journalist «Damals war ich Schwimmer und konnte eine Art SportlerRekrutenschule machen. Heute würde ich aus ideologischen Gründen wohl den Zivildienst bevorzugen.»

Paul Marti (55), Lenzburg AG, Verkaufsleiter «Ich wurde als untauglich eingestuft, deshalb habe ich den Zivilschutz gemacht. Das war nicht schlimm für mich, denn ich wollte nicht unbedingt in die Armee.»

Nico Bachmann (27), Volketswil ZH, Informatiker «Ich habe die RS gemacht. Das war eine gute Lebensschule. Trotzdem habe ich oft darüber nachgedacht, zum Zivildienst zu wechseln – und bin doch geblieben.»

Sein Outfit und sein Arbeitsgerät verraten, was er tut: Andrin Tgetgel arbeitet als Shaper und baut Parcours für Freestyler auf Ski und Snowboards.
Snowpark-Bauer
Viele Skigebiete locken mit einem Snowpark junge Gäste an. Die Parcours werden von Shapern gebaut, die nur für ihren Sport leben – ein Augenschein in Zermatt.
Text: Andrea Freiermuth Bilder: Dominic Steinmann
Zermatt, 7.15 Uhr, zwischen der Talstation Furi und dem Bergrücken «Trockener Steg». Rund 50 Mitarbeiter der Bergbahnen schweben mit der ersten Gondel des Tages hinauf zur Arbeit. Mit dabei sind Matteo Ferraris (36), Matteusz Bocian (26) und Andrin Tgetgel (18). Mit ihren langen Haaren und weiten Klamotten fallen sie auf zwischen all den Bergbähnlern in ihrer herkömmlichen Arbeitskleidung. Ihr Style ist Programm, denn die drei arbeiten nicht wie alle anderen Angestellten als Seilbähnler, Mechaniker oder Elektroniker, sondern als Shaper. Sie bauen den Snowpark für Freestyler auf Ski und Snowboards – mit Elementen wie Kickers, Rails und Tubes.
Die Halsschläuche bis über die Nase hochgestülpt und die Mützen tief ins Gesicht gezogen, machen sich die drei vom Trockenen Steg mit dem Sessellift zum Theodulgletscher auf. Auf 3200 Meter über Meer bläst eine steife Brise. Das Panorama hingegen ist grandios: Gegen Westen erstrahlt das Matterhorn im Morgenlicht, im Osten stürzt das Eis über die steile Flanke des Breithorns.
Lieber PS als Muskelkraft Warwick Martin (25), Dreitagebart und Rossschwanz, hat bereits Stunden zuvor mit der Pistenmaschine den Schnee zwischen den Elementen präpariert. Jetzt schiebt er mit seiner 530PSMaschine Schnee herum. Hier soll ein Funpark mit kurvigen Hügeln entstehen. Warwick war früher selber Shaper und weiss, was zu beachten ist. Handarbeit sagte ihm aber nicht so zu, er steht auf
starke Motoren. «Look, das ist wie Gamen, aber eben in Reality», sagt er in einem Mischmasch aus Englisch und Schweizerdeutsch. Dann greift er nach dem Joystick, mit dem er die tonnenschwere Maschine souverän steuert.
Während Warwick der Mann fürs Grobe ist, sind Matteo, Matteusz und Andrin für die Feinarbeit zuständig. Mit der Konzentration eines Kunstmalers zieht Matteo das Shaper-Tool, eine gezackte Schaufel mit langem Stil, durch den Schnee. Bald werfen feine Rillen einen leichten Schatten ins Weiss rund um die Schanzen: «Das sieht nicht nur gut aus, sondern dient auch der Orientierung – und Safety kommt immer first», erklärt er auf Englisch.
Headshaper anstatt Architekt Später wird Matteo in der ShaperGarderobe, einem fensterlosen Raum auf dem Trockenen Steg, wo es nach feuchten Skisocken riecht, von seinen Verletzungen erzählen: Darunter sind ein Lendenwirbelbruch, mehrere Blessuren an Knie und Ellenbogen, und Schultergelenke, die immer wieder mal auskugeln. Er lacht und sagt: «Der Fehler lag immer bei mir, wenn etwas passierte.» Er sei jeweils einfach nicht ganz bei der Sache gewesen. Nicht nur Matteos Narben, auch seine Tattoos sind Erinnerungen an die Verletzungen: Ein Skelett symbolisiert die Knochenbrüche, ein Pirat die wilden Ritte über die weissen Wogen. Matteo stammt aus Turin und hat für das Snowboarden ein Architekturstudium abgebrochen. Er war auf dem Brett so gut, dass er für Shootings gebucht wurde und noch heute

einen Sponsor hat. Bereut hat er seinen Entscheid für den Schnee nie: «Anstatt Häuser baue ich jetzt Schanzen, und seit ich in der Schweiz arbeite, kann ich sogar davon leben.» Als Headshaper verdient er 4500 Franken im Monat. Matteusz würde mit einem 100ProzentPensum auf 3600 Franken kommen, hat aber nur ein halbes Pensum. Der Warschauer hat in seiner Heimat einige Jahre lang als Studiofotograf gearbeitet: «Ich
Safety first: Headshaper Matteo Ferraris zieht Rillen in den Schnee, die den Fahrern als Orientierungshilfe dienen.
Südostasien Highlights Kreuzfahrt mit „Premium Alles Inklusive“
17 Tage inkl. An-/Rückreise ab Fr. Nonstop-Flüge! 2‘690.-


Inklusive 2 Tage in Singapur!
Premium-Kreuzfahrt zum attraktiven Aktionspreis!
Ihr Reiseprogramm 4.12.2018 - 20.12.2018
4.12. Zürich - Singapur. Fluganreise mit Swiss.

5.12. Singapur (Singapur). Transfer zum Hafen. Singapur ist eine Stadt mit tausend Gesichtern. Vom exotischen Viertel Little India taucht man unversehens in die koloniale Pracht des Parlamentsgebäudes, des Victoria Theaters und des Empress Place Building ein. Auf den Spuren früherer Kulturen können Sie zum Thian Hock KengTempel und zur Sultan-Moschee wandern. Der Arab Street District und Chinatown vervollständigen das Mosaik dieser facettenreichen Stadt. Einschiffung und Übernachtung an Bord.
6.12. Singapur (Singapur). Tag zur freien Verfügung. Abfahrt um 19.00.
7.12. Erholung auf See.
8.12. Ko Samui (Thailand)
07.00 - 17.00. Die kleine, idyllische Insel Ko Samui im Südwesten des Golfs von Thailand bietet an ihrer etwa 30 Kilometer langen Küste herrliche Strände mit goldgelbem bis weissem Korallensand und türkisfarbenem Wasser. Die paradiesische Umgebung erinnert an einen Südseetraum: endlose Palmenhaine, einsame Strände, bizarre Felsenformationen und kleine, ursprüngliche Dörfer.
9.12. - 10.12. Bangkok / Laem Chabang (Thailand) Ankunft um 07.00. Bangkok ist heute eine moderne Metropole mit futuristischen Gebäuden, eleganten Einkaufszentren und luxuriösen Hotels. Dazwischen ist jedoch immer noch viel Platz für historische Tempel und traditionelle Häuser mit den ty-



Frühbucher bis 8.2. Fr.
Rabatt


pischen spitzen Dächern. Übernachtung an Bord und Abfahrt am Folgetag um 02.00.
11.12. Erholung auf See.
12.12. Ho-Chi-Minh-Stadt / Saigon (Vietnam) 06.30 - 19.00. Kontrastreicher geht es kaum noch, wenn Sie sich vom Hafen Phu My in Richtung Ho-Chi-Minh-Stadt, des ehemaligen Saigons, begeben. Vorbei an grünen Reisfeldern und kleinen Tempelpagoden erreichen Sie eine Stadt, in der Luxuslimousi nen, Lastenkarren und zigtausende Fahrrä der die Strassen säumen. Besuchen Sie die Kathedrale Notre Dame, die alte Post und das Regierungsgebäude oder lassen Sie die üppige Vegetation des Mekong-Deltas auf sich wirken.
13.12. Erholung auf See.





schee, eine Kirche oder ein buddhistischer Tempel. Die Insel ist grösstenteils von tropischem Regenwald bedeckt und sehr naturbelassen.
17.12. Langkawi (Malaysia) 06.30 - 23.00. Die Insel Langkawi fasziniert immer wieder aufs Neue. Von traumhaften Stränden, über Dschungel, bis hin zu Wasserfällen – Langkawi bietet Natur pur. 18.12. Erholung auf See. 19.12. Singapur (Singapur) 03.00. Ausschiffung morgens und Transfer zum Flughafen inklusive Stadtrundfahrt. Rückflug mit Swiss nach Zürich. 20.12. Ankunft in Zürich.



14.12. - 15.12. Kuala Lumpur / Port Klang (Malaysia) Ankunft um 18.30. Von Port Klang aus lohnt es sich, einen Tagesausflug nach Kuala Lumpur, der Hauptstadt von Malaysia, zu unternehmen. Übernachtung an Bord und Abfahrt am Folgetag um 18.00.
16.12. Penang (Malaysia) 08.00 - 20.00. Das Spezielle an Penang ist, dass verschiedene Kulturen nebeneinander leben. Meist befindet sich unweit eine Mo-
1 Über 10 0 Markengetr än ke
1 Spit zeng astr onomie
1 Se rv ic e am Plat z
1 Geniessen rund um die Uhr

1 Sa un a un d Fitnes s
1 En te rt ainmen t



Inbegriffene
l Eigene Schweizer Reiseleitung*
l Nonstop-Flug mit Swiss ZürichSingapur - Zürich in Economy

Kreuzfahrt mit Vollpension 14 Nächte an Bord 1 Übernachtung an Bord in Singapur
Trinkgelder an Bord l Alle Getränke gemäss dem TUI

1 Kinderbetreuun g
Ihr Schiff: Mein Schiff 3 ★★★★★
Baujahr 2014 • Renovierung 2016 • Bordsprache Deutsch • 293 Meter lang / 36 Meter breit • 15 Decks • 1’253 Kabinen • 13 Bars • 11 Restaurants • 2 Swimmingpools • 4 Whirlpools • Wellness- & Spa-Bereich • Casino • Theater
Premium Alles Inklusive-Angebot
Stadtrundfahrt in Singapur Alle Transfers
Flug-/Hafentaxen

Alle Preise p. P. in CHF bei Doppelbelegung. Einzelkabinen auf Anfrage. Frühbucher (pro Kabine) bereits berücksichtigt. Ideales Reisedatum 4.12.2018 - 20.12.2018
Innenkabine A
Aussenkabine B





Mit JAMAIKA, und
Nur Mein Schiff ® hat Premium Alles Inklusive Erfahren Sie mehr bei Cruisetour.
* Flex-Preis (limitiertes Kontingent) für 14 Tage p. P. bei 2er-Belegung einer Balkonkabine ab / bis Hafen. An-/ Abreise nach Verfügbarkeit zubuchbar. Der angegebene Preis in Schweizer Franken (CHF) ist ein Referenzpreis. Er beruht auf dem Wechselkurs von EUR zu CHF 1,08 (Stand 07.07.2016). Der tatsächlich zu bezahlende Preis in CHF hängt vom jeweiligen Tageswechselkurs der Banken sowie eventuell anfallenden Gebühren ab. | TUI Cruises GmbH · Anckelmannsplatz 1 · 20537 Hamburg · Deutschland
Aussenkabine A Balkonkabine F Balkonkabine D
Balkonkabine B




1 Beim Parkbau werden mit dem Pistenfahrzeug Unmengen von Schnee bewegt. 2 Warwick, Herr über 530 PS: «Look, das ist wie Gamen, aber in Reality.» 3 Immer ein wenig am Handy: Matteo pflegt seinen Facebook-Auftritt. 4 Andrin und Matteusz chillen in der Shaper-Garderobe.
Shredder: Ein Freestyler auf Ski oder Snowboard, der über Elemente fährt. Der Begriff stammt vom englischen Wort für schreddern, angelehnt an das Geräusch, das die Boards und Ski erzeugen, wenn sie über die Holz-, Metall- und Plastikelemente gleiten.
Kicker: Eine einfache Schanze. Sie trägt ihren Namen, weil sie den Ski- oder Snowboardfahrer durch die Luft kickt. Die Flugdistanz ergibt sich aus Neigung und Höhe des Absprungs.
Tubes: Röhren, die analog zu den Rails in die Parcours integriert werden.
Big Air: Dabei handelt es sich um einen grossen Kicker (Schanze), über den die Fahrer springen und versuchen, die längere Flugphase für möglichst schwierige Tricks zu nutzen. An den Spielen in Pyeongchang in Südkorea im Februar ist die Disziplin Big Air erstmals für Snowboarder olympisch.
hatte einen Nine-to-Five-Job und einen guten Lohn.» Zum Shapen in die Schweiz sei er nicht des Geldes wegen gekommen, sondern aus Leidenschaft für den Sport. Der Fotograf betreut auch den InstagramAuftritt des Parks. Die Community liked Fotos auf dem Account «Snowparkzermatt» im Schnitt rund 500-mal, Videos begeistern zuweilen sogar über 5000 Personen.
Einer der beliebtesten Clips – mit über 6000 Aufrufen – zeigt Andrin, wie er auf Ski über Rails und Tubes durch den Snowpark gleitet oder shredded, wie es im Freestyle-Slang heisst. Andrin stammt aus Laax und hat seine Fans mit nach Zermatt gebracht, via Social Media.
Andrin hat im vergangenen Jahr eine Lehre als Schreiner abgebrochen. Das Shapen ist für ihn eine Zwischenlösung: «Meine Eltern hatten gar keine Freude, aber sie sind froh, dass ich jetzt nicht einfach rumhänge.» Es ist ihm bewusst, dass er noch eine Ausbildung abschliessen sollte, er weiss aber noch nicht, welche:
«Ich bin auf der Suche und hoffe, dass mich das Shapen irgendwie in die richtige Richtung lenkt.» Immerhin: Im Snowpark feilt der Bündner nicht nur am Schnee, sondern übt auch sein Englisch, das er erstaunlich gut spricht, wenn man bedenkt, dass er die Schule mit 16 verlassen hat.
Vorbilder für die Kleinen Um 10 30 Uhr haben Matteo, Matteusz und Andrin im Park sämtliche Schanzen nachgebessert und sitzen zwecks Testride auf dem Sessellift. Da sie keine neuen Elemente gebaut haben, ist das Testen theoretisch unnötig, aber die Crew hat auch den Auftrag, die Gäste zu animieren: «Oft sind es die Kinder, die ihre Eltern erst überreden müssen, doch einen Abstecher in den Park zu machen. Wenn die Erwachsenen an unserem Beispiel sehen, dass die Kickers harmlos sind, willigen sie eher ein.» Obwohl die Shaper ihren Snowpark gern als autonome Zone sehen würden, unterstehen sie den Weisungen der Berg-
Table: So heisst der Bereich zwischen dem Absprung der Schanze und der Landezone, den es zu überspringen gilt. Er ist in der Regel horizontal. Profis springen über Tables von bis zu 25 Metern Länge.
Sweet Spot: An diesem Punkt ist die Landung am sanftesten und ungefährlichsten. Entscheidend für den Sweet Spot sind die Distanz zum Absprung und die Neigung: je steiler der Absprung, desto steiler die Landung und umgekehrt.
Rails: Das sind Geländer, die in den Snowpark integriert werden. Die Shredder springen und gleiten darauf.
Slopestyle: Bei dieser Disziplin gilt es, einen Parcours, bestehend aus verschiedenen Kickers, Rails und anderen Elementen, zu absolvieren. Punktrichter beurteilen dabei die Kreativität, den Schwierigkeitsgrad und die Ausführung der Sprünge und Tricks. Die Disziplin ist seit 2014 sowohl für Skifahrer als auch Snowboarder olympisch.
Halfpipe: Es handelt sich dabei um einen Schneekanal. Die Fahrer holen darin Schwung und springen auf beiden Seiten der Halfpipe über deren Kanten. Die Disziplin ist seit 1998 olympisch, allerdings nur für Snowboarder. Olympische Halfpipes sind rund 20 Meter breit und 6,5 Meter hoch. Erster Olympiasieger war Gian Simmen.
Mein Laden stellt mehr Produkte her, als andere im Sortiment haben: rund 10 000.

Migros-Besitzer Béla A.



















Die Migros gehört den Leuten. Deshalb bietet sie beste Qualität zum besten Preis an. Um das zu ermöglichen, stellt die Migros einen Grossteil ihrer Produkte selber in Schweizer Betrieben her. migros.ch/besitzer



Klick-Generator: Die Fotos und Clips mit Sprüngen von Andrin Tgetgel generieren auf Social Media besonders viel Beachtung.
bahnen. Im Winter haben die Jungs den klaren Auftrag, das Niveau tief zu halten und den Park kinder- und einsteigerfreundlich zu gestalten.
Im Sommer, wenn sich der Snowpark nochmals mehr als 1000 Höhenmeter weiter oben, auf dem Matterhorn Glacier Paradise, befindet, haben die Shaper mehr Gestaltungsspielraum.
Dann nämlich kommen die Cracks und Profis der Szene, und die gehen grössere Risiken ein. Für die Shaper-Crew bedeutet das viel mehr Arbeit, weil es für grössere Hindernisse mehr Schnee zu schaufeln gibt und dieser in der Sommersonne erst noch viel schwerer ist und schneller wegschmilzt.
Abends in der Shaper-WG
In der vergangenen Sommersaison hat Marcel Brünisholz (28) so viele Überstunden angehäuft, dass ihm sein Chef momentan verboten hat, sich im Skigebiet zu zeigen. Der Berner Oberländer ist seit zehn Saisons dabei und der Kopf der Truppe. Er hat für die Shaper bessere Löhne ausgehan-
delt, ein Haus in Zermatt organisiert – und er entwirft jeweils den Parcours und setzt die genaue Abfolge und die optimalen Distanzen zwischen den Elementen fest.
«Um von den Bergbahnen ernst genommen zu werden, mussten wir uns professionalisieren», erzählt der gelernte Mediamatiker abends am Küchentisch in der Shaper-WG, einem Chalet am Waldrand. «Der Park ist Werbeträger, gerade im Sommer, wenn andere Skigebiete bereits geschlossen haben», sagt er mit gedämpfter Stimme, was seinen Worten irgendwie noch mehr Gewicht verleiht. Die Kids verfolgten den Betrieb auf dem Gletscher auch in der warmen Jahreszeit, dann gäbe es Posts, die in der relevanten Zielgruppe rund eine Viertelmillion User erreichten – und das, etwa im Vergleich zur Plakatwerbung am Hauptbahnhof Zürich, für praktisch kein Geld.
Marcel betrachtet es als seine Mission, den Verantwortlichen bei den Bergbahnen aufzuzeigen, wie Werbung in Zeiten von Facebook und Instagram funk-
tioniert. Dafür bringt er grosse Opfer: «Ich trage meine Haare jetzt kurz und die Hosen nicht mehr an den Knien.»
Die Strategie scheint aufzugehen. Auf Anfrage meint Markus Hasler (59), CEO der Zermatt Bergbahnen: «Der Snowpark ist für uns unter anderem ein Marketinginstrument und eine Investition in die Jugend.» Er würde den Einsatz der ShaperCrew sehr schätzen, auch wenn die Jungs nicht immer die einfachsten Angestellten seien: «Das sind schräge Vögel, die zuweilen auf Wolke sieben schweben – aber eben auch mit Leib und Seele dabei sind.»
Würde der CEO je um 22 Uhr abends in der Shaper-WG auftauchen, wäre er wahrscheinlich erstaunt: keine Party und kein Qualm. Um diese Uhrzeit haben sich alle schon in ihre Einer- oder Zweierzimmer zurückgezogen, sogar die Küche ist aufgeräumt. Trotz viel Freestyle gibts auch hier klare Regeln, eine davon ist auf A4 und in grossen Lettern an den Schrank geklebt: «Fucking wash your shit after using!» MM
Service Paradiese für Freestyler
Das Portal Bergfex.ch listet 34 Snowparks in der Schweiz auf. Der in Zermatt ist dank des Gletschers auch im Sommer geöffnet. Das grösste Angebot im Winter haben jedoch Laax und Arosa-Lenzerheide.
Laax gilt sogar als das führende FreestyleResort für Freeskier und Snowboarder in den Alpen. Die Region hat die längste fortwährende Halfpipe der Welt und insgesamt vier Snowparks, die unterschiedliche Niveaus bieten. Ab dieser Saison gibt es in Laax zudem ein reduziertes Tagesliftticket für 52 Franken, das nur in den Snowparks gültig ist. Mit der Freestyle Academy bietet Laax zudem einen Indoor-Spielplatz für Snowboarder und Freeskier, die auch im Sommer an ihren Tricks feilen möchten.
Arosa-Lenzerheide will sich ebenfalls als Freestyle-Paradies etablieren. Im Park’n’Pipe Tschuggen lassen sich drei unterschiedlich anspruchsvolle Linien fahren, zudem lockt eine Minipipe. Auf der Abfahrt zur Talstation Weisshornbahn gibt es einen CO2-neutralen Naturpark mit Elementen aus heimischem Tannenholz. Und in der Jib-Area bei der Alp Stätz können sich Anfänger an Sprünge und FunElemente herantasten.



Traumhafte Reisekombination zum Einführungspreis!


5 Reisetage inkl. Halbpension ab nur
- Alles schon dabei!

Auf dieser einmaligen Aktionsreise zeigen wir die zauberhafte Barockstadt Dresden mit allen Facetten. Wir erleben Dampfzugromantik wie zu Grossvaters Zeiten auf einer der schönsten Zugstrecken Deutschland und erkunden mit dem märchenhaften Spreewald und der sächsischen Schweiz zwei Naturparadiese der Superlative. Sichern Sie sich jetzt Ihre Plätze.
Ihr Reiseprogramm:
1. Tag, Samstag – Anreise nach Dresden Fahrt im komfortablen Extrabus nach Dresden, wo wir in unserem Hotel mit dem Nachtessen erwartet werden.
2. Tag, Sonntag – Dresden Wer nach Dresden kommt, spürt sehr bald das Besondere, Eigentümliche und Faszinierende dieser viel gerühmten Kunst- und Barockstadt. Das Stadtbild wird geprägt von historischen Baudenkmälern wie der Semperoper, der Frauenkirche, der Hofkirche und dem Zwinger, einer kunstvollen Barockanlage, in der sich heute mehrere Museen befinden. Freuen Sie sich nach dem Frühstück auf eine interessante Stadtführung unter kundiger Leitung und erfahren Sie mehr über die bewegte Geschichte der Stadt! Der Nachmittag bleibt Ihnen für eigene Entdeckungstouren zur freien Verfügung – Zeit zum Staunen und Geniessen. Nachtessen im Hotel.

3. Tag, Montag – Märchenhafter Spreewald
Heute unternehmen wir einen fantastischen Ausflug in den Spreewald. Die märchenhafte Flusslandschaft ist derart schön und einzigartig, dass sie seit 1990 zum Weltkulturerbe der UNESCO gehört. Bei einer Rundfahrt erfahren wir alles über das Leben an den Spreefliessen und warum die Spreewaldgurken so lecker sind. Wir unternehmen eine fantastische Kahnfahrt durch urwüchsige Wälder, üppige Flora und Fauna - vorbei an schilfgedeckten Bauernhäusern. Die Fährmänner erzählen so manche Anekdote aus der Zeit, als die Post noch überall per Kahn zugestellt wurde. Lehnen Sie sich zurück und tauchen Sie ein in die wunderschöne Naturwelt! Nachtessen im Hotel.
4. Tag, Dienstag – Dampfzugromantik & Sächsische Schweiz
Wir starten den Tag mit einem Nostalgie-Erlebnis der Superlative: einer Fahrt mit dem legendären Dampfzug der Weisseritztalbahn. Bereits seit 1882 dampft die Schmalspurbahn auf 750

mm Spurweite durch fantastische Landschaftsstriche und begeistert jeden Fahrgast. In Dippoldiswalde steigen wir auf den Bus um und beginnen unsere Panoramarundfahrt durch das Osterzgebirge und das wildromantische Müglitztal. Vor uns liegt eine herrliche, skurrile Landschaft aus feinem Elbsandstein: die sächsische Schweiz! Sie zählt zu den schönsten Landschaften Europas. Nachtessen im Hotel.
5.Tag, Mittwoch – Heimreise Nach dem Frühstück treten wir mit vielen unvergesslichen Eindrücken im Gepäck die Heimreise an.
Noch mehr sparenbis 100% REKA-Checks!
Organisation: Holiday Partner, 8852 Altendorf

✓ Fahrt im komfortablen Extrabus nach Dresden
✓ 4 Übernachtungen im gehobenen Mittelklassehotel Quality Inn Dresden West ***
✓ 4 x Frühstück im Hotel
✓ 4 x Nachtessen im Hotel
✓ Interessante Stadtführung in Dresden
✓ Romantische Kahnfahrt im Spreewald
✓ Besichtigung Gurkeneinlegerei im Spreewald
✓ Fahrt mit der Weisseritztalbahn Freital-Dippoldiswalde
✓ Panoramarundfahrt Sächsische Schweiz
✓ Eigene Schweizer Reiseleitung während der ganzen Reise
Unser Aktionspreis für Sie:
Preis pro Person im Doppelzimmer im gehobenen Mittelklassehotel Quality Inn Dresden West *** Fr. 499.- *
Unser Sonderpreis für Sie:
* Superspardatum
Nicht inbegriffen/zusätzlich wählbar: Zuschlag Reisen a, b & c: Fr. 40.Einzelzimmerzuschlag nur Fr. 100.Buchungsgebühr: Fr. 20.- pro Person
Sie wählen Ihren Bus-Einsteigeort: Aarau, Basel, Bern, Luzern, Pfäffikon SZ, Sargans, St. Gallen, Thun, Wil SG, Winterthur oder Zürich
Anzeige

Bänz Friedli
LLadde-bii, ladde-bi-ii …», singt der Barpianist, «ladde-bii, ou, ladde-bii …» Niemand scheint ihm zuzuhören, er zersingt den Song zur Unkenntlichkeit. Und während ich mich noch frage, wie man im Englischen einen solchen Akzent haben kann, merke ich, dass es sich bei seinem «Spikinn’ worzov wisdoms, laddebii …» vermutlich um «Let It Be» handelt. Ist er Slowake, Bulgare, Ukrainer? Er hat den sprichwörtlich einsamsten Job der Welt. Halbe Nächte lang muss ein Barpianist sich Turtelnde ansehen, auf ihn wartet niemand.
Dass keiner applaudieren würde, hat der Pianist geahnt, er hängt dem Schlussakkord sogleich das nächste Stück an. Mit der Könnerschaft eines, der dies seit vielen Jahren tut. Und doch fahrig. Virtuos, aber klimpernd. Ein Sound, wie ihn nur Barpianisten draufhaben. Sie musizieren mit der Beiläufigkeit, mit der Piloten ins Mikrofon nuscheln: betont lässig, etwas lieblos, routiniert. Auf dem BechsteinFlügel, oben, wo sich die Notenablage befände, liegt ein zusätzliches E-Piano, dem er per Tastendruck kaugummige Geigen und kunststoffene Perkussion entlockt. Ist er sich der Absurdität bewusst, wenn er John Lennons Zeile «Imagine no possessions» just hier singt? Wir befinden uns in einer sehr noblen Hotellobby irgendwo in den Bergen. Er – Hemd, Gilet, locker gebundene Krawatte mit farblich unpassendem Dackelmotiv – ist nicht allein. Auf einem Barhocker neben dem Flügel, die
Beine übereinandergeschlagen, sitzt sie mit rötlichbraun getöntem Haar im Abendkleid. Im Wechsel singen sie. «Song Sung Blue», «Stand By Me», «Country Roads», all die Klassiker. Und bei «Sorry Seems to Be the Hardest Word» gar im Duett. Hintergrundmusik.
Da, plötzlich! «Diamante», ein Canzone von Zucchero. Die Frau singt mit hörbar gesteigerter Leidenschaft. Das Lied handelt in der Zeit unmittelbar nach dem Zweiten Weltkrieg, «soldati e spose» ziehen darin vorbei, junge Brautpaare. Und weil die aus der Armee entlassenen Bräutigame keine eleganten Kleider besassen ausser der Uniform, heirateten sie darin. In sachter, erst pastellener Hoffnung auf bessere Zeiten.
Nun bin ich echt ergriffen. Pianist und Sängerin werfen sich Blicke zu. Vielleicht sind sie nicht gemeinsam einsam, sondern ein Paar? Ich könnte sie fragen. Lieber aber stelle ich mir vor: dass sie Ilja und Eliška heissen, bald eine eigene Bar in Bratislava eröffnen, Kinder bekommen. An manchen Abenden, umgeben von ihren Liebsten und engen Freunden, werden sie aufspielen. Es muss kein Flügel sein, ein altes Klavier tuts auch. Und alle werden in «Ladde-bii, ladde-bi-ii …» mit einstimmen. Ein Fest wird das sein! MM
Bänz Friedli live:
24.1. Frick AG, 26.1. Brütten ZH, 3.2. Aesch ZH




SchweizerischeStiftungfür das cerebral gelähmteKind www.cerebral.ch

Wirdankendem Verlag für diefreundliche Unterstützung diesesInserates.
Sp end en ko nt o: 80 -4 8- 4


Nelly küsst ihre Ehefrau Andrea genauso liebevoll wie damals, als diese noch Andreas hiess.

Transidentität
Nelly von Aesch musste sich in den vergangenen 16 Jahren schrittweise von ihrem Mann Andreas verabschieden. Aus Andreas ist Andrea geworden – und heute liebt Nelly eine Frau.
Text: Andrea Freiermuth Bild: Beat Schweizer
Als Nelly fremde Damenkleider in der Garage fand, war sie gerade mal ein Jahr mit Andreas verheiratet. Sie war schockiert, stellte sich ihren Mann mit einer anderen Frau vor und wollte von ihm wissen, wem diese Kleider gehörten. Zur Rede gestellt, sackte Andreas förmlich in sich zusammen und sagte: «Jetzt weisst du es also.» Was er ihr dann aber erzählte, war nicht das, was Nelly erwartet hatte.
Die Kleider gehörten Andreas. Er zog sie heimlich an, weil er schon immer das Gefühl hatte, im falschen Körper geboren zu sein. Als Kind vergriff er sich an den Kleidern seiner Mutter. Als der Vater ihn dabei ertappte, bestrafte er Andreas und drohte mit dem Kinderheim.
Nelly von Aesch (54) ist heute mit Andrea (50) verheiratet, denn in den vergangenen 16 Jahren ist aus Andreas Schritt für Schritt eine Frau geworden.
«Muss ich jetzt lesbisch werden?» «Nur gerade jede fünfte Ehe bleibt nach einem Transgender Outing bestehen. Ich habe ein wahnsinniges Glück», sagt Andrea. Damals – 2001, als Nelly die Kleider entdeckt hatte –war Andreas Sorge gross, sie zu verlieren. «Nachdem ich sein Geheimnis gelüftet hatte, fragte ich mich: Muss ich jetzt lesbisch werden?», erinnert sich die Verkäuferin. Inzwischen denke sie längst nicht mehr in diesen Kategorien. Zumal Sex in ihrer Beziehung noch nie wirklich wichtig gewesen sei. «Wir haben uns gern und sind füreinander da. Das ist die Hauptsache.» Zudem sehe sie, wie gut es Andreas als Andrea gehe.
Lange Zeit existierte Andrea für Nelly nur in den gemeinsamen vier Wänden in Biezwil SO, einer 340 Seelen Gemeinde im Mittelland. Und auch das nur, wenn nicht gerade eines der vier Kinder aus Nellys früherer Ehe da war. Damals fürchteten sich beide vor den Reaktionen der Familie, der Nachbarn und überhaupt der Gesellschaft.
Andreas war ein richtiger Macho Für seine Mitmenschen war Andreas stets ein richtiger Mann: Er hatte eine tiefe Stimme, kräftige Oberarme und raspelkurze Haare. Auf Fotos von früher sieht man ihn oft betont raumfüllend und breitbeinig dasitzen. Beruflich war er als Carchauffeur tätig. Und auch sein Hobby, der Modellbau, war äusserst unverdächtig: «Ich hatte immer eine riesige Angst, dass mich jemand entlarven könnte», sagt Andrea, die mit einer hohen Stimme spricht, die leicht heiser klingt.
Im Frühling 2015 wagte sich Andreas erstmals als Andrea an ein Treffen von Transfrauen in Wangen BE und kam auf der Heimfahrt prompt in eine Polizeikontrolle: «Ich trug Perücke und war im Vergleich zu heute total schlecht geschminkt.» Der Polizist habe ihn dann aber wider Erwarten als Frau akzeptiert und sich absolut korrekt verhalten. «Das hat mir unglaublich viel Mut gemacht und sich wie ein Befreiungsschlag angefühlt.»
Seit eineinhalb Jahren nimmt Andreas weibliche Hormone und trainiert gemeinsam mit einer Logopädin seine Stimme. Im vergangenen Frühling weihte er seinen Chef ein und setzte sich zum ersten Mal als

Wie ein «normales» Ehepaar: Im Jahr 2000 heirateten Andreas und Nelly mit allem, was dazugehört: Brautstrauss, Oldtimer und grosser Gästeschar.
Andrea hinter das Steuer eines Reisecars. Und nach einem langwierigen administrativen Prozess erhielt Andreas Anfang Dezember 2017 neue Papiere und ist jetzt offiziell als Andrea anerkannt.
Im Mai wird Andrea den letzten Schritt auf dem Weg zur Frau machen: Sie wird sich am Universitätsspital Zürich einer geschlechtsanpassenden Operation unterziehen: «Das interessiert die Leute, besonders Männer, immer am meisten: Ist das Teil noch da oder schon weg?», sagt Andrea und lacht.
Es stört sie nicht, wenn Fragen gestellt werden, im Gegenteil: «Es gibt so viel Unwissenheit über Transsexualität. Viele denken, da geht es hauptsächlich um Sex, mit Netzstrümpfen und Highheels.» Darum sei ihr der Begriff Transidentität eigentlich lieber. Das beschreibe viel besser, was Sache sei: «Ich habe eine weibliche Seele, die jahrelang in einem männlichen Körper wohnen musste.»
Auf die Frage, ob sie Andreas denn nie vermisse, sagt Nelly mit brechender Stimme: «Machmal sehne ich mich nach dem starken Mann, dem Beschützer und Liebhaber.» Aber sie habe mit Andrea auch viel gewonnen: «Sie ist viel zärtlicher und feinfühliger als Andreas und beteiligt sich auch mehr an der Hausarbeit, weil sie nicht Macho spielen muss.» Trotzdem ist Nelly heute nicht mit einem komplett anderen Menschen verheiratet: «Der Kern, das Herz, ist immer noch dasselbe – wie zum Glück auch der Humor.» MM
www.andrea-vonaesch.ch

Wie ein «richtiger» Mann: Andreas von Aesch legte Wert darauf, dass niemand in seine Seele blicken konnte – so auch während des Apéros am Tag seiner Hochzeit mit Nelly.
SRF DOK
Andrea und Nelly am TV
Der «DOK»-Autor Béla Batthyany hat Andrea und Nelly ein Jahr lang begleitet. Entstanden ist ein feinfühliger Film, der zeigt, welche Herausforderungen Andreas auf dem Weg zu Andrea zu meistern hat: So ist die Kamera etwa bei der ersten Begegnung zwischen Andrea und ihrem Vater oder beim Comingout gegenüber dem Chef dabei. Wider Erwarten darf man immer wieder mal lachen – nicht zuletzt dank Andreas ausgeprägtem Sinn für Humor.
«Das Geschlecht der Seele»: Donnerstag, 25. Januar, 20:05–21:05 Uhr, SRF 1




Liebe Flussreise-Freunde
Es gibt viele grosse Momente auf dieser Flussreise. Wenn das Schiff im charmanten Wien oder beim prächtigen Budapester Parlamentsgebäude anlegt, wenn es die mächtige Kataraktstrecke erreicht oder ins Eiserne Tor einfährt. Dann, wenn alle Passagiere das vor ihnen liegende Donaudelta bestaunen. Diese unvergleichliche Tier- und Pflanzenwelt erleben Sie auf dieser Reise hautnah.
Unsere Reiseleiter sind Geschichtenerzähler und begeisterte


Botschafter dieser fantastischen Route durch acht Länder. Zu erzählen gibt es viel, denn jedes Land hat auf seine Art europäische Geschichte geschrieben.
Die Royal Emerald ist Ihr Donaudomizil, liebe Gäste. Geniessen Sie das Privileg, auf diesem 5-Sterne-Schiff auf exquisite Art von Erlebnis zu Erlebnis zu reisen – und das zu einem erstaunlichen Preis!
Erkunden Sie die Donau, diesen Fluss der seit jeher Völker und Kulturen wie kein anderer verbindet.
Herzliche Grüsse, Ihr
Stephan Frei Geschäftsleiter

Ihr Reiseprogramm
Tag 1 Schweiz > Passau. Busanreise nach Passau.
Tag 2 Wien. Servus in Wien! Stadtrundfahrt*. Abends klassisches Konzert (Fr. 75).
Tag 3 Budapest. Stadtrundfahrt* in Ungarns lebensfroher Hauptstadt.
Tag 4 Vukovar. Ausflug* in den Naturpark Kopacki rit.
Tag 5 Belgrad. Rundfahrt* durch die Hauptstadt Serbiens. Nachmittags Ausflug nach Topola und Oplenac (Fr. 35).
Tag 6 Passage Eisernes Tor. Die Royal Emerald passiert das Eiserne Tor.
Tag 7 Rousse. Hier erreicht die Donau eine Breite von 1,3 km. Stadtrundfahrt*.
Tag 8 St. Georgs-Kanal/Donaudelta > Tulcea. Passage Stromkilometer Null. Nachmittags Bootsfahrt* im Delta bis Meile 35.
Tag 9 Oltenita > (Bukarest) > Giurgiu. Überlandtour per Bus nach Bukarest und Stadtrundfahrt*.
Tag 10 Kreuzen in der Walachei. Tag an Bord. Durchfahrt der Kataraktstrecke.
Tag 11 Novi Sad. Stadtrundfahrt* in Novi Sad mit Kloster Krusedol.





Kein Zuschlag für Einzelbelegung Hauptdeck


Bus zum Fluss
Feinste Küche
Exklusive Landausflüge
Mittelthurgau-Reiseleitung
Tag 12 Fajsz > Ordas. Ausflug* Puszta mit Besuch einer Czarda mit Paprikamuseum.
Tag 13 Bratislava. Ausflug* nach Bratislava und Altstadtführung in der Hauptstadt der Slowakei.
Tag 14 Krems > Melk. Ausflug (Fr. 35) Wachau. Besuch Benediktinerstift* Melk.
Tag 15 Passau > Schweiz. Busrückreise.
*Ausflugspaket



Die Royal Emerald ist ein elegantes 5-Sterne Luxus-Flussschiff. An Bord erwartet Sie eine grossräumig-moderne Ambiance mit Panorama-Restaurant, Lounge/Bar, Bordshop, Foyer/Rezeption, Wellness-/Fitnessbereich, Sonnendeck mit Liegestühlen und Sitzgruppen, WiFi. Kabinen und Suiten mit Dusche/WC, individuell regulierbarer Klimaanlage, Safe, Minibar, Flachbild-TV, Internetzugang u.m., Suiten auf Mittel-/Oberdeck mit Privatbalkon. Vorzügliche Küche. Geniessen Sie frische, mit Sorgfalt zubereitete Menüs und Gerichte der feinen europäischen Küche. Frühstücksbuffet, Mittagessen, Nachmittagskaffee/-tee, Abendessen, Mitternachtssnack. Willkommen an Bord!
inkl. An-/Rückreise und Vollpension an Bord 15 Tage ab Fr.
Reisedaten 2018
27.05.-10.06, 10.06.-24.06. 19.08.-02.09. *, 09.09.-23.09. *
*Excellence Princess: Details und Preise unter www.mittelthurgau.ch/eppas1
Preise pro Person Fr. Kabinentyp Katalogpreis Sofortpreis
Hauptdeck
2-Bett-Kabine hinten (15 m²) 4145.– 2895.–
2-Bett-Kabine (15 m²) 4245.– 2995.–
Mitteldeck
Junior Suite hinten, Balkon (18 m²) 4845.– 3595.–Junior Suite, Balkon (18 m²) 5245.– 3995.–Suite, Balkon (23 m²) 6245.– 4995.–
Oberdeck
Junior Suite hinten, Balkon (18 m²) 5445.– 4195.–
Junior Suite, Balkon (18 m²) 5845.– 4595.–Suite, Balkon (23 m²) 6845.– 5595.–Grand Suite, Balkon (27 m²) 7245.– 5995.–Panorama Suite, Balkon (30 m²) 7545.– 6295.–
Sofortpreis mit beschränkter Verfügbarkeit
Zuschläge
• Alleinbenützung Kabine Hauptdeck 0.–
• Alleinbenützung Junior Suite (ohne Suite) 1895.–
Wählen Sie Ihre Ausflüge
• Ausflugspaket mit 11 Ausflügen 412.–Unsere Leistungen
• An-/Rückreise im Komfort-Reisebus
• Flussreise mit Vollpension an Bord
• Mittelthurgau-Reiseleitung
Nicht inbegriffen
• Auftragspauschale pro Person Fr. 20.–, bei Buchung über www.mittelthurgau.ch, Reduktion von Fr. 20.– pro Person
• Persönliche Auslagen, Getränke, Trinkgelder, Ausflüge
• Kombinierte Annullations- und Extrarückreiseversicherung auf Anfrage
• Sitzplatz-Reservation Car 1.–3. Reihe
Was Sie noch wissen müssen
Schweizer Bürger benötigen eine gültige Identitätskarte oder einen gültigen Reisepass.
Wählen Sie Ihren Abreiseort
06:30 Burgdorf • 06:35 Basel SBB
06:50 Pratteln, Aquabasilea • 07:00 Aarau SBB
08:00 Baden-Rütihof •
08:30 Zürich-Flughafen, Reisebusterminal •
08:55 Winterthur-Wiesendangen SBB
09:15 Wil •
Apelabs
VR-Spiele im Video: www.migmag. ch/apelab
22 MM4, 22.1.2018 | MENSCHEN
Emily und Sylvain Joly tüfteln an der Unterhaltungswelt der Zukunft. Mit ihrer Firma Apelab kreieren sie in Genf Spiele und Filme für Smartphones und VR-Brillen und wurden damit ans Sundance Festival in den USA eingeladen. Ihr neuestes Werk präsentieren sie diese Woche an den Solothurner Filmtagen.
Text: Ralf Kaminski Bild: Olivier Vogelsang
Ein Paar sind sie schon seit zwölf Jahren, der Comicfan und die Filmspezialistin. Zusammen studierten Sylvain und Emily Joly Kunst und Design an der Universität Genf, zusammen entdeckten sie die Nische, interaktive Geschichten für das Smartphone und in der virtuellen Realität (VR) zu erzählen. 2014 kombinierten sie ihre Passionen mit denen zweier Studienkollegen und gründeten ihre eigene Firma Apelab, «Affenlabor».
Geht das gut, so pausenlos zusammen zu sein, privat und im Job? Die zwei schauen sich kurz an und lachen. «Wir haben uns daran gewöhnt und sind einfach ein gutes Team», sagt Emily Joly. Mit einer Leidenschaft für Technologie und Geschichten, die offensichtlich zusammenschweisst.
Ihr neuestes Spiel heisst «Ko’Ko’s Curse». Alles, was es dafür braucht, ist ein modernes Smartphone mit Kopfhörern – und schon steht da mitten im eigenen Wohnzimmer ein kahler, hohler Baum, in dem niedliche kleine Eulen sitzen und einen mit grossen Augen ansehen. Das Verfahren heisst «Augmented Reality» (AR), also erweiterte Realität. Wo eigentlich nur ein Parkettboden mit Sofa ist, ergänzt der Smartphonebildschirm die Wirklichkeit, indem er Pflanzen und Tiere einblendet, mit denen man in den eigenen vier Wänden interagieren kann. Diese AR Spiele gelten seit dem «Pokémon Go»
Massenphänomen im Sommer 2016 als Unterhaltung mit Potenzial.
Damals jagten auf der ganzen Welt Zigtausende mehr oder weniger junge Spieler mit ihren Smartphones nach Pokémons, kleinen japanischen Animationskreaturen, die es zu fangen galt und die irgendwo in der eigenen Umgebung sitzen konnten, auf einem Baum, am Flussufer, im Imbiss um die Ecke – zu sehen natürlich nur via Smartphone und mit der entsprechenden App.
Pioniere auch auf internationaler Ebene Das gleiche Verfahren nutzt auch «Ko’Ko’s Curse», das Apelab in Coproduktion mit RTS Digial Lab & SRG SSR entwickelt hat und diese Woche an den Solothurner Filmtagen vorstellen wird. Dort setzt man sich unter dem Titel «Future Lab» erstmals intensiver mit dem Potenzial von AR und VR auseinander und wie sich das aufs Filmemachen auswirkt. Auch wenn die Interaktivität dieser Verfahren sich eher für Spiele eignet als für den klassischen Kinofilm. «Future Lab» wird unter anderem vom MigrosKulturprozent unterstützt (siehe Kasten rechts). Neben weiteren AR/VRSpielen wird man auch «Ko’Ko’s Curse» ausprobieren können, spätestens Anfang März soll die App fürs allgemeine Publikum zum Download zur Verfügung stehen. Die Entwicklung des Spiels dauerte rund fünf

Monate, erzählt Emilie Joly, «doch als wir uns zu Beginn auf AR und VR spezialisieren wollten, hatten wir erst mal ein Problem: Die Technik zur Entwicklung qualitativ hochwertiger Spiele in diesem Bereich existierte schlicht noch nicht».
So programmierten sie einfach selbst eine Plattform, SpatialStories, die ihnen auf einen Schlag internationale Aufmerksamkeit bescherte. Sie wird heute von den meisten GameDesignern verwendet, die ARoder VR Geschichten erzählen möchten. Den nächsten Erfolg feierten die Jolys und ihr sechsköpfiges Team mit dem Pilotfilm zu ihrer interaktiven VR Serie «Sequenced». Nicht nur räumten sie damit an diversen Festivals Preise ab, die Schweizer Pioniere wurden 2016 sogar an die renommierten Filmfestivals Sundance und Toronto eingeladen, was sie zum Netzwerken nutzten. Schon 2015 er

öffneten sie ein zweites Büro in Los Angeles, und im Lauf des Jahres wird das Paar auch selbst in die USA übersiedeln. «Wenn Trump uns reinlässt», scherzt Emily Joly und rollt mit den Augen.
Der Standort in Genf wird aber für die technische Entwicklung erhalten bleiben. «Die Schweiz ist ein fruchtbarer Boden für gute Talente», sagt Joly. Doch was die Unterhaltungsindustrie angeht, spiele die Musik in den USA, auch die Finanzierung neuer Projekte lasse sich dort leichter realisieren. Weil der Markt für diese interaktiven virtuellen Welten noch relativ klein ist, hält sich die Konkurrenz in Grenzen. «Wir sind viel unterwegs an Festivals und treffen überall auf dieselben paar Leute», sagt Emilie Joly und lacht. 2018 allerdings könnte entscheidend werden: Laut dem Beratungsunternehmen Deloitte wird es das Jahr sein,
in dem AR seinen Durchbruch erlebt, weil weltweit inzwischen rund 800 Millionen AR-fähige Smartphones im Umlauf sind. Deloitte erwartet für 2018 einen Umsatz von 100 Millionen Dollar im AR-Bereich. «Das Potenzial ist enorm», glauben auch die Jolys. Und mit ihrer Vorarbeit rechnen sie sich gute Chancen aus, im neuen Unterhaltungszeitalter vorne mit dabei zu sein. «Es sind derzeit viele Geräte in Entwicklung, die AR und VR leichter zugänglich machen werden», sagt Emily Joly. «Und wir liefern die Inhalte für sie.» Werden wir uns bald alle in täuschend echt wirkenden virtuellen Welten bewegen können? Die Jolys sind überzeugt, dass das nicht mehr lange dauern wird. Und die Vorfreude darauf ist ihnen deutlich anzusehen. MM
Infos: www.apelab.ch, www.solothurnerfilmtage.ch
Migros-Kulturprozent
Filme mit neuer Technologie
Die neuen digitalen audiovisuellen Technologien fordern die klassischen Grenzen des Erzählens, der Filmproduktion und des Vertriebs heraus. Das MigrosKulturprozent fördert deshalb transmediale Filmprojekte und Formate wie das «Future Lab» an den Solothurner Filmtagen, die neue Perspektiven einnehmen und Impulse setzen für die Weiterentwicklung des Films. Unterstützt werden zum Beispiel Filmprojekte im digitalen Bereich wie Virtual Reality und Video on Demand, aber auch Onlinefestivals.
Weitere Infos: www.migroskulturprozent.ch/filmfoerderung











Grether’s Blackcurrant Pastillen ohne Zucker, im Nachfüllbeutel, 100 g, gültig bis 5.2.2018 5.80 statt 7.30







Linsoft- und Tempo-Taschensowie -Kosmetiktücher z.B. Linsoft Kosmetiktücher im 3er-Pack, 4.55 statt 5.70, gültig bis 5.2.2018
Bei allen Angeboten sind bereits reduzierte Artikel ausgenommen.







Gesamtes Klostergarten Tee-Sortiment ab 2 Stück, 20% günstiger 20% ab 2 Stück

Leserforum
MM3: Exorzismus Im Kampf gegen Dämonen
«Das hat weniger mit Dämonen zu tun, sondern mit dem alltäglichen Druck»

Der Heilsarmeeoffizier Beat Schulthess im Element: Dämonenbekämpfung bei Renate
Wir leben in einer Zeit, in der unsere schwächeren Mitmenschen zerbrechen. Das hat aber weniger mit dem Leibhaftigen oder mit Dämonen zu tun, sondern eher mit dem alltäglichen Druck, beruflich und privat. Den Opfern, die durch diese Mühle gegangen sind und psychisch verletzt wurden, muss geholfen werden –professionell, durch eine Fachperson mit fundierter psychologischer und psychiatrischer Ausbildung.
Patrick Brun, via www.migrosmagazin.ch
Mein Kommentar zu diesem unglaublichen Bericht: 39 Teufel, also eine wahre «Dämonengang», haben es sich angeblich im Innern von Frau Renate T. bequem gemacht. Dank exorzistischem Know-how gelang es, das gesamte Lumpenpack auszuquartieren, jedoch kehrten kurz darauf drei dieser Gestalten zurück, von denen wiederum zwei in die Flucht geschlagen werden konnten. Dann wars nur noch einer. Der sträubte sich jedoch hartnäckig, seine kuschelige Behausung zu verlassen. Mein bescheidener Ratschlag: Wenn alle Stricke reissen oder wenn sowohl Engel als auch Heilige nicht helfen können, wenn Gebete unerhört verhallen, wenn der Exorzist vergebens droht, ja, gar wüst flucht, dann hilft wohl nur noch ein kräftiger Windstoss, vulgo: Furz, und der Teufel wird in hohem Bogen aus dem Innern des gequälten Körpers katapultiert. Wo das satanische Wesen schliesslich landet, ist dann wiederum ein anderes Problem. Isabelle Brehmer, Zürich
Herzliche Gratulation zu diesem Artikel! Ein heisses Thema, neutral formuliert und mit ver-
schiedenen Stimmen eingebracht. Beat Schulthess lehrt uns mit seiner ehrlichen Art, wie wir mit verstandesmässig unerklärlichen Dingen umgehen sollten: offen, lernend und hörend.
Daniela Bär, Winterthur ZH
Seit über 30 Jahren beschäftige ich mich mit Themen der Grenzwissenschaft. Wüsste man besser Bescheid über die unsichtbaren Wirklichkeiten, könnte Leid gemildert werden. Herzlichen Dank der Redaktion und auch der Heilsarmee mit Beat Schulthess. Super! Fredy Frischknecht, via www.migrosmagazin.ch
Seit Hunderten von Jahren wird das Thema der Dämonenaustreibung immer wieder neu entflammt und hochgehalten. Die Urheber sind in der Regel Kirchen, kirchennahe Vereine und Sekten aller Couleur, die hierbei die thematische Unwissenheit, die Leichtgläubigkeit und die tiefsitzenden Ängste des Menschen ausnutzen. Wer in dieser Hinsicht der Jahrtausende währenden Unwissenheit und Leichtgläubigkeit des Menschen endlich entgegentreten
will, wählt Informationsquellen, die eben nicht einseitig sind, sprich: von bestimmten Kirchen, kirchennahen Vereinen oder Sekten geprägt und kolportiert werden, sondern solche, die seit Menschengedenken universal in allen Kulturen Anwendung finden. Namentlich ist hier die okkulte Weisheitslehre, die Theosophie, zu benennen. Frank Henkel, via www.migrosmagazin.ch
MM3: Hormonelle Verhütung Schluss mit der Pille!

Elf Frauen haben ihre Erfahrungen mit Verhütung geschildert.
Danke für diesen Bericht! Eigentlich ist bereits seit Jahren bekannt, dass viele Frauen mit der Pille Mühe bekunden. Leider lassen wir uns von der «sicheren» Schwangerschaftsverhütung und den teilweise «positiven» Nebenwirkungen noch immer steuern. Die Männer schätzen es. Schade ist, dass vermittelt wird, Frauen könnten die Situation eventuell nicht richtig beurteilen. Wenn eine Ärztin oder ein Arzt das sagt, gibt es doch viele Menschen, die es glauben ... Ich wünsche mir, dass Ärzte ihre Patientinnen ernst nehmen und sie auf dem Weg zur Lösung des Problems unterstützen. Wer möchte nicht wahr- und ernstgenommen werden? Der wichtigste Punkt zur Veränderung scheint mir aber bei uns Frauen zu liegen: Wenn wir denken, die Pille habe unschöne Nebenwirkungen, dann ist das so. Punkt. Erst wenn die Pille nicht mehr gekauft wird, wird die Industrie nach neuen Produkten forschen. Es liegt bei uns Frauen, die Einschränkungen so konsequent wie die Männer abzulehnen.
Natalie Getzmann, via www.migrosmagazin.ch
24 Qualitäts-Magazine und -Zeitungen stehen Ihnen mit einem Preisvorteil von bis zu 83% zur Auswahl.
Zusätzlich schenken wir Ihnen zu jeder
Bestellung einen Migros-Einkaufsgutschein im Wert von 10 Franken !
























8x nur 39.–



Schweizer LandLiebe Weckt Lust aufs Land.


4x nur 20.–

4x nur 20.–







3x nur 19.90
Katzen-Magazin Für Katzenliebhaber.






6x nur 29.90
LE MENU So kocht die Schweiz.








10x nur 20.–



SonntagsZeitung Einfach mal geniessen.


Erscheint 2-monatlich



auto motor und sport Wissenswertes über Neuheiten.










JA, ich bestelle und spare bis zu 83 %
Schweizer LandLiebe 8x nur Fr. 39.–
Katzen-Magazin 4x nur Fr. 20.−
Erscheint monatlich
Lustiges Taschenbuch 3x nur Fr. 19.90
Wir Eltern 4x nur 20.−
Kochen 4x nur Fr. 20.–
GlücksPost Super-Rätsel 11x nur Fr. 29.–
LE MENU 4x nur Fr. 20.–
Erscheint 14-täglich
auto motor und sport 6x nur 29.90
Brigitte 9x nur 29.90
freundin 7x nur Fr. 19.90
TV-Star 13x nur Fr. 39.–
Beobachter 13x nur Fr. 49.–


Lustiges Taschenbuch Lesespass für Jung und Alt.


9x nur 29.90



Brigitte Für anspruchsvolle Frauen.







13x nur 29.–



GlücksPost Unterhaltsam & nützlich.


Erscheint wöchentlich
Tierwelt 12x nur Fr. 25.–
STERN 16x nur Fr. 19.90
Bunte 13x nur Fr. 29.90
Gala 13x nur 29.90
TELE 13x nur 39.−
SonntagsBlick 13x nur Fr. 29.−
SonntagsZeitung 10x nur Fr. 20.−
Schweizer Familie 8x nur Fr. 20.–
GlücksPost 13x nur 29.–
Schweizer Illustrierte 13x nur Fr. 39.−
Erscheint täglich Mo. bis Sa.
Tages-Anzeiger 30x nur 20.–
Blick 50x nur 35.–
Die Teilnahme an der Verlosung ist unabhängig von der Bestellung. Über die Ziehung wird keine Korrespondenz geführt. Der Rechtsweg ist ausgeschlossen. Der Jahres wettbewerb von Qualitätstitel Schweiz kann auch von weiteren Partner-Unternehmungen mitgetragen werden.


Wir Eltern Für Mütter und Väter. 4x nur 20.–


7x nur 19.90
4x nur 20.–



freundin Informiert und inspiriert.






13x nur 39.–



Schweizer Illustrierte Das People-Magazin.


Frau Herr
Name / Vorname
Strasse / Nr.
PLZ / Ort
Telefon
Unterschrift




Kochen – Geniessen mit Annemarie Wildeisen.


11x nur 29.–





GlücksPost Super-Rätsel Das kurzweilige Super-Rätselheft.

13x nur 39.–




TV-Star Schweizer Fernseh-Stars.














nur





13x nur 29.–



SonntagsBlick Keiner bringt’s wie wir.




Bitte senden Sie mir das / die angekreuzte(n) Kennenlern-Abo(s) und einen Migros-Einkaufsgutschein im Wert von Fr. 10.−.
Ich bestätige, dass ich noch nicht AbonnentIn der bestellten Zeitschrift(en) bin. Ich nehme nur an der Verlosung teil.
Diese Angebote finden Sie auch auf
Die Angebote gelten nur in der Schweiz bis 14. Dezember 2018! Einsenden an: Qualitätstitel, Postfach 1693, 8048 Zürich
Im Artikel wird mehrmals die Temperaturmethode erwähnt. Sie ist jedoch unsicher, weil dabei lediglich die Körpertemperatur beobachtet wird. Bedeutend sicherer – mit der Pille absolut vergleichbar – ist die symptothermale Methode, die nicht nur auf der Messung der Aufwachtemperatur, sondern zusätzlich auf dem Beobachten des Zervixschleims beruht. Man kann sich das Wissen entweder im Selbststudium anhand des Buchs «Natürliche Empfängnisregelung» von Prof. Dr. Rötzer aneignen oder in einem Kurs erlernen (www.iner.org), sodass gleich auch alle wichtigen Fragen geklärt werden können. Verhütungscomputer beruhen häufig auch nur auf der Temperaturmessung und sind daher
«Es macht richtig Freude, meinen
Körper so gut zu kennen»
eher dazu geeignet, eine Schwangerschaft anzustreben (Bestimmen der fruchtbaren Tage), statt sie zu vermeiden (Bestimmen der unfruchtbaren Tage). Wir sind selber total begeistert von der Methode und wenden sie seit Beginn absolut erfolgreich an. Es macht richtig Freude, meinen Körper so gut zu kennen und auch meinen Partner daran teilhaben zu lassen.
Larissa Sameli, via www.migrosmagazin.ch
Der Artikel hat mich sehr angesprochen. Schade bloss, dass nur die eine Meinung einer schulmedizinisch arbeitenden Gynäkologin abgedruckt wurde. Die Komplementärmedizin hat zu Themen wie Menstruationsbeschwerden, Hautproblemen oder Stimmungsschwankungen ein breites Repertoire in verschiedenen Methoden (Homöopathie, Akupunktur, Kräuterheilkunde etc.) anzubieten. Es wäre schön, wenn so viele Frauen wie möglich wüssten, dass sie aus einer grossen naturheilkundlichen Palette Hilfe erhalten gegen ihre Beschwerden.
Sandra De Martin, Laax GR
Als junges Mädchen wechselte ich ein paar Mal die Gynäkologen. Und alle gaben mir das Re
zept für die Pille – teilweise sogar ohne jegliche Untersuchung oder sonstige Abklärungen! Als ich mit 41 schwanger wurde, erlitt ich eine Thrombose im rechten Auge. Ein Test ergab, dass ich das «FaktorVLeiden» (APCResistenz) habe. Rückblickend hätte ich damit gar nie hormonell verhüten dürfen!
Liliane Rusterholz Allenspach, Zürich
Schicken Sie Ihre Leserbriefe an: Redaktion Migros-Magazin, Limmatstrasse 152, Postfach 1766, 8031 Zürich, oder per E-Mail an: redaktion@migrosmagazin.ch Die Redaktion behält sich Kürzungen vor und übernimmt keine Verantwortung für Inhalt und Richtigkeit der Aussagen. Über Erscheinen resp. Nichterscheinen der Leserbriefe wird keine zusätzliche Korrespondenz geführt.
Anzeige

















Alle Zoé Produkte (ohne Zoé Sun), z.B. Revital Straffende Tagescreme, 50 ml, 10.05 statt 13.50, gültig bis 5.2.2018
Bei diesem Angebot sind bereits reduzierte Artikel ausgenommen.




20–50% auf alle Schneesporthelme

119.–
statt 199.–Schneesporthelm Union
Gr. 52–55.5/55.5–59/59–62.5 cm

89.90
statt 129.–Schneesporthelm Hacker
Gr. 53–56/56–59/59–62 cm
199.20
statt 249.–Schneesporthelm Seam
Gr. 52–55.5/55.5–59/59–62.5 cm

* inkl. Touren- und Langlaufski
** nur in ausgewählten Filialen
Alle Angebote sind gültig von 23.1. bis 5.2.2018, solange Vorrat.


279.–
statt 399.–All Mountain Snowboard Play**
inkl. Bindung Sky Längen: 151/156/159/162 cm
349.–
statt 499.–All Mountain Snowboard Cinema**
inkl. Bindung Rambler Längen: 152/155/159 cm 30% 30%


379.–
statt 549.–
30%
Woman All Mountain Ski Astra
inkl. Bindung Lithium 10
Längen: 147/154/161 cm
20–50% auf alle Ski- und Snowboardsets*
389.–
statt 789.–On Piste
Ski WC Rebels XR
inkl. Bindung PRD 12
50%
Längen: 165/170/175/180 cm
40%
339.–
statt 579.–
Woman All Mountain
Ski Cloud X77
inkl. Bindung Lithium 10
Längen: 148/154/160 cm
30%
239.–
statt 349.–
All Mountain
Ski Instinct AR
inkl. Bindung PR 10
Längen: 149/156/163/170 cm
629.–
statt 789.–On Piste
20%
Ski i.Supershape Magnum
inkl. Bindung PRD 12
Längen: 156/163/170/177 cm
Roman Camenzind
Roman Camenzind ist der erfolgreichste Popmusikproduzent der Schweiz. Mit seiner Firma Hitmill bringt er immer wieder Hitparadenstürmer auf den Markt. Ein Gespräch über die Anfänge mit der Band Subzonic, harte Kritiker und seine Vorliebe für die Schweizer Mundart.
Text: Ralf Kaminski, Dinah Leuenberger Bilder: Dan Cermak


«Ich weiss, wie sich Pop anfühlt»: Musikproduzent Roman Camenzind


8 unvergessliche Reisetage Fr.1’195.–
1 Tag Schweiz – Reims Abwechslungsreiche Fahrt durch das Elsass in die Champagne
2 Tag Reims – Windsor – Newbury Von Calais aus bringt Sie ein Fährschiff über den Är melkanal nach Dover In W indsor, das sich im Ker n noch heute im malerischen mittelalterlichen Kleid zeigt, machen Sie Halt Die kleine Stadt wird von seinem Schloss beherrscht, das seit über 900 Jahren als Sommerresidenz der königlichen Familie dient
3 Tag Newbury – Stonehenge – Exeter –Dartmoor – Plymouth
Fahrt durch W iltshire nach Stonehenge Sie besuchen die weltberühmten Steinkreise Nach einer abwechslungsreichen Fahrt durch die sanfte Hügellandschaft von

Somerset und Devon gelangen Sie nach Exeter, dessen Altstadt von der mächtigen Kathedrale beherrscht wird Am Nachmittag durchqueren Sie den DartmoorNationalpark, einen legendenumwobenen, geschichtsträchtigen Landstrich und erreichen dann Plymouth
4. Tag Cor nwall – Land's End (fakultativ)
Dank seiner bizarren Naturschönheiten und romantischen Fischerdörfer, der zahlreichen Mythen und Folk-

Reisedaten 2018
03 – 10 Juni
17 – 24 Juni
29 Juli – 05 August

lore ist Cor nwall eines der beliebtesten Feriengebiete Grossbritanniens
Während der abwechslungsreichen Fahrt machen
Sie Halt bei der
Gezeiteninsel St Michael's Mount und besuchen dann Land's End, den westlichsten Punkt des englischen Festlands, wo die bizarren Granitfelsen der 60 Meter hohen Steilküste ins tosende Meer abstürzen Am Nachmittag fahren Sie weiter nach St Ives mit seinem malerischen Hafen und den char manten Gässchen
5 Tag Plymouth – Mount Edgcumbe
Sie unternehmen einen Bootsausflug, der Sie durch die Hafenanlagen und dann zum alten Herrensitz der Earls of Mount Edgcumbe führt Das Herrenhaus liegt in einem farbenprächtigen Park
6 Tag Plymouth – Tintagel – Clovelly – Reading Am Vor mittag besuchen Sie Tintagel, bekannt durch die Sagen um König Artus und den Gral Es ist wohl das berühmteste Dorf in Cor nwall Gegen Mittag treffen Sie dann in Clovelly ein Das gesamte Fischerdorf ist unter Denkmalschutz gestellt und liegt auf einem steilen Kamm, der fast senkrecht ins Meer abfällt Am Nachmittag Weiterreise durch Devon nach Reading
7. Tag Reading – Reims
Durch die Grafschaft Kent erreichen Sie wiederum Dover, von wo Sie ein Fährschiff zurück auf das europäische Festland bringt
8. Tag Reims – Schweiz
Über Nancy und die Vogesen kehren Sie bei Basel in die Schweiz zurück

Das ist alles dabei...

• 8-tägige Fahrt mit moder nem 4-Ster ne-Fer nreisecar mit Klimaanlage, Toilette etc
• 7 Über nachtungen in guten Mittelklassehotels in Zimmer n mit Bad oder Dusche/WC
• Fährüberfahrten mit moder nen Fährschiffen von Calais nach Dover und zurück
• Frühstücksbuffets und Nachtessen während der ganzen Reise in den Hotels
• Besichtigung des malerischen Küstenortes Clovelly
• Ausflug zum Herrensitz von Mount Edgcumbe inklusive Eintritt und Bootsüberfahrten
• Besichtigung der weltberühmten Steinkreise von Stonehenge
Auf Wunsch:
• Einzelzimmerzuschlag Fr 370 –
• Ganztägiger Ausflug durch Cor nwall und nach Land’s End Fr 48 –
• Annullationsschutz Fr 32 –
Abfahrtsorte
Zürich, Bern, Olten, Luzern, Basel

Roman Camenzind, wie entsteht ein Hit?
Ein Song wird durch das Publikum zum Hit. Er muss von einer breiten Masse von Leuten geliebt werden. Für einen Musikproduzenten gibts aber keine standardisierten Knöpfe, die er drücken kann, um das zu erreichen. Die Musik muss zur Art und zum Charakter des Künstlers passen, zu seiner persönlichen Geschichte, sie muss authentisch sein. Nur dann hat er eine Chance.
Sie erarbeiten also mit dem Künstler, was zu ihm passt? Das ist meine Herausforderung, genau. Ich führe zunächst lange Gespräche, um herauszufinden, wie er tickt, was ihn besonders macht, womit er sich abhebt. Darauf versuche ich aufzubauen.
Geben Sie uns ein Beispiel aus Ihrem Produzentenalltag?
Als Adrian Stern zu mir kam, brachte er Demos voller verzerrter Gitarrenklänge mit. Aber wenn man mit ihm spricht, merkt man sofort, dass er ein verträumter Romantiker ist. Ich sagte ihm, dass er nicht der Typ sei, zu dem verzerrte Gitarrentöne passen, sondern eher akustische Gitarre und romantische Texte. Er ging heim, überlegte sich das und kam drei Wochen später mit dem Song «Amerika». Das macht den Erfolg von Hitmill aus: Wir lernen jemanden erst mal gründlich kennen, bevor wir über die Musik sprechen.
Welche Elemente machen einen Hit aus? Wie viel davon ist musikalische Qualität, wie viel die Fähigkeit, den Mainstreamgeschmack zu treffen, wie viel Marketing, wie viel Glück? Das ist immer ein bisschen anders. Die Musik sollte zum Charakter passen, aber man muss auch noch den Zeitgeist treffen. Baschis «Bring en hei» wurde in dem Moment zum Hit, als ihn die Fans an der WM in Deutschland 2006 sangen.
Wie schwierig ist es, den Zeitgeist zu treffen? Ich selbst bin ein Popmusikfan, aus mir kann kein grossartiger

«Ein
Künstler muss authentisch sein, etwas Spezielles haben, eine Haltung vertreten, nur dann hat er eine Chance auf Erfolg.»
Jazz kommen, der steckt einfach nicht in mir. Aber ich weiss, wie sich Popmusik anfühlt. Da sie per se auf den Massengeschmack ausgerichtet ist, gelingt mir auch immer wieder ein Treffer.
Wie hat sich dieser Geschmack verändert, seit Sie mit Subzonic erfolgreich waren?
Der Mainstream verändert sich laufend, er ist ein Kondensat vieler Stilrichtungen, und er wird vom Feuilleton gern unterschätzt. In den vergangenen zehn Jahren war die elektronische Clubmusik wichtig – die war zu SubzonicZeiten noch eher exotisch. Der Mainstream ist heute auch fragmentierter als früher, weil das Publikum viel offener geworden ist. Früher gab es die MetalFans, die HipHopper, die Skater. Alle hörten ihre Musik und lehnten die anderen ab. Das gibts heute nicht mehr. Eins aber bleibt: Im Mainstream fassen immer nur die Besten und Talentiertesten Fuss.
Hitmill will Hits produzieren. Wie gut gelingt das? Es gelingt nicht immer, aber unsere Erfolgsquote ist sehr hoch. Mit sieben Nummer1Hits in der Schweiz liegen wir mit deutlichem Abstand an der Spitze.
Wie wählen Sie die Künstler oder Bands für Hitmill aus?
Nach Talent: Kann jemand singen, hat er Charisma? Ist er
offen, über sich und seine Musik zu reden? Das merkt man alles relativ schnell. Wir kriegen natürlich viele Demos, aber wenn eine MetalBand einfach nur so klingt wie eine schlechte Kopie von AC/DC, dann muss ich es gar nicht erst versuchen. Jeden Tag kommen 3000 neue Songs raus – jeden Tag! Da fällt nur auf, wer etwas Originelles, etwas Eigenes mitbringt. Wer das tut, ist interessant für uns, den lernen wir gern kennen.
Wie viele schaffen das? Etwa einer von 100.
Was passiert, wenn der Erfolg ausbleibt? Versucht ihr, die Strategie zu ändern, oder kommt es zur Trennung? Wenn sich für den Künstler die Zusammenarbeit nicht lohnt, wird er gehen. Diesen Entscheid trifft dann er, völlig zu Recht.
Warum schaffen nicht mehr Schweizer Pophits den internationalen Durchbruch? Spontan fallen einem da nur Songs von DJ Bobo und Yello ein ... Die Anforderung, etwas Neues, Innovatives zu machen, ist auf internationaler Ebene noch höher. Eine Schweizer Band wird immer weniger SexAppeal haben als eine amerikanische oder englische, wir gelten einfach nicht als Künstlerland, wir bringen keine vergleichbare Historie mit. Hitmill hat gar nicht erst
versucht, einen internationalen Hit zu landen. Wir fokussieren auf die Schweiz, das ist der Markt, den wir kennen.
Sie produzieren viel in Mundart – eine weitere Hürde für den internationalen Markt? Auf jeden Fall. Trotzdem bin ich ein vehementer Verfechter von Mundart. 99 Prozent aller Schweizer Bands, die Englisch singen, sind schlecht – nur schon, weil sie sich auf Englisch weniger gut und treffend ausdrücken können. Und wenn ihnen ihre Message nicht wichtig ist, dann können sie genauso gut Panflöte spielen. Natürlich machen sie es aus rein kommerziellen Gründen, eben in der Hoffnung, international wahrgenommen zu werden. Dabei hätten sie in Mundart weitaus höhere Erfolgschancen in der Schweiz.
Muss man nicht Kompromisse machen, um der Masse zu gefallen? Ist es da nicht unabdingbar, Ecken und Kanten abzuschleifen?
Auf keinen Fall! Das ist das Dümmste, was man machen kann. Nochmals: Ein Künstler muss authentisch sein, etwas Spezielles haben, eine Haltung vertreten, nur dann hat er eine Chance auf Erfolg.
1992 haben Sie als 16-Jähriger mit einem Schulfreund Subzonic gegründet. In der Hoffnung, Hits zu landen, oder eher aus Spass?
Ziel war schon, grosse Konzerte machen zu können und Erfolg zu haben, diese Ambition war immer da. Aber so, wie wir damals geklungen haben, wäre es schon sehr vermessen gewesen, an die Hitparade zu denken. Trotzdem haben wir hart gearbeitet, viel geprobt – und das ganz ohne Alkohol oder Kiffen.
Hätten Sie sich damals eigentlich selbst unter die Fittiche genommen, aus heutiger Perspektive?
(Überlegt) Das kann ich echt nicht beantworten. Aber wenn ich mir heute die Demos anhöre, die wir an Plattenfirmen schickten, muss ich sagen, dass die Frau bei Sony Music, die uns da
Testaktion startet aufgrund grossen Erfolgs erneut mit 1000
Aktuelle Nachrichten auf dem Smartphone, die Aussicht auf das Bergpanorama oder das Kleingedruckte im Vertrag – unsere Augen leisten tägliche Höchstarbeit, wenn es darum geht, immer alles scharf zu sehen und zu erkennen. Doch im Lauf der Jahre wird dies immer schwieriger. Dies ist eine ganz normale Veränderung der Augenlinse, die im Alter zwischen 40 und 50 Jahren beginnt und – in unterschiedlichem Ausmass – jeden Menschen betrifft.
Immer beliebter werden daher Brillen mit Gleitsichtgläsern. So erspart man sich den ständigen Wechsel zur Lesebrille und hat immer eine optimale Sicht in die Nähe, Zwischendistanz und in die Ferne.
Beste Sicht in jeder Entfernung mit Gleitsichtbrillengläsern
• Minimaler Restreflex
• Verbesserte Kontraste
• Flüssigkeits- und staubabweisend
• Erhöhte Kratzfestigkeit
Testen Sie kostenlos das Premium-Gleitsichtglas mit der revolutionären
Beschichtung Crystal Nano+
9 VON 10 TESTERN SIND BEGEISTERT.


1000 TESTPLÄTZE: SIE MÖCHTEN MITMACHEN?



Testergebnis bisher: 9 von 10 Testern sind begeistert und möchten ihre Gleitsichtbrille nicht mehr zurückgeben
Aufgrund des grossen Erfolgs bietet McOptic erneut 1000 Interessierten die Möglichkeit, individuell angepasste Premium-Gleitsichtgläser im Alltag zu testen. Diesmal mit der weltweit ersten Glasentspiegelung ohne wahrnehmbaren Restreflex und somit dem Besten, was im Bereich der Gleitsicht-Technologie und der Entspiegelung erhältlich ist.
Für die individuelle Fertigung der Premium Pro HDz Gläser werden über 40’000 Mess p unkte nach Ihrem persönlichen Sehprofil berechnet und garantieren so den höchstmöglichen Sehkomfort für Gleitsicht-Einsteiger und -Umsteiger. Die maximalen Sichtbereiche sorgen für erhöhte Spontanver träglichkeit und ermöglichen schnelle Blickwechsel.
Erleben Sie selbst, wie sehr Gleitsichtgläser Ihr Leben erleichtern können. Sichern Sie sich für besten Sehkomfort bis zum 17.2.2018 einen der begehrten Testplätze bei McOptic.
1000 Testpersonen dürfen individuell angepasste Premium Pro HDz Gleitsichtgläser zwei Wochen unverbindlich im Alltag ausprobieren
Sie bezahlen in der Testphase nur die Brillenfassung (als Pfand). Falls Ihnen die Brille nicht zusagt, geben Sie uns diese einfach innerhalb von 14 Tagen zurück und wir erstatten Ihnen den kompletten Fassungspreis. Sind Sie als Tester vom Sehkomfort der innovativen Gleitsichtgläser überzeugt, können Sie Ihre Gleitsichtbrille zum Spezialpreis erwerben: Vom Kaufpreis werden Ihnen 180 Franken Testbonus abgezogen.
Vereinbaren Sie einen Termin bis 17. Februar 2018 in Ihrer McOptic Filiale und testen Sie individuell für Sie angefertigte Premium Pro HDz Gleitsichtgläser zwei Wochen kostenlos und unverbindlich in Ihrem Alltag.
Lassen Sie sich kompetent und persönlich beraten. Alle McOptic Filialen finden Sie unter mcoptic.ch/filialen
IHR PERSÖNLICHER GLEITSICHTTEST-
Wenn Sie von Ihren getesteten, individuell für Sie angefertigten Premium Pro HDz Gleitsichtgläsern überzeugt sind, können Sie diese direkt im Anschluss erwerben und mit diesem Gutschein 180 Franken sparen.
Einlösbar bei Anmeldung zum Test bis 17.2.2018. Gilt beim Kauf Ihrer individuell angefertigten Gleitsichtbrille mit Premium Pro HDz Gleit sichtgläsern. Nicht kumulierbar mit anderen Rabatten ausser dem Helsana-Joker. Keine Barauszahlung.
mals unter Vertrag nahm, reichlich Fantasie hatte, um darin Potenzial zu sehen. Ich bin ihr wirklich ewig dankbar dafür.
Subzonic landete dann ja Hits – wie viel haben Sie aus dieser Zeit gelernt für Ihre spätere Arbeit bei Hitmill? Ich habe sicher viel für mich und meine Arbeit gelernt, nicht zuletzt, dass ich mich im Studio wohler fühle als auf der Bühne, weil ich dort vielfältiger arbeiten kann – heute Hip-Hop, morgen Pop, das ist es, was mir Spass macht. Ich mag es nicht, mich zu wiederholen.
Gäbe es trotzdem eine Band, in der Sie mitspielen würden? (Überlegt) Duran Duran, aus Sentimentalitätsgründen. Und für mein Mami.
Böse Zungen behaupten, Popmusik zu machen, sei sehr einfach, weil sie so banal ist. Die Reduktion aufs Einfache ist geradezu die Definition von Popkunst. Das gut zu machen, ist alles andere als banal, sonst wäre es viel einfacher, Hits zu landen. Dann bräuchte es Hitmill nicht.
Konnten Sie von Subzonic leben oder erst mit Hitmill? Ich versuchte, ab Gründung von Hitmill 1997 von der Musik zu leben. Zuvor war ich Programmierer. Das Leben als Musiker war anfangs schwer: Ich lebte auf kleinem Fuss in einer WG, mit winzigem Schlafzimmerstudio.
Wann wurde es komfortabler? Baschis «Bring en hei» 2006 war ein Meilenstein, von da an waren wir auf dem Radar der Musik- und der Werbeindustrie.
Der Musikmarkt hat sich seither stark verändert. Wie hat sich das auf Ihre Arbeit ausgewirkt?
Die Umsätze der Musikindustrie sind in den vergangenen 15 Jahren um 80 Prozent eingebrochen, während gleichzeitig mehr Musik denn je konsumiert wird. Die Folge ist, dass Plattenfirmen weniger neue Bands produzieren, weil ihnen das Risiko zu hoch ist. Geld verdient man heute noch mit Konzerteinnahmen
und Streaming. Wir sind dazu übergegangen, auch die Aufgaben von Plattenfirmen zu übernehmen, bieten den Künstlern also einen Rundumservice. Und wir arbeiten stärker mit der Werbeindustrie zusammen. Zu Beginn kamen rund 30 Prozent der Einnahmen aus diesem Sektor, eine Zeit lang waren es 70, mittlerweile sind es 50 Prozent, weil es in der Musikindustrie durch das Streaming langsam wieder aufwärtsgeht.
Als Künstler ist man laufend Kritikern ausgesetzt. Wie lernt man, damit umzugehen? Es ist wohl auch eine Frage der persönlichen Reife, ob man Kritik zulassen kann. Früher habe ich sie sehr persönlich genommen und komplett abgeblockt. Später habe ich realisiert, dass es sich lohnen kann, Kritik ernst zu nehmen. Musikkritiker Bänz Friedli (Kolumnist des Migros-Magazins, Anm. d. Red.) zum Beispiel hat in den 90er-Jahren gegen Subzonic geschossen. Ich sah das so sehr als Angriff auf mich und die Band, dass ich gar nicht las, worum es eigentlich ging. Dabei hatte er im Kern recht: Er warf uns vor, dass wir in unseren Mundartsongs viele Worte verwendeten, die eigentlich Hochdeutsch sind und im Alltag so gar nicht gebraucht werden. Heute fällt mir das Gleiche bei anderen Künstlern auf, und es ärgert mich so wie ihn damals.
Sie sind mittlerweile dreifacher Vater – bleibt bei all der Arbeit genug Zeit für die Kinder?
Früher führte ich ein typisches Musikerleben: bis nachts um 4 Uhr im Studio, dann schlafen bis 11 Uhr. Das ist vorbei, seit wir Kinder haben. Inzwischen verbringe ich nur noch etwa einen Tag pro Woche im Studio. Dort kann man schlecht um 17 Uhr sagen: «Sorry, ich muss los», wenn die Band gerade so richtig in Schwung ist. Die Arbeit im Büro hingegen kann ich mir gut so einteilen, dass ich Zeit für die Familie habe. Ausserdem arbeitet meine Frau Teilzeit, und ihre Mutter wohnt bei uns in der Nähe und springt oft ein.
Wie musikalisch sind die Kinder? Gibt es schon Anzeichen, dass sie ihren Eltern nachfolgen könnten?
Sie sind alle sehr musikalisch. Beim Autofahren singen meine Frau und ich immer, da machen sie natürlich auch mit. Und zu Hause steht ein Klavier, dazu gibts einen Proberaum mit Schlagzeug und Gitarre, das nutzen die Kinder alles auch schon.
Und wenn später mal eins von den Kindern auch mit Musik sein Geld verdienen will, würden Sie das unterstützen?
Ich würde wohl dasselbe sagen wie meine Eltern: Sie sollen eine klassische Ausbildung machen und daneben mit Musik anfangen. So haben sie ein Sicherheitsnetz, auf das sie zurückgreifen können, falls es mit der Musik nicht klappt. MM
Anzeige
Roman Camenzind (42) und seine Geschäftspartner Fred Herrmann (41) und Georg Schlunegger (37) sind mit Hitmill die erfolgreichsten Popmusikproduzenten der Schweiz. Der frühere Gründer und Sänger der Band Subzonic produziert heute Stars wie Baschi und Adrian Stern sowie Bands wie Lovebugs und Pegasus. Innerhalb von 20 Jahren landete Hitmill sieben Nummer1-Hits. Camenzind ist mit der Musikerin Nikol verheiratet. Die beiden haben drei Kinder (3, 6 und 8 Jahre alt) und leben in Wettingen AG
Buch: Rainer Kuhn: «Hitmill – Ein Blick hinter die Kulissen der Schweizer Hitfabrik», Heller Druck & Verlag, 2017; bei www.exlibris.ch für Fr. 18.80

Jetzt Katalog 2018 bestellen!

1 Böhmische Rhapsodie Prag–Litoměřice–Mělnik–Prag 9 Tage ab Fr. 1390.–(Rabatt Fr. 300.– bereits abgezogen, HD hinten/vorne, VP)
1. Tag Zürich/St. Margrethen–Prag Ind. Anreise. Busfahrt nach Prag und Einschiffung. 2. Tag Prag–Nelahozeves–Litoměřice Fahrt auf der Moldau. Ausflug* Nelahozeves mit Besuch Geburtshaus Antonin Dvorák und Schloss. Fahrt auf der Grossen Elbe bis Litomeˇrˇice. Rundgang.* 3. Tag Sächsische Schweiz/Dresden Busausflug* in die Sächsische Schweiz und Dresden. Altstadtrundgang Dresden. Gäste, welche an Bord bleiben, können Litomeˇrˇice auf eigene Faust erkunden. 4. Tag Litoměřice–Mělnik Fahrt durch die «Böhmische Pforte». Ausflug* nach Meˇlnik mit Schlossbesichtigung inkl. Weinverkostung. Musikalische Unterhaltung an Bord. 5. Tag Mělnik (–Kutná Hora)–Podebrady Ausflug* nach Kutná Hora. Besichtigung Barbara Kirche und Silbermuseum. 6. Tag Podebrady–Nymburk–Hořin Busausflug* zum Pferdegestüt Kinsky. Besichtigung Bierbrauerei. Kapitänsdinner. 7. Tag Hořin–Prag Rundgang* Prag. Besuch + eines klassischen Konzerts. 8. Tag Prag Besichtigung* Prager Burg mit «Goldenem Gässchen». Freie Zeit. Abschieds-Cocktail und Abendessen. 9. Tag Prag–St. Margrethen/Zürich Ausschiffung nach dem Frühstück, Bustransfer zurück in die Schweiz. Individuelle Heimreise.
Reisedaten 2018 Es het solangs het Rabatt
28.04.–06.05. 300
14.05.–22.05. 300 07.06.–15.06. 300
15.06.–23.06. 300
23.06.–01.07. 300
12.08.–20.08. 300 20.08.–28.08. 300
05.09.–13.09. 300 13.09.–21.09. 300
28.08.–05.09.* 200
* Mit Mundharmonika Gruppe «Just for Fun» und «Hombi Harmonicas»

2 Moldau und Elbe mit Schi und Velo Prag–Litoměřice–Mělnik–Prag 8 Tage ab Fr. 990.–
(Rabatt Fr. 100.– bereits abgezogen, HD hinten/vorne, VP)
1. Tag Zürich/St. Margrethen–Prag Ind. Anreise. Busfahrt nach Prag und Einschiffung. 2. Tag Prag–Kralupy (ca. 27 km) Rundgang + Prager Altstadt. Velotour entlang der Moldau über Troja und Klecánky nach Kralupy.
3. Tag Kralupy–Nelahozeves–Mělnik–Litoměřice (ca. 28 km) Zweite Etappe nach Nelahozeves. Besuch + des Geburtshauses von A. Dvorák und des Renaissanceschlosses. Mit dem Velo via Veltruský Park bis Meˇlnik. Schifffahrt nach Litomeˇrˇice. 4. Tag Litoměřice Tag zur freien Verfügung. Rundgang. + Besichtigung per Velo der Gedenkstätte Theresienstadt oder Velotour in die Stadt Ustí (ca. 53 km).
5. Tag Litoměřice–Roudnice–Mlčechvosty (ca. 40 km) Velotour entlang der Elbe über Dobrín, Racˇice, Vlineˇves nach Meˇlnik. Rundgang + Velofahrt nach Mlcˇechvosty. 6. Tag Mlčechvosty–Prag (ca. 40 km) Mit dem Velo Fahrt via Nelahozeves, Kralupy, Vodochody, Drasty und Klecánky nach Prag. Nachmittags freie Zeit. 7. Tag Prag Besichtigung Prager Burg oder Spaziergang Altstädter Ring. Alternativ Velotour entlang der Moldau nach Zbraslav v.v. (ca. 30 km).
8. Tag Prag–St. Margrethen/Zürich Ausschiffung, Busrückfahrt in die Schweiz. Individuelle Heimreise.
Reisedaten 2018 Es het solangs het Rabatt
01.07.–08.07. 100
08.07.–15.07. 100 15.07.–22.07. 100 22.07.–29.07. 100 29.07.–05.08. 100 05.08.–12.08. 100
Wichtige Hinweise: Leihvelos an Bord, bei Buchung der Velos unbedingt Körpergrösse angeben, Velotouren sind individuell und nicht geführt, Velostrecken/Schwierigkeitsgrad: Mittlere Kondition erforderlich
Radfahrer

• Goldene Stadt Prag
• Per Velo abseits der Touristenpfade EshetsolangshetbisRabatt*Fr.300.–*AbhängigvonAuslastung, Saison,Wechselkurs


• Boutique-Schiff, familiäre Atmosphäre
MS Thurgau Florentinabbbb unter Thurgau Travel Management Mittelklasseschi mit Platz für 86 Gäste in 46 Kabinen. Alle Kabinen (2-Bettkabine ca. 10 m², Einzelkabine ca. 8 m²) liegen aussen und verfügen über Dusche/WC, Föhn, Safe, TV sowie regulierbare Lüftung mit zentral gesteuerter Heizung/Klimaanlage. Die im Design unserer Burma-Schi e gestalteten Kabinen haben auf dem Oberdeck französische Balkone und auf dem Hauptdeck nicht zu ö nende Fenster. Gutbürgerliche, nationale und internationale Speisen werden im Restaurant mit Bar serviert. Bequemen Aufenthalt bieten die kleine Lounge bei der Réception und der Panorama-Salon auf dem Oberdeck. Auf dem grossen Sonnendeck mit Stühlen und Liegen nden Sie Erholung und Entspannung. Gratis WLAN nach Verfügbarkeit. Nichtraucherschiff (Rauchen auf dem Sonnendeck erlaubt).
Preise p. P. in Fr. (vor Rabattabzug) 1 2 2-Bettkabine Hauptdeck hinten/vorne 1690 1090 2-Bettkabine Hauptdeck 1790 1190 1-Bettkabine Hauptdeck 1990 1390 2-Bettkabine Oberdeck, franz. Balkon 2190 1390 1-Bettkabine Oberdeck, franz. Balkon 2290 1590 Zuschlag Alleinbenutzung Hauptdeck 590 390 Zuschlag Alleinbenutzung Oberdeck 840 590 Miete 7-Gang Unisexvelo/E-Bike auf Anfrage
Leistungen: Kreuzfahrt inkl. Vollpension, Bustransfer Zürich/ St. Margrethen–Prag v.v. Weitere Details im Internet oder Hauptkatalog 2018 verlangen.
2-Bettkabine Oberdeck (ca. 10 m²) mit franz. Balkon

* Im Aus ugspaket (8 Aus üge Fr. 270.–) enthalten, vorab buchbar | + Fak. Aus ug nur an Bord buchbar | Programmänderungen vorbehalten
Neue Website – Online buchen und sparen www.thurgautravel.ch
Verlangen Sie Patrizia Dapra Gratis-Nr. 0800 626 550
Rathausstrasse 5 | 8570 Weinfelden, Tel. 071 626 55 00 | info@thurgautravel.ch
Aussergewöhnliche Reisen zu moderaten Preisen
Auf Galaxus.ch sind neu über eine Million Produkte verfügbar. Der Onlinehändler der Migros knackte die Millionengrenze dank 24 000 Produkten der Migros-Tochter Globus, die seit Januar online erhältlich sind.

Migros-Besitzer
Alex Schuppisser (60) Koch aus Weite SG «Mir gefällt die klare Ladenstruktur. Mein Lieblingsprodukt ist Sambal Badjuk, das hat genau die richtige Schärfe und ist ideal zum Nachwürzen. Ich stimme als Genossenschafter zudem regelmässig ab.»
Migros-Gruppe
Solides
Wachstum im Jahr 2017
Die MigrosGruppe erzielte 2017 einen Umsatz von 28 Milliarden Franken, ein Prozent mehr als im Vorjahr. Der Detailumsatz, der die Umsätze der Genossenschaften und der Handelsunternehmen beinhaltet, ist um 0,9 Prozent auf 23,48 Milliarden Franken gewachsen. Damit ist die Migros weiterhin die grösste Detailhändlerin des Landes.
Die Migros-Genossenschaften erreichten dabei einen Umsatz von 15,55 Milliarden Franken. Dies entspricht einem Rückgang von einem halben Prozent, der vor allem auf die durchschnittlichen Preissenkungen um 0,4 Prozent auf den MigrosSortimenten zurückzuführen ist. Produkte, die ein Label für Nachhaltigkeit, Regionalität oder Gesundheit tragen, sind weiterhin sehr gefragt. Sie steuern über 4 Milliarden Franken zum Umsatz bei, eine Steigerung um 3,6 Prozent.
Im Onlinehandel konnte die Migros ihre Position als Marktführerin weiter ausbauen. Hier erzielte sie einen Umsatzzuwachs von 5,1 Prozent auf 1,95 Milliarden Franken. Besonders erfreulich entwickelte sich Digitec Galaxus mit einem Umsatz von 834 Millionen Franken – ein Plus von 18,5 Prozent. Die MigrosTochter ist der grösste Onlinehändler der Schweiz.

In einem neuen OnlineTrickfilm widerlegt die Migros weit verbreitete
Mythen über Verpackungen. Ist die Umhüllung von Produkten stets eine unnötige Umweltbelastung? Ist konventioneller Kunststoff als Verpackungsmaterial besonders unökologisch? Und ist Biokunststoff die Alternative dazu? Der Film erklärt kurzweilig, warum die Antwort auf alle drei
Fragen «nein» lautet, und zeigt, warum das Gewicht einer Verpackung für deren Umweltbilanz meist entscheidender ist als das Verpackungsmaterial. Und er geht auf ein ehrgeiziges GenerationMVersprechen ein: Bis 2020 will die Migros insgesamt 6000 Tonnen Verpackungsmaterial ökologisch optimieren.
Sehen Sie den Film auf www.generationm.ch/ verpackungsmythen

6000 Tonnen Verpackungsmaterial will die Migros bis 2020 ökologisch optimieren.
Infolge der 2016 eingeführten Gebühr von 5 Rappen für die Plastiksäckchen an den Kassen, ist es der Migros gelungen, deren Verbrauch um 84 % Prozent zu reduzieren. Den Gewinn aus dem Verkauf dieser Einwegplastiksäckchen spendet die Migros vollumfänglich. Der Erlös aus dem zweiten Halbjahr 2017 über 250 000 Franken kam vier Organisationen aus dem Bereich Lebensmittelspenden zugute: «Schweizer Tafel» und «Tischlein deck dich», «Partage» und «Tables du Rhône». «Diese Organisationen, mit denen wir seit Jahren erfolgreich kooperieren, leisten sehr wertvolle Arbeit», sagt Christine WiederkehrLuther, Leiterin der Abteilung Umwelt bei der Migros. Hier abstimmen, wohin der Erlös aus den Plastiksäckchen 2018 fliessen soll: www.migros.ch/mitbestimmen

Nicole Zeller konnte ihr Glück anfänglich kaum fassen: Die 35jährige Hausfrau aus Gelterkinden BL ist Gewinnerin eines MigrosJahreseinkaufsGutscheins im Wert von 5200 Franken. Die Mutter zweier Söhne im Alter von 17 und 18 Jahren hatte letztes Jahr an einem Wettbewerb teilgenommen, den die MigrosGesundheitsplattform «iMpuls» anlässlich des ersten Schweizer Digitaltags ausschrieb.
«Weil unsere finanziellen Mittel sonst knapp sind, ist der Gutschein für mich ein Geschenk Gottes», meint die Gewinnerin. «Es ist schön, meinen beiden Söhnen auch mal einen Wunsch erfüllen zu können. Ich werde das Geld ausserdem nutzen, um gesunde Produkte einzukaufen, und mir vielleicht einen neuen Staubsauger leisten.»
Infos zu «iMpuls»: www.migrosimpuls.ch

Migros-Weihnachtsaktion In der Vorweihnachtszeit haben Migros-Kundinnen und -Kunden ein Zeichen der Solidarität gesetzt: Durch den Kauf von Schokoladenherzen spendeten sie Geld für bedürftige Menschen in der Schweiz. So kam ein Betrag von 2,245 Millionen Franken zusammen, den die Migros um eine weitere Million erhöhte. Die gesamte Summe von 3,245 Millionen Franken geht zu gleichen Teilen an die Hilfswerke Caritas, Heks, Pro Senectute, Pro Juventute und Winterhilfe. Das Geld ist für ausgewählte Hilfsprojekte bestimmt, mit denen Not in unserem Land gelindert wird. Migros-Chef Fabrice Zumbrunnen meint dazu: «Die diesjährige Weihnachtsaktion, unterstützt durch unseren TV-Spot mit Wichtel Finn, hat viele Kunden berührt. Ihnen allen möchte ich auch im Namen der Hilfsorganisationen herzlich danken.»
Fitness
Aus Silhouette wird Activ Fitness
Im Mai 2017 hat die Activ Fitness AG, ein Tochterunternehmen der Migros Zürich, die Silhouette Wellness SA übernommen.
Ab 1. Juli werden deren 22 Studios unter dem Namen Activ Fitness geführt. Bereits ab 1. Februar profitieren die Kunden von Silhouette von den günstigen Preisen von Activ Fitness. Das Jahresabo kostet 740 Franken, Studenten und AHV/IV-Bezüger zahlen 640 Franken. Ab 1. Juli haben alle Mitglieder Zutritt zu den 62 Standorten von Activ Fitness.


Blickfang
«Echte Schokolade wäre am Whitehaven Beach auf den australischen Whitsunday Islands wohl geschmolzen, aber das Strandtuch hat seinen Dienst perfekt erfüllt.»
Freuen sich über den Erfolg der Spendenaktion: Samuel Schmid, Präsident Winterhilfe; Katja Wiesendanger, Direktorin Pro Juventute; Eveline Widmer-Schlumpf, Präsidentin Pro Senectute; Hansueli Siber, Leiter Departement Marketing MGB; Migros-Chef Fabrice Zumbrunnen; Peter Merz, Direktor Heks; Werner Schärer, Direktor Pro Senectute; Hugo Fasel, Direktor Caritas (von links).
Schicken Sie uns Ihr Migros-Bild und gewinnen Sie einen Einkaufsgutschein im Wert von 50 Franken. Wenn auf Ihrem Foto ein Migros-Zusammenhang zu erkennen ist, sind Sie dabei. Hochladen: www. migmag.ch/blickfang
Frühlingsreise
Die Migros bietet als erste Detailhändlerin Reisen zu ihren Früchte- und Gemüseproduzenten in Südspanien an. Zusammen mit Hotelplan geht es Ende Mai nach Andalusien, wo die Reisenden ausser über Spargeln und Steinfrüchte auch etwas über Sevilla und Valencia erfahren können.
Text: Thomas Tobler

Die Migros geht auf Reisen und nimmt interessierte Kunden mit. Als erste Detailhändlerin überhaupt veranstaltet sie in diesem Frühling eine Reise zu verschiedenen ihrer Früchte- und Gemüseproduzenten, verbunden mit kulturellen Exkursionen durch einzelne Städte Südspaniens. Aus diesem Gebiet zwischen Valencia und Sevilla importiert die Detailhändlerin einen bedeutsamen Teil ihres Früchte- und Gemüsesortiments, unter anderem Erdbeeren, Nektarinen, Spargeln, Orangen, Melonen und Oliven.
Die klimatischen Voraussetzungen in Andalusien, das Thermometer fällt kaum einmal unter 15 Grad, bieten für das Wachstum dieser Produkte besonders günstige Bedingungen. Zwar wird die Herkunft der Früchte und des Gemüses von Gesetzes wegen klar deklariert, die lokalen Anbaubedingungen, die Erntemethoden und die detaillierten logistischen Abläufe beim Transport
in die Schweiz kennen allerdings nur Fachleute. Das will die Detailhändlerin mit ihrem Reiseangebot ändern. «Interessierten Personen zeigen wir vor Ort, was die Migros im Bereich des nachhaltigen Anbaus unternimmt und wie dies in Südspanien umgesetzt wird», sagt Philipp Schmidlin. Beim Migros-Genossenschafts- Bund ist er für das Früchtesortiment verantwortlich und Mitinitiator des aussergewöhnlichen Reiseprojekts.
«Bei uns gehen immer wieder Kundenanfragen zu den Themen Anbau, Transport oder Selektion von Früchten und Gemüsen ein. Mit dem neuen Reiseangebot wollen wir diese Fragen beantworten, Migros-Lieferanten direkt im Produktionsgebiet besuchen und zusätzliches Wissen über ihre Arbeit und ihre Methoden vermitteln – und selbstverständlich soll auch der touristische Aspekt mit den Besichtigungen der grossartigen Städte Valencia, Sevilla oder Granada
nicht zu kurz kommen.» Die Reise ist so terminiert, dass der Besuch bei den Lieferanten auf die Erntezeit Ende Mai respektive Anfang Juni fällt. «Die Reisenden erhalten einen Einblick in den gesamten Ernteprozess und die Qualitätskontrollen der Früchte, die sie kurz darauf in den Migros-Filialen in der Schweiz kaufen können.»
Spezialreisen sind gefragt
Die Reisenden werden dabei von einem Reiseführer begleitet. Alle fachlichen Fragen, die beim Besuch der Produzenten anfallen, beantwortet ein Früchte- und Gemüseexperte der Migros oder auch der Produzent vor Ort. «Alle Produzenten, bei denen wir angefragt haben, zeigten sich von der Idee begeistert und sind nun sehr gern bereit, Auskunft zu geben und den Reisenden ihre Betriebe zu zeigen», sagt Schmidlin. Der siebentägige Trip wird von Hotelplan organisiert. Auch für den etablierten Reisever-

anstalter der Migros hat das Angebot Pioniercharakter. «Wir wollen damit etwas Neues versuchen, sehen aber, dass solche Spezialreisen bei den Kunden generell immer beliebter werden. Nicht zuletzt, weil sie von Experten und Spezialisten begleitet werden», sagt Prisca HugueninditLenoir, Kommunikationsverantwortliche der Hotelplan Group. Die Reise wird 3350 Franken kosten. Darin enthalten sind neben den Übernachtungen in gehobenen BoutiqueHotels auch die Hin und Rückflüge, die Reiseleitung, alle Mahlzeiten im Reiseprogramm sowie sämtliche Ausflüge. Der Gesamtpreis ist so kalkuliert, dass für die Migros kein Gewinn entsteht, sondern die Aufwände der Reise gedeckt sind. «Wir hoffen natürlich auf ein reges Interesse», sagt Philipp Schmidlin. Es ist vorstellbar, dass die Migros künftig auch Reisen an andere Anbaudestinationen in der Schweiz und den umliegenden europäischen Ländern anbietet. MM
1 Pfirsichbäume, so weit das Auge reicht. Der Besuch eines Steinfruchtproduzenten steht am zweiten Reisetag auf dem Programm.
2 Der Zwischenstopp in der historischen Stadt Granada ist ein kultureller Höhepunkt der Reise.
3 Orangenbäume sieht man in Andalusien auf vielen Feldern und auch in zahlreichen privaten Gärten.
4 Huétor-Tájar zwischen Sevilla und Granada ist für den Anbau von grünen Spargeln bekannt.



Reiseprogramm Alhambra und Melonen
Infos und buchen: Hotelplan- und Travelhouse-Filialen, Globus Reisen Lounges oder in jedem Reisebüro. Telefon: 043 211 88 85 Online: www.hotelplan. ch/o-130023
Tag 1: Zürich – Valencia Mittags Flug von Zürich nach Valencia. Am Nachmittag Erkundung der Stadt mit dem Velo
Tag 2: Valencia – Torre-Pacheco Fahrt nach Bélgida. Besuch beim Produzenten von Biosteinfrüchten wie Pflaumen und Pfirsichen. Anschliessend Besuch in Torre-Pacheco, wo man einiges über Melonen erfährt.
Tag 3: Torre-Pacheco – Granada Besuch der historischen Stadt Granada mit ihren Sehenswürdigkeiten und der Besichtigung des Wahrzeichens, der Palastanlage Alhambra
Tag 4: Granada Führung durch die Olivenölproduktion und Kennenlernen des Olivenöl-ABCs.
Tag 5: Granada – Sevilla Auf dem Weg nach Sevilla Halt in HuétorTájar. Die Region ist für den Anbau von grünen Spargeln bekannt. Geplant ist hier der Besuch des Ernteprozesses.
Tag 6: Sevilla Auf einem Stadtrundgang entdeckt man die Geschichte der Hauptstadt von Andalusien. Am Nachmittag geht es zur Besichtigung einer Beerenproduktion.
Tag 7: Sevilla – Zürich Transfer nach Malaga und Flug nach Zürich




Ihr Reiseprogramm:


Eine Reise wie aus dem Bilderbuch! Erleben Sie auf einer Reise die schönsten Inseln Italiens. Eine unvergessliche Reise auf der Sie immer wieder aufs Neue durch atemberaubende Ausblicke verzaubert werden. Zwischendurch geniessen wir toskanische Weine oder verbringen schöne Stunden in bester Gesellschaft und italienischen Köstlichkeiten in Frascati.
1. Tag– Anreise in die Südtoskana Fahrt im komfortablen Extrabus in die Südtoskana, wo wir in unserem Hotel mit dem Nachtessen erwartet werden.
2. Tag – Elba
Durch schöne Landschaften fahren wir nach Piombino, wo uns unser Fährschiff für die kurze Überfahrt nach Elba erwartet. Bei einer beeindruckenden Insel-Rundfahrt zeigen wir Ihnen dann die Vielfältigkeit des kleinen Juwels im Mittelmeer. Erfahren Sie dabei allerlei aus der bewegten Geschichte und freuen Sie sich auf ein wunderschönes Naturparadies mit farbenprächtigen Blumen und Pflanzen, glasklarem Wasser, bizarren Felsenklippen und wildromantischen Buchten. Am Abend Fährüberfahrt zurück aufs Festland und Rückfahrt ins Hotel.
3. Tag – Albaner Berge & Frascati
Auf unserem Weg Richtung Golf von Gaeta passieren wir die Albaner Berge. Die südöstlich von Rom gelegene Gegend ist bekannt für ihren Wein (Frascati) und dient vielen Römern als Naherholungsgebiet. In Frascati bietet sich uns

ein atemberaubender Blick auf Rom. In einer typischen Cantina werden wir hier zu einem feinen Mittagessen erwartet. Danach Weiterfahrt zum Golf von Gaeta, unserem idealen Ausgangsort für die nächsten Tage.
4. Tag – Capri
Halten Sie Ihren Fotoapparat bereit – mit Capri erwartet uns heute eine der schönsten Inseln der Welt! Schon die Einfahrt mit dem Schiff in den Hafen mit den pittoresken, bunten Häusern wird Sie begeistern. Wir beobachten das mondäne Leben auf der weltberühmten Piazzetta, spazieren zu den wunderschönen Augustus Gärten (Eintritt inkludiert) und geniessen die traumhafte Aussicht auf die Faraglioni-Felsen – fantastisch! Am späten Nachmittag Rückfahrt mit dem Schiff nach Neapel und von da mit dem Bus ins Hotel.
5. Tag - Ischia
Nach dem Frühstück fahren wir zum Hafen von Pozzuoli, von wo aus wir mit dem Schiff auf Ischia übersetzen. Bei einer herrlichen Panoramafahrt lernen wir dann die dritte Inselperle unserer Reise kennen. Hinter bizarren Steilküsten und kleinen Sandbuchten tauchen Weingärten und kleine Dörfer mit ineinander

verschachtelten Häusern auf. Neben atemberaubenden Landschaftsbildern sehen wir auf Ischia unter anderem die alte Seefahrerkirche Socorso und das malerische St. Angelo, wo genügend Zeit zum Verweilen bleibt. Am späten Nachmittag Rückfahrt per Schiff und Bus zu unserem Hotel.
6. Tag – Montepulciano & der Wein
Eine Traumtrilogie zum absoluten Spitzenpreis! Limitierte Plätze! Sofort buchen & profitieren! Tel. 0848 00 77 88
Auf unserer Rückfahrt streifen wir heute die wunderschöne Gegend von Montepulciano und damit die unbestrittene Weinhochburg der Toskana. Bei unserem Besuch auf einem bekannten Weingut erfahren wir viel Wissenswertes rund um die Spitzenweine, welche wir selbstverständlich auch verkosten werden. Gleichzeitig geniessen wir einen kleinen Imbiss mit Spezialitäten aus der Region! Danach Weiterfahrt in den Raum Gardasee und Nachtessen im Hotel.
7. Tag – Heimreise
Mit vielen unvergesslichen Eindrücken im Gepäck treten wir heute die Heimreise an.
Noch mehr sparenbis 100% REKA-Checks!

Leistungen - Alles schon dabei! 7 Reisetage inkl. Halbpension ab nur
233
✓ Fahrt mit dem komfortablen Extrabus während der ganzen Reise
✓ 2 Übernachtungen im gehobenen Mittelklassehotel in der Südtoskana
✓ 3 Übernachtungen im gehobenen Mittelklassehotel am Golf von Gaeta

✓ 1 Übernachtung im Raum Gardasee
✓ 6 x Frühstück in den Hotels
✓ 6 x Nachtessen in den Hotels
✓ Fährüberfahrt Piombino-PortoferraioPiombino
✓ Mittagessen in einer typischen Cantina in Frascati
✓ Schifffahrt Neapel-Capri-Neapel
✓ Schifffahrt Pozzuoli-Ischia-Pozzuoli
✓ Geführte Inselrundfahrt auf Ischia & Elba
✓ Geführter Inselrundgang auf Capri inkl. Eintritt Gärten von Augustus
✓ Weindegustation im Raum Montepulciano inkl. kleinem Imbiss
✓ Eigene Schweizer Reiseleitung während der ganzen Reise
Wählen Sie Ihr Reisedatum:
Unser Sonderpreis für Sie:
Preis pro Person im Doppelzimmer in gehobenen
Mittelklassehotels Fr. 969.-
Nicht inbegriffen/zusätzlich wählbar: Einzelzimmerzuschlag nur Fr. 175.Buchungsgebühr: Fr. 20.- pro Person
Sie wählen Ihren Bus-Einsteigeort: Aarau, Basel, Bern, Bellinzona, Luzern, Pfäffikon SZ, St. Gallen, Sargans, Thun, Wil SG,
Welche Blüten die Frittierkunst treibt, zeigen wir diesmal in einem Zwiebelrezept. Auch sonst bekommt alles sein Fett ab: Fettgebackenes erreicht zwar traditionell zur Fasnacht seinen Höhepunkt, ist aber das ganze Jahr über fein. Wir zeigen, was gern frittiert wird.
Claudia

Zwiebeln sind meist bescheidene Begleiter in Gerichten, doch ohne sie läuft nichts. So richtig blühen sie in heissem Frittieröl auf.
STEP-BY-STEP ZUM KOCH-PROFI WERDEN! Tolle Kochvideos auf migusto.ch

Das neue Kochmagazin der Migros
Erhältlich in den Filialen für Fr. 3.–, für Clubmitglieder gratis. Jetzt anmelden: www.migusto.ch
Topfgeschichte

Tempura
Was den Italienern ihr Fritto misto, ist den Japanern ihr Tempura. Anders als bei der italienischen Variante, wird der Teig allerdings meist mit Reismehl zubereitet. Meeresfrüchte werden dabei genauso frittiert wie Gemüse. Da Tempura sehr fetthaltig ist, wird Frittiertes gern mit leichten Gerichten kombiniert.
Bierteig
Egal, was hierzulande frittiert wird – meist ist Bierteig im Spiel. Dabei geht es nicht nur um den eher dezenten Geschmack, sondern um die Triebkraft des Gerstensafts –der Bierhefe sei Dank. Ob Fischknusperli oder Kräuterblätter: Der Bierteig sorgt für eine knusprige, luftige Hülle. Im Sommer bis in den Herbst beliebt: gefüllte und frittierte Zucchiniblüten.
Pakoras
Indisches Streetfood wäre ohne Pakoras undenkbar. Ein Teig aus Kichererbsenmehl umhüllt jegliches Gemüse, das oft in mobilen Strassenküchen zubereitet wird. Dazu passen Chutneys der indischen Küche oder auch Joghurt-Dips (Raita). Das Wort Pakora bedeutet übrigens so viel wie «Frittiertes».
Küchlein und Beignets Nicht nur auf Jahrmärkten erfreuen sich Apfelküchlein und andere frittierte Früchte wie etwa Ananas grosser Beliebtheit. Wahlweise werden die in Scheiben geschnittenen Früchte in Bierteig oder einem alkoholfreien Teig gewendet, bevor sie frittiert werden. Am Schluss wird das Frittierte mit Zimtzucker oder Zucker pur bestreut.



2.90 statt 3.10 –.20 günstiger

Die Butter Mödeli, 250 g






Gesamtes Léger Sortiment




z.B. Chips Paprika, 200 g, 3.90, gültig bis 5.2.2018 20x PUNKTE


M-Classic Sonnenblumenöl 1 Liter z.B. 2 Stück zu Fr. 3.90 statt 7.80, ab 2 Stück, 50% günstiger 50% ab 2 Stück









Optigal Pouletschnitzel Schweiz, per 100 g 2.80 statt 3.30 15%




Blutorangen Italien, Netz, 2 kg 3.90 statt 5.60 30%



Gesamtes Damen- und HerrenStrumpfwaren-Sortiment (ohne SportXX), z.B. Ellen Amber Strumpfhose Vitale, oyster, Gr. M, pro Stück, 6.– statt 12.–50%
Genossenschaft Migros Wallis Bei allen Angeboten sind M-Budget und bereits reduzierte Artikel ausgenommen.
ANGEBOTE GELTEN NUR VOM 23.1. BIS 29.1.2018, SOLANGE VORRAT

Clementinen Orri Spanien, per kg 3.20 Hit










Alle Cucina & Tavola- und VictorinoxKüchenmesser sowie -Scheren z.B. Victorinox Brotmesser, pro Stück, 11.40 statt 22.80, gültig bis 5.2.2018 50%




























































4.95 statt 9.90 50% Duo-Pack

TerraSuisse Speckwürfeli im Duo-Pack 4 x 96 g





2.70 statt 4.50

Rindsbraten vom Stotzen Schweiz, per 100 g





2.15 statt 3.65 40%



TerraSuisse Nuss-Schinkli gepökelt und geräuchert, per 100 g





1.80 statt 3.–40%

M-Classic Schweinsgeschnetzeltes in Sonderpackung Schweiz, per 100 g





2.65 statt 3.55 25%

Le Gaulois La Belle Trutenschnitzel Frankreich, per 100 g










statt 23.10
Bio-Rauchlachs in Sonderpackung Zucht aus Irland/Schottland/Norwegen, 260 g



3.90 statt 5.60 30%

Schweinsfilet Schweiz, per 100 g







Tulpen, Bund, 20 Stück erhältlich in diversen Farben, z.B. rot-gelb, pro Bund










































ab 2 Stück

Gurken
Spanien, z.B. 2 Stück zu Fr. 1.80 statt 2.40, ab 2 Stück, 25% günstiger 25%




Kartoffeln festkochend «Aus der Region.» Tragtasche, 2.5 kg 2.80 Hit


5.95 statt 7.50 20%

mit Milch aus Greyerz Schweiz, 12 x 90 g






Blumenkohl Italien/Spanien, per kg 2.45 Hit






Kolumbien, per kg 1.95 Hit










Eichblattsalat grün und rot Frankreich, pro Stück, z.B. grün 1.35 statt 2.30 40%





500 g 1.85 statt 2.50 25%



Feine Poulet-Stückchen an einer sämigen Satay-Sauce zählen zu den Klassikern der asiatischen Küche. Hervorragend passt dazu ein süsssaurer Chinakohlsalat mit Erdnussbutter und Granatapfelkernen. Das Rezept dafür finden Sie auf migusto.ch










































Duo-Pack



33%
Haselnuss-Vogelnestli, Spitzbuben oder Cocos-Makronen im Duo-Pack z.B. Haselnuss-Vogelnestli, 2 x 216 g, 4.15 statt 6.20
20% ab 3 Stück





z.B. gemahlen, 500 g, 6.15 statt 7.70 20%







Alle Exquisito Kaffees, in Bohnen und gemahlen, 500 g und 1 kg, UTZ









Alle Frey Tafelschokoladen, 100 g und 400 g, UTZ (ohne Eimalzin, M-Classic, Suprême oder Mehrfachpackungen), ab 3 Stück, 20% günstiger












Alle Backmischungen, Cup Lovers und Dessertpulver z.B. Backmischung Brownies, 490 g, 4.85 statt 6.10 20%

Gesamtes Blévita Sortiment (ohne Beef Chips), ab 2 Stück, jedes –.60 günstiger, z.B. Sesam, 295 g, 2.70 statt 3.30 –.60 günstiger ab 2 Stück


Gesamtes Klostergarten Tee-Sortiment ab 2 Stück, 20% günstiger 20% ab 2 Stück











24.10 statt 48.20 50%





M-Classic Hamburger in Sonderpackung tiefgekühlt, 12 x 90 g 8.10 statt 16.20 50%



Total Waschmittel in Sonderpackung Classic oder Color, 7.5 kg, z.B. Color, gültig bis 5.2.2018


ChocMidor Konfektwaffeln im 3er-Pack Classico, Noir oder Diplomat, z.B. Classico, 3 x 165 g, 6.40 statt 9.60 33%










Alle Coca-Cola im 8er-Pack, 8 x 50 cl z.B. Classic, 7.80 statt 10.40 8 für 6 8er-Pack ANGEBOTE





Gesamtes Farmer’s Best Sortiment tiefgekühlt, z.B. Blattspinat, 800 g, 3.10 statt 3.90 20%







Alle Konfitüren und Gelées in Gläsern sowie Beuteln, 185–500 g (ohne Alnatura), ab 2 Stück, 20% günstiger 20% ab 2 Stück









Alle M-Classic- und Denny’s-Kartoffel-Produkte tiefgekühlt, z.B. Denny’s Wedges, 600 g, 3.65 statt 4.60 20%



Alle Bio-Frühstückscerealien (ohne Alnatura), z.B. Sonnenblumenkerne, 400 g, 1.80 statt 2.25 20%






Alle Rivella im 6er-Pack, 6 x 1.5 Liter z.B. rot 9.60 statt 14.40 33%




Duo-Pack



Sun Queen Premium Nuts im Duo-Pack z.B. Nussmischung, 2 x 170 g, 8.30 statt 10.40 20%




Duo-Pack





Gesamtes Pancho Villa Sortiment z.B. Salsa Mexicana Medium, 312 g, 2.95 statt 3.70 20%

pH balance Produkte im Duo-Pack z.B. Duschgel, 2 x 250 ml, 5.10 statt 6.40, gültig bis 5.2.2018 20%









3er-Pack
Alle Zoé Produkte (ohne Zoé Sun), z.B. Revital Straffende Tagescreme, 50 ml, 10.05 statt 13.50, gültig bis 5.2.2018 25%




John Adams Herren-Shorts im 3er-Pack erhältlich in diversen Farben, Gr. S–XL, z.B. marine, Gr. M, gültig bis 5.2.2018 14.90 Hit 3er-Pack








19.90 Hit







Candida Zahnpflege in Mehrfachpackungen z.B. Fresh Gel Zahnpasta im 3er-Pack, 3 x 125 ml, 5.50 statt 8.25, gültig bis 5.2.2018 33%

John Adams Herren-Shorty erhältlich in diversen Farben, Gr. S–XL, z.B. blau, Gr. M, gültig bis 5.2.2018




Alle Grether’s Pastillen z.B. Blackcurrant ohne Zucker im Nachfüllbeutel, 100 g, 5.80 statt 7.30 20%




54.90 statt 99.90 45%

Fitbit Flex 2 Fitnessarmband schwarz Bewegungserinnerung, SchwimmtrainingAufzeichnung sowie Schlaf- und Aktivitätserkennung, grössenverstellbar, pro Stück














Linsoft- und Tempo-Taschen- sowie -Kosmetiktücher




Alle Milette-Windeln und -Pants (ohne Stabwindeln), z.B. Maxi 4+, 9–18 kg, 39 Stück, 5.90 statt 11.80, gültig bis 29.1.2018 50%

z.B. Linsoft Kosmetiktücher im 3er-Pack, 4.55 statt 5.70, gültig bis 5.2.2018 20% 3er-Pack

Gesamtes Milette Baby-Pflege- und -Waschmittel-Sortiment (ohne Mehrfachpackungen), ab 2 Stück, 20% günstiger 20% ab 2 Stück






ANGEBOTE GELTEN NUR VOM 23.1. BIS 5.2.2018, SOLANGE VORRAT

Calgon Gel im Duo-Pack 2 x 750 ml 14.90 statt 19.–20% Duo-Pack










Vanish Oxi Action Pulver Pink oder Weiss in Sonderpackung 1.5 kg, z.B. Pink 14.20 statt 21.30 33%





Gesamtes Cucina & Tavola Geschirr-Sortiment aus Porzellan und Glas (ohne Hit-Produkte), z.B. Rechteckplatte klein, pro Stück, 6.45 statt 12.95 50%


Fisch, Fleisch und Geflügel



Wienerli «Aus der Region.», 2 x 100 g, 2.20 statt 2.85 20%
Optigal Poulet Roasty, Schweiz, per 100 g, 1.80 statt 2.30 20%
MSC Miesmuscheln, Niederlande, 1 kg, 6.95 statt 8.70 20%
Lammhuft, Neuseeland, per 100 g, 3.60 statt 4.50 20%
Brot und Milchprodukte


Parmigiano Reggiano Keil, per 100 g, 2.25 statt 2.85 20%
M-Classic Tortelloni im Duo-Pack, z.B. Ricotta e spinaci, 2 x 500 g, 6.90 statt 11.60 40%
Alle Steinofen-Brote und -Kleinbrote, z.B. Bio-Twister hell, 360 g, 2.60 statt 3.30 20%
Alle Erdbeerpatisserie-Produkte, z.B. Erdbeerbecher, 95 g, 2.30 statt 2.90 20%
Original Elsässer Flammkuchen im Duo-Pack, z.B. gross, 2 x 350 g, 7.80 statt 9.80 20%
Bio-Randen gekocht, Schweiz, Packung, 250 g, 1.60 statt 2.– 20%
AOP Vacherin Fribourgeois mild, Schweiz, Portion, ca. 250 g, per 100 g, 1.50 statt 1.90 20%
Tomme Aletsch «Aus der Region.», 1/1, 1/2 oder 1/4 Laib, per 100 g, 2.– statt 2.50 20%
Blumen und Pflanzen




Blumenschale Anna für den Innenbereich, pro Stück, 14.90 statt 16.90 10%
Weitere Lebensmittel

San Pellegrino Sanbittèr im 6er-Pack, 6 x 10 cl, ab 2 Stück 20%
Frey Schokoladen-Kugeln in Sonderpackung, UTZ, Milch extra, Giandor und assortiert, 750 g, z.B. assortiert, 11.– statt 18.60 40%
Frey-Les Dragées-Original 1 kg und -Princess 450 g sowie -Schokoladenriegel im 18er-Pack, UTZ, z.B. Original, 1 kg, 8.90 statt 12.80 30%
M-Classic- und Léger-MicrowavePopcorn im 10er-Pack, z.B. M-Classic Microwave Popcorn, 10 x 100 g, 4.90 statt 7.– 30%
Alle Salatsaucen, Vinaigretten und Salat-Croûtons, fixfertig, ungekühlt (ohne Alnatura), z.B. M-Classic French Dressing, 700 ml, 2.05 statt 2.60 20%

Gesamtes Selina KatzenfutterSortiment, z.B. Catsticks mit Forelle und Lachs, 36 g, 1.– statt 2.– 50%
Cucina & Tavola Küchentücher im 4er-Pack, erhältlich in diversen Farben, 50 x 70 cm, z.B. lila, 9.80 Hit **
Servietten forbetter your english, erhältlich in 5 verschiedenen Sujets, 33 x 33 cm, 50 Stück, z.B. Cherry Eating, 3.90 Hit **
Zündhölzer im 10er-Pack, 1.60 Hit
John Adams Herrensocken im 7er-Pack, in Schwarz oder Anthrazit Gr. 39–42 und 43–46, z.B. schwarz, Gr. 43–46, 14.90 Hit **
Total Waschmittel in Flasche, 5 Liter, z.B. 1 for all, 19.75 statt 39.50 50% **
Le Petit Marseillais im 3er-Pack, z.B. Duschcreme Orangenblüten, 3 x 250 ml, 6.95 statt 10.50 33%
Gesamtes Katzenstreu-Sortiment, z.B. Fatto Plus, 10 Liter, 4.95 statt 7.10 30%
Alle Migros Plus-Reinigungsmittel und -Waschmittel, z.B. Cremereiniger Lemon, 500 ml, 2.80 statt 3.50 20%
Rucksack Cockpit Explorer, erhältlich in Schwarz, Türkis oder Grau, z.B. schwarz, pro Stück, 24.80 statt 29.80 15% **
Migros Fresh Raumspray Pure Air, 275 ml, 4.90 Neu **
Twist Professional Haushaltpapier, 2 Rollen, 3.80 Neu **
M-Plast Kalt-Warm-Kompresse, pro Stück, 9.90 Neu **
Sanactiv D-Mannose, 19.80 Neu **
I am Natural Cosmetics, Natural Beauty Set, pro Stück, 7.50 Neu **
I am Natural Cosmetics, Bodylotion und Duschbalsam Orange & Ingwer, z.B. Duschbalsam, 200 ml, 3.90 Neu **
Tartare Perlen mit Kräutern, 100 g, 3.90 Neu **
bis 5.2. Genossenschaft Migros Wallis ANGEBOTE GELTEN NUR VOM 23.1. BIS 29.1.2018,













Raffiniert
Zwiebelblumen mit Dip
Zutaten für 4 Personen ca. 4 Zwiebeln
150 g Mehl
1 TL Salz
½ TL Pfeffer
½ TL Knoblauchpulver
4 TL edelsüsser Paprika
1 Ei
2,5 dl Milch Öl zum Frittieren, z. B. HOLL-Rapsöl
Dip:
1 Bund Schnittlauch
4 EL Mayonnaise
4 EL griechisches Joghurt nature Salz, Pfeffer
½ TL edelsüsser Paprika
1 Msp Cayennepfeffer
1 EL Zitronensaft
Zubereitung
1. Zwiebeln schälen, dabei den Wurzelansatz belassen. Auf den Wurzelansatz auf ein Brett stellen.
2 Essstäbchen eng dazulegen. Mit einem scharfen Messer die Zwiebeln von oben ca. 4 Mal einschneiden. Die Stäbchen verhindern das Durchschneiden.
2. Mehl, Salz, Pfeffer, Knoblauchpulver und Paprika in einer Schüssel mischen. Ei und Milch in einer weiteren Schüssel verquirlen.
3. Die Zwiebeln vorsichtig mit der Mehlmischung bestäuben, abklopfen und mit der Ei-Milch-Mischung gut benetzen. Nochmals bestäuben. Ca. 40 Minuten kühl stellen. Mehlmischung aufbewahren.
4. Inzwischen für den Dip Schnittlauch fein schneiden und mit den anderen Zutaten mischen.
5. Öl auf ca. 180 °C erhitzen. Zwiebeln vor dem Frittieren nochmals mit der Mehlmischung bestäuben. Zwiebeln vorsichtig in das heisse Frittieröl legen und ca. 5 Minuten goldbraun frittieren. Zwiebeln auf einem Haushaltspapier abtropfen lassen. Mit Salz bestreuen und mit dem Dip servieren.


Ich liebe Gemüse, Fisch und Früchte, wenn sie knusprig aus dem heissen Fett kommen. Das Frittieren überliess ich lange Zeit aber lieber den Profis ausserhalb der heimischen Küche, weil sich der Geruch in der offenen Küche zu lange hielt. Ausserdem hatte ich keine Fritteuse.
Dabei geht sauberes Frittieren ganz einfach. Dazu benutze ich eine grosse Pfanne mit passendem Frittierkorb. Viele scheuen diese Methode wegen der Fettspritzer. Ich habe damit kein Problem. Zu beachten ist: erst den Korb im heissen Fett versenken, dann das Frittiergut hineingeben; sonst klebt alles am Korb fest. Ebenfalls wichtig: das Frittiergut nicht einfach ins Fett fallen, sondern vorsichtig und stets vom Körper weg in die Pfanne gleiten lassen; falls das Fett spritzt, spritzt es somit nicht in meine Richtung. Und gegen den unangenehmen Frittiergeruch hilft ein Teelöffel Zimt in etwas heissem Wasser in einer kleinen Schüssel. MM
Viele weitere kochtipps ZU FRITTIERTEM jetzt auf migusto.ch
Apfelküchlein: www.migusto.ch/apfelkuechlein Fischknusperli: www.migusto.ch/fischknusperli Tempura: www.migusto.ch/tempura
Nur noch bis 18. Februar 2018!
MEX Stuhl
Anilinleder , Sand
Gestell Edelstahl statt 299.–149.–

PONTO Bowl
div. Farben
Ø 15 × 8 cm statt 9.90 2.95










ZAC Esstisch Nussbaum 200 × 90 × 75 cm statt 1499.–749.–






NATURA BASIC Matratze
Triokern aus festem Polyetherschaum mit Innenprofilierung
Hülle aus Schafschurwolle 90 × 200 cm statt 399.–


Auch in 140 × 200 cm und 160 × 200 cm erhältlich
Auf Verpackungen von Lebensmitteln findet sich oft der Hinweis «Nach dem Öffnen rasch konsumieren». Warum lässt sich keine exaktere Frist nennen?
Wie lange Lebensmittel in geöffneten Verpackungen haltbar bleiben, hängt stark davon ab, wie das Produkt gelagert und auch sonst mit ihm umgegangen wird. Es spielt zum Beispiel eine Rolle, ob jemand aus einem Glas oder stattdessen direkt aus einer Flasche trinkt, wodurch Keime in ein Getränk gelangen können. Bei gekühlt aufbewahrten Lebensmitteln ist es auch von Bedeutung, wie schnell sie nach dem Öffnen wieder in den Kühlschrank gelangen.
Wegen der vielen Einflussfaktoren lässt sich die Konsumationsfrist angebrochener Lebensmittel oft nicht genauer definieren. MM

Haben Sie eine Frage?
Kontaktieren Sie uns! M-Infoline, der Kundendienst der Migros, erreichbar unter 0800 84 0848 oder www.migros.ch/ kundendienst
Telefonisch erreichbar
Montag bis Freitag: 8.00–18 00 Uhr
Samstag: 8.30–16 30 Uhr
Anrufe auf die oben genannte Nummer sind gratis.
Anzeige
BEI ERHÖHTER BELASTUNG
Supradyn energy baut auf und aktiviert
90 Filmtabletten
CHF 52.70
statt CHF 65.90
45 Brausetabletten
CHF 36.70 statt CHF 45.90

Gültig bis 4.2.2018

AUFBAU-KUR FüRS HAAR
Unterstützt das Haarwachstum: Priorin N
270 Kapseln CHF 99.80 statt CHF 124.80

Lesen Sie die Packungsbeilage. Keine Kumulation mit anderen Rabatten. www.achillea.ch www.dropa.ch Apotheken und d rogerien
MitgezielterErnährungs-undStoffwechseltherapiezumehrGesundheit,Wohlbefinden undVitalität.GesundheitstärkenunderhaltenbisinshoheAlter,ursächlichetwas gegenchronischeErkrankungenselberundaktivtun.WirzeigenIhnen,wasundwieesgeht, mit25-jährigerErfahrung,nachhaltigunderfolgreich.
Das Fachkurhaus in Berlingen ist ein spezialisiertes Kurhaus für komplementäre Medizin mit den Schwerpunkten Ernährungs- und Stoffwechseltherapie. Die ganzheitliche Philosophie, die modernen Behandlungs- und Schulungsmethoden sowie die idyllische Lage am Bodensee bieten perfekte Voraussetzungen für einen nachhaltigen Therapieerfolg: Ob bei Übergewicht, Diabetes, Bluthochdruck, hohem Cholesterin, Darmproblemen oder anhaltendem Stress – seit mehr als 25 Jahren profitieren Menschen mit unterschiedlichsten Problemen von den IntensivKur(s)wochen im „Seeblick“.
Ursächliche Behandlung von Stoffwechselstörungen

Dr. med. Padia Rasch Leitende Ärztin Fachkurhaus Seeblick
Ein gut funktionierender Stoffwechsel ist die Grundlage für körperliches und seelisches Wohlbefinden. Umgekehrt gilt: Jede Krankheit hat ihre Ursache in einer Störung des Stoffwechsels. Substanzen können dann nicht mehr abgebaut und ausgeschieden werden, sie reichern sich an und können den Körper vergiften. Die Symptome sind vielfältig: Schlafstörungen, zu hohe Zucker-, Fett- und Leberwerte, Verdauungsprobleme, Müdigkeits- und Erschöpfungszustände oder rheumatische Beschwerden sind nur ein paar Beispiele. Im Fachkurhaus Seeblick nehmen wir uns viel Zeit für Sie.
Sie lernen bei unseren Fachvorträgen,wieSieIhreErnährungsooptimieren,dassSie langfristigeundnachhaltige Erfolgeerzielen.
Vorbeugen ist besser als heilen
Um die Gesundheit zu erhalten, hilft es, dem Körper mal eine Auszeit zu gönnen. Mit unserem EPD®-Ernährungsprogramm regen Sie Ihren Stoffwechsel an und bringen ihn wieder in Balance. Wir ermitteln Ihren individuellen Bedarf an Vitaminen, Mineralien, Spurenelementen, Ballast- und Aufbaustoffen und gleichen Defizite mit unseren massgeschneiderten HCK®-Mikronährstoffrezepturen gezielt aus. So bekommt Ihr Körper genau das, was er braucht. Schon nach kurzer Zeit spüren Sie die positive Wirkung. «Erfolglos habe ich mich von Diät zu Diät gehungert»
Dies ist die Aussage von vielen Hilfesuchenden. Schuld hat der sogenannte Jo-Jo-Effekt, also die unerwünschte schnelle Gewichtszunahme nach einer Reduktionsdiät. Oft leidet dann die Motivation. Während einer Intensiv-Kur(s)woche wird Ihnen gezeigt, wie Sie dank der EPD®-Ernährungstherapie diesen Teufelskreis beenden.
Ziele des Aufenthaltes im Fachkurhaus Seeblick
• Rasch und gesund Depotfett abbauen
• Cholesterinwerte und Blutdruck reduzieren
• Körper regenerieren und vitalisieren
• Körpereigene Abwehrkräfte gezielt stärken
• Tiefgreifend entgiften
Spezialangebot:
1 Woche im Doppelzimmer pro Person ab CHF 998.–statt CHF 1242.–1 Woche im Einzelzimmer ab CHF 1218.–statt CHF 1400.–Im Preis inbegriffen sind: 6 Übernachtungen (Sa – Fr), Kurse und Vorträge, komplette Verpflegung (EPD®-Ernährungsprogramm) inkl. Getränke, Benutzung Whirlpool und Tepidarium, Morgengymnastik, Fitness-Center Kronenhof.
«Nach der Entgiftung meines Körpers fühle ich mich fit und vital»

Seraina Hoffmann: «Um nach einem schweren Hexenschuss körperlich wieder besser auf der Höhe zu sein, wollte ich Gewicht reduzieren. Bereits in der ersten Woche im Fachkurhaus Seeblick habe ich mit dem EPD®-Ernährungsprogramm ohne Hungergefühl 3,5 Kilogramm abgenommen. Durch die Entgiftung meines Körpers bin ich auch Altlasten losgeworden. Ich fühle mich fit und vital, meine Haut ist besser, ich schlafe ruhiger und bin motiviert, mich mehr zu bewegen.»

Sa. 27.01. – Fr. 02.02.2018
Sa. 03.02. – Fr. 09.02.2018
Sa. 10.02. – Fr. 16.02.2018
Sa. 17.02. – Fr. 23.02.2018
Sa. 24.02. – Fr. 02.03.2018 Wunschtermin
Bitte senden Sie mir kostenlos und unverbindlich Unterlagen zu:
Name
Adresse
Telefon
Ernährungsmedizin Medical Wellness
Wieslistrasse 34 · Postfach 35 8267 Berlingen Telefon +41 (0)52 762 00 70 Fax +41 (0)52 762 00 71 info@seeblick-berlingen.ch www.seeblick-berlingen.ch
Ich interessiere mich für eine Intensiv-Kur(s)woche MM 01/2018

• Lindert sofort die Beschwerden
• Fördert die Wundheilung
• Schützt vor Kälte und Wind
Dies ist ein zugelassenes Arzneimittel. Lesen Sie die Packungsbeilage.
Erhältlich in Apotheken und Drogerien. Melisana AG, 8004 Zürich, www.melisana.ch




4 Reisetage, inkl. Halbpension ab nur






An der zauberhaften Blumenriviera erleben Sie den Frühlingsanfang da, wo er am allerschönsten ist. Freuen Sie sich auf ein farbenfrohes Wochenende voller schöner Frühlingsgefühle beim weltbekannten Karneval in Nizza und dem legendären Zitronenfest in Menton.
Ihr Reiseprogramm:
1. Tag, Freitag – Anreise Fahrt im komfortablen Extrabus an die Blumenriviera, wo uns die Küche unseres Hotels mit einem feinen Nachtessen erwartet.
2. Tag, Samstag – Karneval in Nizza Nach dem ausgiebigen Frühstück führt uns eine wunderschöne Panoramafahrt entlang der berühmten Corniches bis nach Nizza. Dabei erleben Sie die wohl schönste Küste Europas mit atemberaubender Aussicht auf malerische Buchten und Orte. Nizza empfängt uns dann mit den typisch farbigen Häusern, dem bekannten Blumenmarkt und den vielen hübschen Cafés, Restaurants & Boutiquen. Freuen Sie sich auf den weltberühmten Karneval, dessen Geschichte auf das Jahr 1294 zurückgeht. Bestaunen Sie den wunderschönen Blumencorso mit den bun-

ten Blumenwagen, fröhlich kostümierten Menschen und Figuren aus einer scheinbar anderen Welt! Wir haben für Sie tolle Tribünenplätze reserviert. Am Abend Nachtessen im Hotel.
3. Tag, Sonntag – Monaco, Bioves Gärten & Zitronenfest in Menton Den heutigen Tag beginnen wir mit einem Besuch im Fürstentum Monaco. Entdecken Sie dabei die pittoreske Altstadt auf eigene Faust und tauchen Sie in eine Welt voller Glamour und Lebensgefühl ein. Später fahren wir nach Menton – geschützt durch die Seealpen im Hintergrund erfreut sich das Städtchen dem mildesten Klima an der Côte d’Azur. Gerade deshalb bezaubert der Ort mit vielen wunderschönen Gärten, in denen schon früh Orangen- und Zitronenbäume blühen. Davon können Sie sich bei unserem Besuch in den


bekannten Bioves Gärten überzeugen. Auch die hübsche Altstadt erwartet uns mit fantastischen Nachbildungen und Mosaike aus Zitronen und Orangen. Abschliessender Höhepunkt bildet dann der fantastische „Korso der goldenen Früchte“! Lassen Sie die gigantischen, mit Orangen und Zitronen geschmückten Umzugswagen an sich vorbeiziehen – Sie werden begeistert sein. Am Abend Nachtessen im Hotel.
4. Tag, Montag – Heimreise Nach dem Frühstück treten wir mit vielen unvergesslichen Frühlingseindrücken im Gepäck die Heimreise an.
Noch mehr sparenbis
Leistungen - Alles schon dabei!
✓ Fahrt im komfortablen Extrabus an die italienische Riviera
✓ 3 Übernachtungen in der gewählten Kategorie
✓ 3 x ausgiebiges Frühstücksbuffet
✓ 3 x feines Nachtessen im Hotel
✓ Ausflug nach Monaco
✓ Eintritt in die bekannten Bioves Gärten
✓ 1 x Eintrittskarte (Tribünenplatz) Blumenkorso in Nizza
✓ 1 x Eintrittskarte (Tribünenplatz) Zitronenfest in Menton
✓ Eigene Schweizer Reiseleitung während der ganzen Reise
Wählen Sie Ihr Reisedatum:
Reisehit 166 a: 23. - 26. Februar 2018
Reisehit 166 b: 2. - 5. März 2018
Unsere Sonderpreise für Sie:
Preis pro Person im Doppelzimmer im 3-Sterne-Hotel Fr. 489.im 4-Sterne-Hotel Fr. 549.-

Nicht inbegriffen/zusätzlich wählbar: Einzelzimmerzuschlag nur Fr. 125.Buchungsgebühr: Fr. 20.- pro Person
Sie wählen Ihren Bus-Einsteigeort: Aarau, Basel, Bern, Luzern, Pfäffikon SZ, Olten, St. Gallen, Sargans, Thun,
Migros-Marken
Mit der Entwicklung eigener Marken hat Migros-Gründer Gottlieb Duttweiler Schweizer Geschichte geschrieben und sich das Vertrauen der Kunden verdient. Viele der Produkte werden von der Migros in der Schweiz hergestellt. Alle haben eins gemeinsam: gute Qualität zu einem guten Preis.








Gute Qualität zum guten Preis









Diverse Aktionen für verschiedene Migros-Marken-Produkte vom 23. 1. bis 12. 2.





Ein Stück Schweizer Tradition






















Wecken KindheitsErinnerungen



















Mehr als 200 MigrosMarken





Gewinnspiel
Mit etwas Glück können Migros-Kunden noch bis 29. Januar mit ihrem Kassenbon Geschenkkarten und Cumulus-Punkte gewinnen. Weitere Teilnehmer konnten sich über ihre Gewinne freuen. Das Migros-Magazin stellt einige davon vor.

Aldina Alitsch (34)
Gewinn: 10 × Cumulus-Punkte in der Migros Steinhausen ZG
«Wir sind Stammkunden in der Migros. Mein Lieblingsprodukt sind die Berliner. Nicht mal diejenigen aus der Bäckerei sind besser. Beim nächsten Einkauf kriege ich sie dann sogar mit zehnfachen CumulusPunkten. So macht das Einkaufen Spass.»
Mitmachen und gewinnen: migros.ch/win

Melufa
mit
Gewinn: 10 × Cumulus-Punkte in der Migros Wallisellen ZH
Melufa: «Da wir durstig waren, habe ich mir und den Kindern nur schnell etwas zum Trinken gekauft.» Navid: «Am liebsten mag ich die 7up-Getränke. Dass wir heute gewonnen haben, ist einmalig! Das werde ich meinem Papa erzählen, der freut sich bestimmt.»

Lia Lobefido (21)
Gewinn: 5 × Cumulus-Punkte in der Migros Brügg BE
«Da mein Freund heute arbeitet, war ich einkaufen. Ich habe gerade Ferien. Wir wohnen zusammen und haben ein gemeinsames Cumulus-Konto. Den Coupon werden wir für unseren nächsten Einkauf nutzen. Ich bin normalerweise kein Glückskind, was Gewinnspiele betrifft. Ich dachte, ich probiere es einfach einmal aus.»

Gewinn: 5 × Cumulus-Punkte in der Migros Wallisellen ZH
«Ich freue mich sehr über den Gewinn, denn ich kaufe zu 95 Prozent in der Migros ein. Heute habe ich auch gleich noch etwas für meine Mutter gekauft, vor allem unsere Lieblingsschokolade. Sie fliegt bald nach Italien und bringt sie unseren Verwandten mit.»
MIGROS-WELT | MM4, 22.1.2018 67

Verena Bachmann (73)
Gewinn: 5 × Cumulus-Punkte in der Migros Wallisellen ZH
«Normalerweise kaufe ich immer dienstags und freitags in der Migros ein. Heute war es ausnahmsweise ein anderer Wochentag, und prompt habe ich beim Glücksrad gewonnen. Bei jedem Einkauf sind zwei Liter Milch dabei, da ich sehr viel Milch trinke. Das ist gut für die Knochen.»

Gewinn: 5 × und 10 × Cumulus-Punkte in der Migros Brügg BE
«Wir sind sehr glücklich. Vor allem, da wir die Familie und einander haben. Die Festtage verbrachten wir mit unserem Sohn, unserer Schwiegertochter und unserer Enkelin. Heute gingen wir alle gemeinsam in der Migros einkaufen und haben prompt gleich zwei Mal beim Glücksrad gewonnen.»
Kassenbon scannen und gewinnen
Mit etwas Glück können Migros-Kunden noch bis 29. Januar Geschenkkarten im Gesamtwert von Fr. 250 000.– und 100 Millionen CumulusPunkte* gewinnen.
So erfahren Sie sofort, ob Sie gewonnen haben:
In Ihrer Migros-Filiale: Scannen Sie direkt nach dem Einkauf den Strichcode auf dem Kassenbon am Gewinnspielautomaten in Ihrer Migros-Filiale ein. Wenn es in Ihrer Filiale keinen Automaten gibt, erfahren Sie auf migros.ch/win, wo Sie den nächsten Automaten in Ihrer Nähe finden.
In der App: Starten Sie die MigrosApp und scannen Sie den Strichcode auf dem Kassenbon ein.
Auf der Website: Geben Sie auf migros. ch/win den Zahlencode ein, den Sie unterhalb des Strichcodes auf dem Kassenbon sehen.
Den Gewinn erhalten Sie in Form einer Migros-Geschenkkarte oder eines CumulusVorteilscoupons direkt in Ihrer Filiale. Gratisteilnahme und Teilnahmebedingungen auf migros.ch/win
* Hochrechnung basiert auf Erfahrungswerten

Neuheiten
Wer beim Einkaufen nach Neuheiten Ausschau hält, wird in der Migros immer fündig. Auch die hier vorgestellten Produkte sind Newcomer im Sortiment.
Text: Jacqueline Vinzelberg

Extracremig 20 Prozent Joghurt verfeinern den saisonalen Früchtequark mit Apfel und Birne. Er hat einen hohen Fruchtanteil und enthält nur natürliche Aromen.
Quark Apfel Birne, 150 g* Fr. 1.35

Reinigt und pflegt Die flüssige Handseife mit Mandelblüten reinigt die Haut gründlich und macht sie zugleich seidenweich. Kneipp Flüssigseife Mandelblüten, Dispenser, 250 ml* Fr. 4.50
Unwiderstehlich.
Der cremige Katzensnack mit Rind enthält Inulin, das auf die Darmflora der Katze wirkt und ihr Wohlbefinden stärkt. Das Futter ist frei von künstlichen Aromastoffen.
Selina Cat Delight mit Rind, 7× 15 g*
Aktion
Fr. 1.50 statt 3.–
50% Rabatt auf das gesamte Selina-Katzenfuttersortiment vom 23. bis 29. 1.

Geschmack zum Streuen Mit der veganen Gemüsebouillon lässt sich vieles verfeinern. Die Würze ist frei von Konservierungsund geschmacksverstärkenden Zusatzstoffen.
Bon Chef Bouillon Streuer Gemüse, 90 g* Fr. 2.20


Asiatisch leicht Auch ohne Kochtalent gelingt dieser würzige Suppenklassiker der Thaiküche. Neu gibt es den grösseren Beutel für vier Portionen.
Bon Chef Tom-Kha Suppe, 100 g* Fr. 2.50

Gründliche Zahnpflege
Die Interdental-Microbürstchen reinigen Zahnzwischenräume mit Leichtigkeit. Sie sind besonders praktisch für unterwegs und mehrmals verwendbar.
Micro-Bürstchen-Set
ISO 0, 6 Stück* Fr. 3.95

«Ice Age» lässt grüssen Der Fruchtnektar aus Äpfeln, Orangen und Maracuja enthält acht Vitamine, aber keinen Zuckerzusatz.
Ice Age Tropic Fruits, Fruchtnektar, 6 × 200 ml Fr. 4.20
Komplett Bio
Die modische Kombination für kleine Ladys besteht aus Biobaumwolle. Eyecatcher sind die Spitzen bordüre des Kleidchens und die pinkfarbenen Leggins. Baby-Mädchen-Ensemble, pink, Gr. 68–98* Fr. 25.–
* in grösseren Filialen


Zum Wohl der Katze
Die Multivitamine können das Immunsystem von Stubentigern stärken. Biotin sorgt für ein glänzendes Fell, und Malz fördert den Abgang verschluckter Haare. Selina Multivitamin Paste, 100 g* Aktion
Fr. 1.45 statt 2.90
50% Rabatt auf das gesamte Selina-Katzenfuttersortiment vom 23. bis 29. 1.
Ihre Region
Neues aus der Genossenschaft
Migros Wallis


Angebote
Im Migros-Outlet in Eyholz ist das ganze Jahr über Ausverkauf. Auf alle Artikel von Kinderkleidern bis zu Fleischprodukten gibt es hohe Rabatte.
Text und Bilder: Denise Jeitziner

Die bunten Reisekoffer stehen nicht ohne Grund kurz vor dem Ausgang in der Nähe der Kassen: Hin und wieder kommt es vor, dass Kunden angesichts der stark reduzierten Preise im Migros- Outlet so begeistert zugreifen, dass die normalen Papiersäcke bei Weitem nicht ausreichen. Dem Mittvierziger, der sich nach einem blauen Koffer streckt, ist es heute offenbar so ergangen; sein Einkaufswagen ist fast bis oben gefüllt.
Überall im Geschäft sieht man Schilder, auf denen «1/4» steht. Ein Grossteil der Produkte kostet nur ein Viertel des ursprünglichen Preises, andere nur die Hälfte, und wer die Augen offen hält, entdeckt sogar Schnäppchen, die bis zu 90 Prozent reduziert sind. Neben wechselnden Angeboten finden die Kundinnen und Kunden im

Outlet zahlreiche Waren, die stets verfügbar sind, darunter Fleisch- und Milchprodukte und Kolonialwaren wie Süssigkeiten, Biskuits, Öl, Essig und Konservendosen.
Kleidung bis zu 75 Prozent günstiger Auch zahlreiche Non-Food-Artikel wie Reinigungsmittel und Frotteewäsche gibt es ganzjährig, genau wie Kleidung. Das ist besonders für Eltern lohnend, denn Kinderkleider kosten nur ein Viertel, Babykleidung die Hälfte des ursprünglichen Preises. Hier ist die Nachfrage mit am grössten. «Würden wir die Babykleidung auch mit 75 Prozent Rabatt anbieten, wären die Regale vermutlich ständig leer», sagt Philipp Hutter lächelnd. Seit vergangenem Oktober ist er der neue Geschäftsführer im Migros-Outlet in Eyholz. Im Vergleich


zu seiner vorherigen Stelle bei der Migros Brig unterscheidet sich Hutters Arbeitsalltag besonders beim Bestellen neuer Waren. Statt wie zuvor Nachschub einfach von der Zentrale anzufordern, ist Hutter im Outlet nun in Kontakt mit rund 30 Lieferanten, die vergünstigte Ware anbieten. Es handelt sich dabei um Überproduktionen, Liquidationen oder um Produkte, bei denen die Verpackung oder die Rezeptur geändert wurde, weswegen die Lieferanten sie dem Migros- Outlet günstig anbieten. Trifft die Offerte eines Lieferanten ein, muss Hutter entscheiden, ob er zuschlagen möchte oder nicht. Er muss abwägen, was bei der Kundschaft auf Interesse stossen könnte, und muss dabei schnell sein, denn er steht in Konkurrenz zu den übrigen Schweizer Outlets, die sich mit ihm
um die besten Produkte zu Schnäppchenpreisen reissen. So bleibt das Migros-Outlet immer auch eine abwechslungsreiche Wundertüte. Konstant hingegen sind die gewohnte Migros-Qualität und die Saisonalität. Aktuell können sich Oberwalliser Fasnächtler mit Artikeln wie Konfetti und Schminke eindecken. Warme Mützen passend zur Jahreszeit sind ebenfalls zu finden, aber auch Bikinis und Badekleider. Das Schnäppchenparadies liegt etwas versteckt neben der Hauptstrasse zwischen Eyholz und Visp, unweit des Kreisels bei der Abzweigung nach Lalden. Es gibt genügend Parkplätze, und die Postautohaltestelle ist in Gehdistanz. «Das Outlet ist vielen Oberwallisern noch wenig bekannt, dafür können wir auf eine treue Stammkundschaft zählen», sagt Hutter. MM
1 Das Outlet in Eyholz liegt zwar etwas versteckt, ist aber gut mit dem Auto oder dem Bus erreichbar.
2 Philipp Hutter aus Lalden führt seit Oktober das einzige MigrosOutlet im Oberwallis.
3 Rabatte, so weit das Auge reicht: Viele Artikel kosten nur ein Viertel des ursprünglichen Preises.
4+5 Auch Frischwaren wie Fleisch und Milchprodukte sind im Outlet ganzjährig zu finden.













Rindsentrecôte II, kg 35.–
,

Rindswurstfleisch, kg 9.–Schweins-Unterspälten, kg 11.30
Schweinsfrikassee, kg 5.40
Fleisch zum Trocknen 23.50 4 Stück zusammen, kg
Rindsstotzen: ca. 20 kg Fleisch 21.90 zum Trocknen + 5 kg Wurst eisch
Nuss ohne Deckel, kg 24.90
Unterspälte, kg
Mocken, kg





6.50
Schinken frisch ganz, kg


9.50

Schweinscarré ganz, mit Quasi, kg

7.30

Speck frisch kg
Zerlegen gratis nach Wunsch des Kunden in den Migros vom Simplon Center Glis, Visp, Sierre ville, Sion Métropole, Tourbillon Center Sion, Forum des Alpes Conthey, Martigny Manoir, Quartz Martigny, Fully, Monthey und Collombey. Als Geschenk die Gewürze zum Einsalzen.
Genossenschaft Migros Wallis



Schweizer Fleisch. Preisänderungen vorbehalten Halbes Schwein, ohne Innereien, kg 6.50




0.60 au lieu de 0.75 Espagne, la pièce



Take Away
Die Restaurants der Migros Wallis bieten neu auf der App «Gookers» Take-away-Mahlzeiten an. Die Kundinnen und Kunden können sie mit einem Klick bestellen und in nur wenigen Sekunden abholen.
Text: Mélanie Zuber Bild: Stéphane Gerber

Wer einen besonders arbeitsreichen Tag hat, für den ist die Mittagspause ein wichtiger Moment. Man würde gern etwas Feines essen, aber dabei keine Zeit verlieren. Geniessen, ja. Warten, nein. Hier kommt Gookers ins Spiel, eine von jungen Unternehmern entwickelte Applikation, die sehr einfach zu bedienen ist und ganz unserem Zeitgeist entspricht. Der Benutzer kann auf seinem Mobilgerät durch eine Foto-
serie von appetitlichen Snacks und Gerichten surfen, die von Restaurants und Partnerbäckereien zubereitet werden, und auswählen, was ihn gluschtet. Die Seite gibt an, in welcher Entfernung sich die Gerichte befinden und wie lange es dauert, bis sie zubereitet und abholbereit sind. Sobald die Wahl getroffen ist, kann bestellt werden. Um es noch einfacher zu machen, kann man auch direkt über die Applikation bezahlen. Danach kann das Gericht am entsprechenden Ort abgeholt werden. Auch hier ist alles schnell und praktisch: Gooker-Benutzer müssen nicht Schlange stehen, sondern werden in einer eigenen «Fast Lane» sofort bedient. Seit einigen Wochen bieten auch die Restaurants Migros Sitten Métropole und Siders Stadt einen Teil ihrer Gerichte auf der Applikation an, darunter zum Beispiel einen Hamburger nach Walliser Art, ein Thonsandwich oder eine Quiche Lorraine. MM















GENIESSEN & GEWINNEN











Bis zum 3. Februar 2018 Lieblingsmenus aus der Schweiz geniessen und mit etwas Glück ein Jahr gratis essen.

Pizokel
(Teigwaren mit Buchweizenmehl, Kartoffeln und Gemüse) Tagessalat Montag 22.1. GRAUBÜNDEN
12.80

Dienstag 23.1. BERN
Berner Platte
(Rindssiedfleisch, geräucherter Speck, Siedwurst, Schweins Nierstück)
Salzkartoffeln, Gedörrte Bohnen
15.50



Mittwoch 24.1. NEUENBURG
Pouletschnitzel
Blauschimmelkäse-Sauce
Trockenreis, Geschmorter Lattich

Donnerstag 25.1. TESSIN
Brasato (Rindsschmorbraten) Polenta, Glasierte rote Randen
14.50
+ 1.- Rote Trauben-Apfelschorle bio 5dl


Freitag 26.1. ZUG
Forellenfilet Zugerart
Reis mit Gemüsewürfeln Tagessalat
15.50

Samstag 27.1. WAADT
Papet vaudois Waadtländerwurst

13.50


13.50





Gültig bis am 3. Februar 2018








Silser-SchinkenSandwich
4.80



Auch auf der App erhältlich.
Schinkengipfel

2.50






























Für ein gutes Bauchgefühl.







































Von Savona nach Dubai
Diese grossartige Kreuzfahrt bringt Sie von Italien nach Dubai. Tauchen Sie ein in die faszinierende Welt des Orients und entdecken Sie Highlights ohne Ende – Jordanien mit dem Weltkulturerbe Petra, die atemberaubende Suezkanal Passage sowie die Destinationen auf der Arabischen Halbinsel, wo Sie die arabische Kultur geniessen werden. Dubai, das bekannteste arabische Emirat ist Endpunkt dieser wunderschönen Reise. Geniessen Sie dank unseren exklusiven Aktionspreisen eine unvergessliche Reise und kommen Sie an Bord mit onlinetours.ch.
Exklusive Aktionspreise
Preise pro Person bei 2er Belegung
Kategorie Aktionsbei 2 Personen preis
IC Innen Classic 1495.–
IP Innen Premium 1695.–
EC Aussen Classic* 1845.–
EP Aussen Premium 1995.–
BC Balkon Classic* 2195.–
BP Balkon Premium 2345.–
*Kabinen mit Sichteinschränkung
“Piu Gusto“ Getränkepaket 32.–pro Person/Nacht


Kabinen mit Balkon sensationell günstig!
Reisedaten und Programm
02.12.2018 bis 22.12.2018
So.02.12.18 Busfahrt nach Savona
Mo.03.12.18 Civitavecchia/Rom, Italien
Mi.05.12.18 Katakolon, Griechenland
Do.06.12.18 Piräus/Athen, Griechenland
Fr.07.12.18 Heraklion, Griechenland
Sa-So.Suezkanal08.-09.12.18 Passage
Mo.10.12.18 Akaba/Petra, Jordanien
Di.11.12.18 Eilath, Isarael
Mo.17.12.18 Salalah, Oman
Mi.19.12.18 Muscat, Oman
Do.20.12.18 Khasab, Oman

Nonstopflug mit Emirates inbegriffen!


21 Reisetage inkl. Vollpension an Bord An- und Rückreise ab nur CHF

Fr.21.12.18 Dubai, VAE
Sa.22.12.18 Dubai, VAE, Stadtrundfahrt, Rückflug mit Emirates nach Zürich
*nicht erwähnte Tage sind Seetage
Weihnachten in Dubai
4 Tage/3 Nächte im 4* Hotel im Doppelzimmer inkl. Frühstücksbuffet nur CHF 375.-
Sa.22.12.18 Stadtrundfahrt in Dubai, Transfer ins Hotel
So.23.12.18 Tag zur freien Verfügung
Mo.24.12.18 Tag zur freien Verfügung
Di. 25.12.18 Gegen Abend Rückflug mit Emirates nach Zürich
So viel ist inbegriffen: • Busanreise Schweiz–Savona • Erlebnis-Kreuzfahrt • 20 Nächte in der gewählten Kabinenkategorie • deutschsprachige Bordhostess • Vollpension an Bord, bis zu 5 Mahlzeiten täglich • Unterhaltungsprogramm • Stadtrundfahrt in Dubai • Direktflug mit Emirates nach Zürich.
Nicht inbegriffen: • Getränke und persönliche Auslagen • weitere Landausflüge • oblig. Serviceentgelt ( € 10,- p.P. Nacht), Annullationskostenversicherung • Reservationsgebühr Fr. 15.- pro Person.



Monica Müller (43) hat zwei Buben, einen Mann, einen Job, einen Haushalt. Mal wäre sie gern mehr Leitwölfin, mal mehr Gandhi.
1, 2 oder 3?
Der Grosse (7) und der Kleine (2) würden am liebsten im Pyjama durchs Leben lümmeln. Oder im Trainingsanzug. Entsprechend leger ist unser Dresscode: Nur wer rauswill, muss Hosen anziehen – es sei denn, er geht zum Sport. Nun steht ein Familienfest im feierlichen Rahmen an. Zu spät merke ich, dass das einzige Hemd im Schrank des Grossen zwei Nummern zu klein ist. Es gelingt mir zwar, ihn in das Karohemd zu zwängen, aber die beiden unteren Knöpfe müssen offen bleiben, und ein Hockey-T-Shirt schimmert durch. Dann klingelt es, der Nachbarsbub möchte noch etwas spielen. Uns bleibt eine halbe Stunde, also lasse ich den Grossen noch rausgehen. Als wir im Auto sitzen, merke ich, dass er vergessen hat, die Trainingshose wieder gegen die schöne Jeans auszuwechseln. Und der Kleine hockt auch plötzlich ohne sein Hemdchen da. Und jetzt?
1 Wir fahren nochmals zurück. Etwas Stil muss sein.
2 Ich nehme das Gel aus der Handtasche und verpasse ihnen im Auto eine rassige Frisur.
3 Ich kann gut damit leben: Kinder sollen Kinder sein dürfen.
Antwort 2: Ich halte wenig davon, Kinder in Anzüge zu stecken. Aber etwas Mühe geben darf man sich schon. Mit der schicken Frisur lenken wir elegant vom Outfit ab.
Umfrage
Welche Art
Spielwaren bevorzugen Sie?
Plastikspielzeug wie Lego oder Barbie gehen nicht kaputt und können einfach gereinigt werden. Top!
Basteln, rätseln, knobeln und gestalten: Spielen heisst bei uns kreativ sein.
Wir bevorzugen die guten alten Holzspielwaren und Naturmaterialien. Spielwaren müssen blinken, piepen, fliegen oder mit mir kommunizieren!
181 Abstimmende
Eine Umfrage von

Farben statt Ziffern: Im Schulhaus RotmontenGerhalde in St. Gallen dienen die Farben Braun, Orange, Grün und Gelb als Rückmeldung an die Schüler. Im Zeugnis gibts weiterhin Noten.
Hintergrund
Ab wann sind Noten sinnvoll?
Gemäss einer Umfrage des Informationsdienstes der Erziehungsdirektorenkonferenz im Jahr 2016 handhaben die Kantone die Frage sehr unterschiedlich. Viele Kantone erlauben Lernberichte ohne Noten in den ersten zwei bis vier Schuljahren, einige gar bis ins fünfte Schuljahr, teils im ersten Semester, teils zweimal pro Jahr. In einigen Kantonen wie BaselStadt, Solothurn und Tessin erhalten die Schülerinnen und Schüler sogar bis zur 9. Klasse Lernberichte ohne Noten.
Ein Notenzeugnis schreiben allerdings die meisten Kantone mindestens ein Mal pro Schuljahr vor. Ganz ohne Noten dürfen ausschliesslich Privatschulen arbeiten.
Diese erstellen stattdessen vielfach ausführliche Lernberichte und Portfolios.

Schüler wollen wissen, wo sie mit ihren Leistungen stehen. Braucht es dazu wirklich Noten? Eine Schule in St. Gallen geht neue, bunte Wege.
Text: Claudia Weiss Bilder: Stephan Bösch

Manchmal wissen die Schulkinder der 3. und 4. Klasse im Schulhaus Rotmonten-Gerhalde in St. Gallen in der Prüfung die Namen der Dinosaurier nicht mehr. Oder sie machen Fehler, wenn sie Rechnungen lösen müssen. Dann erhalten sie im Gegensatz zu anderen Schülern ihre Probe dennoch nicht mit einer Note drei zurück. Sondern mit einem Kreuz im braunen Feld und der Wortmeldung: «Das klappt noch nicht. Da brauche ich noch Unterstützung.» Das grüne Feld bedeutet «Das gelingt mir teilweise», das orangefarbene «Das kann ich schon gut» und das gelbe «Das beherrsche ich».
Schulhausleiter Oliver Rohner (46) sagt: «Wir wollen den Schülerinnen und Schülern während des Schuljahrs nicht einfach eine Zahl für ungenügend vorlegen, sondern sie
ermuntern, noch besser zu lernen.» Braun, Grün, Orange und Gelb stehen für die Farben der Sonnenblume, die alle Schulkinder am Anfang des Schuljahrs erhalten, und für deren Wachstum.
Schulnoten haben sich bisher durchgesetzt Der Versuch schlägt Wellen über die Schweizer Grenzen hinaus: Er wurde unter anderem vom deutschen Magazin «Der Spiegel» aufgegriffen. Immer wieder sorgt das Thema «Noten in der Schule» für Emotionen. Jürgen Oelkers (70), emeritierter Professor am Institut für Erziehungswissenschaft der Universität Zürich, beschäftigt sich seit Langem damit. Für ihn ist klar: «In einer Gesellschaft, die Leistung verlangt, sind Noten wichtig.» Zwar könne man die Gerechtigkeit von Noten, so wie sie heute eingesetzt wer-
den, anzweifeln. Aber statt Noten abzuschaffen, sei es wichtig, diese transparent und fair zu verteilen, findet Oelkers. Denn bisher habe sich keine der zahlreichen getesteten Alternativen durchsetzen können: «Die Schüler wollen wissen, wo sie stehen – und ihre Eltern auch.»
Winfried Kronig (49), Professor für Sonderpädagogik an der Universität Freiburg und Mitglied im Rat des Eidgenössischen Hochschulinstituts für Berufsbildung, stimmt ihm darin zu, dass es noch keine Ideallösung gibt. Als Notenkritiker sagt er aber: «Die Schule qualifiziert nicht nur, sie selektioniert auch. Und das nicht immer gerecht.» Das könne dazu führen, dass ein eigentlich mässig guter Schüler in einer leistungsschwachen Klasse als Spitzenschüler gelte, obwohl er weit weniger wisse

Bis Fr. 500.–Rabatt



Die klassische Rheinstrecke zwischen Basel und Amsterdam wird Sie begeistern. Eine kurze Anreise und das Schiff MS Carmen zum Aktionspreis. Geniessen Sie den romantischen Rhein mit seinen Burgen, Schlössern und Ruinen.
Tag 1 Schweiz > Basel
Busanreise nach Basel.
Tag 2 Strassburg
Bootsfahrt auf dem Flüsschen Ill*. Nachmittags Freizeit für eigene Unternehmungen.
Tag 3 Bonn > (Königswinter)
Stadtrundfahrt Bonn (Fr. 20) oder Ausflug zum neoromantischen Schloss Drachenburg (Fr. 30).
Tag 4 Dordrecht > Rotterdam
Morgens Ausflug zu den Windmühlen in Kinderdijk*.
Am Nachmittag erreicht Ihr Schiff Rotterdam. Kombinierte Stadt- und Hafenrundfahrt* Rotterdam.
Tag 5 Amsterdam
Ausflug zum Keukenhof*. Am Nachmittag erleben Sie die lebendig-junge Stadt aus der Perspektive zahlloser Kanäle auf einer Grachtenfahrt*.
Tag 6 Düsseldorf
Stadtrundfahrt Düsseldorf mit typisch-rheinischer Bierverkostung*.
Tag 7 Rüdesheim
Fahrt mit dem Winzerexpress* in Rüdesheim und anschliessend Zeit zur freien Verfügung.
Tag 8 (Baden-Baden) > Strassburg Stadtrundgang* in Baden-Baden.
Tag 9 Basel > Schweiz Busrückreise zu Ihrem Abreiseort.
* Ausflugspaket
Die MS Carmen**** ist modern und luxuriös eingerichtet. Die Kabinen auf Oberdeck verfügen über französische Balkone, Kabinen auf dem Mitteldeck mit zu öffnenden Fenstern und Kabinen auf dem Haupt/- und Unterdeck mit nicht zu öffnenden Fenstern. In allen Kabinen sind WC/Dusche, Klimaanlage, Föhn, Safe und Stromanschluss 220 V vorhanden. Die MS Carmen besticht durch ihr überdurchschnittliches Angebot an Einzelkabinen. Willkommen an Bord!
Reisedaten 2018 05.04.–13.04., 13.04.–21.04., 21.04.–29.04., 29.04.–07.05., 07.05.–15.05., 15.05.–23.05., 23.05.–31.05., 31.05.–08.06., 08.06.–16.06.
Preise pro Person Fr Kabinentyp Katalogpreis Aktionspreis Einzelkabine, Unterdeck 1495.– 995.–2-Bett-Kabine, Hauptdeck Panoramafenster 1755.– 1255.–2-Bett-Kabine, Mitteldeck Panoramafenster 2055.– 1555.–Junior Suite, Mitteldeck Panoramafenster 2195.– 1695.–2-Bett-Kabine, Oberdeck frz. Balkon 2395.– 1895.–Aktionspreis mit beschränkter Verfügbarkeit
Bus zum Fluss Romantischer Rhein Exklusive Landausflüge Mittelthurgau-Reiseleitung
Zuschläge
• Reise 13.04., 21.04., 29.04., 07.05. 95.–
• Alleinbenützung Haupt-/Mitteldeck 395.–
• Alleinbenützung Oberdeck 995.–Wählen Sie Ihre Ausflüge
• Ausflugspaket 8 Ausflüge (bis 07.05.) 206.–
• Ausflugspaket 8 Ausflüge (ab 15.05.) 202.–Unsere Leistungen
• An-/Rückreise im Komfort-Reisebus
• Mittelthurgau Fluss-Plus: Busbegleitung während der ganzen Reise
• Flussreise mit Vollpension an Bord
• Mittelthurgau-Reiseleitung Nicht inbegriffen
• Auftragspauschale pro Person Fr. 20.–
• Persönliche Auslagen, Getränke, Trinkgelder
• Kombinierte Annullationskosten- und Extrarückreiseversicherung auf Anfrage
• Sitzplatz-Reservation Car 1.–3. Reihe
Was Sie noch wissen müssen
Schweizer Bürger benötigen eine gültige Identitätskarte oder einen gültigen Reisepass. Abreise 15.05., 23.05., 31.05., 08.06.: Ausflug Zaanse Schans anstatt Keukenhof Wählen Sie Ihren Abreiseort
12:40 Wil p, 13:00 Burgdorf p 13:05 Wiesendangen, 13:30 Zürich-Flughafen p 13:30 Aarau SBB, 14:30 Baden-Rütihof p 15:15 Pratteln p, 15:35 Basel SBB
Internet Buchungscode
fcmbas1 www.mittelthurgau.ch
als der Spitzenschüler einer leistungsstarken Klasse im Dorf nebenan. Zum Farbkonzept sagt er: «Letztlich ist das eine Reform, die nur kosmetisch auf der Oberfläche stattfindet.»
Weg vom Konkurrenzdenken
In der Schule RotmontenGerhalde bleiben die Verantwortlichen dennoch dabei: «Wir möchten den Kindern eine andere Haltung beibringen als das permanente Vergleichen und das Konkurrenzdenken», sagt Schulhausleiter Rohner. Das Farbsystem sei kompetenzorientiert und auf Förderung ausgelegt, wie das der Kanton St. Gallen mit dem neuen Lehrplan fordere.
Auch die meisten Lehrkräfte stehen dahinter. Allen voran Oliver Rohner, der das System als Erster in seiner Klasse eingeführt hat. Er ist überzeugt, dass sein System positiver daherkommt als nackte Zahlen. Und auch besser als Smileys: «Farben sind neutral», findet er, «bei den Smileys wirkt ein trauriges Gesicht auf Anhieb negativ.»
Ganz wichtig sei: Die Farben stehen gekoppelt mit einem Kommentar da. «Das ergibt eine abgerundete Rückmeldung, mit der die Schülerinnen und Schüler wirklich etwas anfangen können», ist Rohner überzeugt. Und die bisherigen Reaktionen von Eltern, Schülerinnen und Schülern geben ihm recht. Sogar die Notenzeugnisse, die nach dem St. Galler Schulgesetz zweimal jährlich abgegeben werden müssen, hätten bei den Schulkindern keine grosse Aufregung ausgelöst: «Auch ohne Noten wussten sie schon vorher, wo sie standen», erklärt der Lehrer.
Ressourcen statt Defizite fördern Bildungsforscher sind dennoch von den Farben nicht restlos überzeugt. «Kinder merken sehr schnell, dass Braun schlechter ist als Gelb, oder sie übersetzen die Farben insgeheim ins alte Notensystem», sagt Winfried Kronig. Eine ideale Lösung kann auch er nicht anbieten, meint aber: «Grundsätzlich ist es eine gute Idee, Ressourcen statt Defizite zu fördern.» Jürgen Oelkers

Gelb ist gut: Ergänzend zum gelben Streifen bekommt dieser Schüler in einem Satz eine Präzisierung zur Beurteilung.
hingegen sagt: «Manchmal ist es gar nicht so schlecht, Noten als Ansporn von aussen anzuwenden. Denn Eigenmotivation ist zwar ein schönes Wort, funktioniert aber nicht immer so einfach.»
Wer in der öffentlichen Schule ist, muss sich mit einem Schulsystem abfinden, das letztlich trotz allem eher selektioniert statt fördert. Urs Moser (60), Geschäftsleiter am Institut für Bildungsforschung der Uni Zürich, erklärt warum sich das System so hartnäckig hält, damit, dass unsere Gesellschaft mit ihrem Leistungszwang gar keine andere Möglichkeit erlaube (siehe Interview Seite 83).
Das sieht Luca D’Alessandro (39) anders. Der Sprecher des Dachverbands der Gesundheitsberufe Odasanté sagt: «Für den Zugang zu einer Lehrstelle im Gesundheitsbereich – etwa Fachmann oder Fachfrau Gesundheit – ist der Abschluss der obligatorischen Schulzeit Vor-
So geht es auch Alternative Schulen
Viele private Schulen in der Schweiz funktionieren ohne Noten, ohne fixen Stundenplan und ohne Klasseneinteilung: Die Schülerinnen und Schüler wählen ihre Lernziele selber, die Lehrerinnen und Lehrer stehen ihnen als Coaches zur Seite. www.schulen-der-zukunft.org
Die ältesten und bekanntesten alternativen Schulen sind die Rudolf- Steiner-Schulen und die Mon tessori-Schulen. Viele öffentliche Schulen übernehmen einige Ideen in den Schulalltag.
Besonders die sogenannten Mosaik- Sekundarschulen arbeiten mit alters- und stufendurchmischten Klassen und motivieren die Schulkinder zu eigenen Lernprojekten. Der Name «Mosaik» setzt sich zusammen aus: «Mo» – Motivation; «S» – Selbständigkeit; «A» – Altersdurchmischtes Lernen; «I» – Individualität; «K» – Kurssystem www.mosaiksekundarschulen.ch
aussetzung.» Schülerinnen und Schüler von privaten Schulen müssten zwar belegen können, dass ihr Schulwissen mit dem der Volksschule vergleichbar ist. Ob dieser Nachweis über ein Schulabschlusszeugnis oder via Aufnahmegespräch oder Einstufungstest laufe, ist allerdings nicht vorgeschrieben. «Der Entscheid über die Aufnahme in die Lehre obliegt dem Lehrbetrieb.» Auch Schreiner wählen nicht nur nach Zeugnisnoten aus, sondern wollen ihre künftigen Lernenden in einer Schnupperlehre gründlich kennenlernen, sagt Daniel Zybach (43), Bereichsleiter Berufsbildung beim Verband Schweizerischer Schreinermeister. «Nicht wenige Unternehmen schliessen diese Schnupperlehre mit einem Test ab. Dieser soll aufzeigen, ob Jugendliche das Rüstzeug für die anspruchsvolle Schreinerlehre mitbringen.» Das gehe weit über das reine Abfragen von Wissen hinaus. Das Schulzeugnis, so Zybach, spiele zwar
Meinungen zum Thema auf den Seiten 82 und 83 bei der Vergabe der Schnupperwochen eine Rolle. «Wir suchen aber in erster Linie Hinweise auf Durchhaltevermögen und Konzentrationsfähigkeit eines Kandidaten oder einer Kandidatin.»
Zeugnisse sind nicht so wichtig Die Schülerinnen und Schüler der 3. Klasse im Schulhaus Gerhalde finden ihr Farbsystem in Ordnung und zeigen das begeistert mit orangen und gelben Zetteln, die sie auf die entsprechende Frage von Oliver Rohner in die Luft strecken. Ob sich die Farben und Rückmeldungen in dieser Form durchsetzen werden, wird sich zeigen. Für Oliver Rohner aber ist klar, dass sich die Auseinandersetzung mit dem Thema «Lernfördernde Beurteilung» lohnt und solche Ansätze Schritte in die richtige Richtung sind. MM
Umfrage

Nils Büchler (9)
«Ich habe Glück, und alle Kreuze sind im allerbesten Feld, dem gelben, das macht Freude. Ich hatte auch schon Noten, aber Farben sind mir lieber; sie sind schöner, und ich weiss genau, wie gut ich bin. Ich gebe mir immer Mühe, dass ich im Gelben oder Orangen bleibe.»

Zoé Meile (8)
«Zuerst konnte ich mir das mit den Farben nicht vorstellen, aber jetzt finde ich es viel besser als Noten. Man darf sich selber einschätzen, und Herr Rohner sagt uns dann, ob er das auch so sieht. Toll ist, dass ich auf einen Blick sehe, wie gut ich bin.»




Florian Dlaska (8)
«Die Farben drücken aus, wo ich stehe. Für mich sind sie sogar klarer als eine Beurteilung in Textform. Noten, wie wir sie im Jahreszeugnis haben, finde ich auch okay, aber die Farben sind besser. Ich kann mir mit ihnen auf einen Blick ein gutes Bild davon machen, wo ich stehe.»

Luis Moser (8)
«Braun bedeutet ja eigentlich eine Drei. Aber ich habe das Gefühl, man schafft es leichter, von Braun ins Grüne zu kommen, als von einer Drei aus genügend zu werden. Heute habe ich mir in der Selbstbeurteilung ein Orange gegeben, das wäre etwa eine Fünf.»














































Farben statt Noten: Ist das sinnvoll?
Die Farben machen die Rückmeldung freundlicher. Zusätzliche Wortrückmeldungen präzisieren die Beurteilung. Das eigentliche Problem wird damit kaum gelöst: Die Bewertung zeigt den Leistungsvergleich innerhalb einer Klasse, sagt aber wenig über den Lernerfolg des einzelnen Kindes aus.
Der Versuch, Noten zu ersetzen, ist aber sinnvoll?
Diese Idee flackert seit Jahrzehnten regelmässig auf. Eine gute Lösung wurde bis anhin nicht gefunden. Das grundlegende Problem: Schulen müssen selektio
nieren und fördern so die Leistungsorientierung. Die Schule entscheidet über Schullaufbahnen, darum muss das Beurteilungssystem auch auf sozialen Vergleich ausgerichtet sein.
Und dafür eignen sich Farben nicht?
Egal ob Farben, Worte oder Ziffern: Solange wir eine selektive Leistungsschule haben, befindet sich die Schule im Spannungsfeld zwischen Fördern und Selektionieren.
Wer will Bewertungen: Schüler, Eltern, höhere Schulen, Lehrmeister?
Alle. Rückmeldungen zum Lernen sind für den Lern
erfolg zentral. Zumindest in der Unterstufe ist der Vergleich mit Mitschülern jedoch nicht zwingend. Dort hat eine Note noch wenig Bedeutung, man kann den Schonraum ausnutzen. Auch später könnte man auf Noten verzichten, die auf den sozialen Vergleich ausgerichtet sind – falls alle höheren Schulen Eintrittsprüfungen machen.
Sind Eintrittsprüfungen gerechter als Zeugnisse?
Eine Prüfung ist eine Momentaufnahme und sagt nichts über die Entwicklung aus. Beim Übertritt in die berufliche Grundbildung sind Noten nicht allein entscheidend. Auch Ergebnisse
von Eignungstests und Berichte von Schnuppertagen sind relevant.
Was wäre sinnvoll?
Die Beurteilung sollte sich auf den LehrLernProzess beziehen, sodass die Schüler mitdenken und überlegen, was sie können und wie sie lernen.
Die ideale Beurteilung?
Sie sollte sich an inhaltlichen Zielen ausrichten. Beim Übertritt in eine höhere Schulstufe sollten Rückmeldungen von Eltern, Selbstbeurteilung der Schüler und Ergebnisse aus externen Vergleichstests oder Prüfungen einfliessen. MM

Urs Moser (60) ist Geschäftsleiter am Institut für Bildungsforschung der Universität Zürich. Er beschäftigt sich mit Evaluationsforschung im Bildungsbereich und international vergleichender Leistungsmessung.
Anzeige





Erhältlich in grösseren Migros-Filialen. Bei diesem Angebot sind bereits reduzierte Artikel ausgenommen.





















































Wir freuen uns ausserordentlich. Sie – unsere Kundinnen und Kunden –haben gemeinsam über 2,2 Millionen Franken gespendet. Sie tragen so dazu bei, dass weniger Menschen in der Schweiz mit ihren Sorgen und Nöten alleingelassen werden. Wir haben unseren Beitrag geleistet und die erreichte Spendensumme um 1 Million Franken erhöht. Die Spenden kommen vollumfänglich den Hilfswerken zugute:



Lisa Stutz
Sag mir, was du isst, und ich sag dir, wo du bist. Oder so ähnlich. Mir ist aufgefallen, dass ich in der Stadt andere Gerichte esse als auf dem Land. Eine Liste.
Auf dem Land esse ich: Coupe Dänemark. Mamis Omelettechueche (gestapelte Omeletten, dazwischen Hackfleisch). Toast Hawaii. Hot Dogs, die nur drei Zutaten enthalten: Wienerli, Baguettebrot, Ketchup. Grosis Braten mit selbstgemachten Spätzli. Milchreis. Rindfleisch auf heissem Stein, donnerstags zum halben Preis. Fotzelschnitte. Fleischkäsesandwich. Penne Cinque Pi – Pomodoro, Parmigiano, Panna, Petersilie, Pfeffer. Fitnessteller. Nussravioli im «Bären». Zürcher Geschnetzeltes im «Rössli». Cordon bleu im «Gürber». Fondue im «Berghüsli». Fleischvögel. Öpfelchüechli mit Vanillecreme. Pommes frites in der Mehrzweckhalle. Bananensplit.
In der Stadt esse ich: indische Samosas an der Langstrasse. GreenDragoninsideout Sushi bei «Yooji’s». Randenmousse mit Walnüssen. RohschinkenRucolaPanini. AvocadoWrap im Globus. NutellaBrownies. «Leck mich» Glace. Mohnkuchen in «Babu’ s Bakery and Coffeehouse». Kichererbsensalat. In Hummus getunkte Falafel. Dönerbox. Blueberrypancakes mit Maplesirup. Pizza Michelangelo am Sechseläutenplatz. SüsskartoffelKürbis Suppe to go. Luxemburgerli. Zitronenravioli mit Pinienkernen. «The Beauty and the Cheese»Hamburger. Salbeignocchi. Ziegenkäsecigarillos. Fried Rice. RoastbeefBagel. Porridge mit getrockneten Cranberries.
Hier zeigt sich sozusagen der Röstigraben zwischen Stadt und Land. Mmh, Rösti! ... MM
Anzeige









Das starke Winter-Duo von Similasan





Rabatt beim Kauf einer Packung Similasan Echinacea plus Sticks oder Similasan Ferrum phosphoricum plus Sticks. Gültig bis 31. März 2018 in Ihrer Apotheke oder Drogerie.


Gemäss homöopathischem Arzneimittelbild eignen sich die Wirkstoffe zur Vorbeugung von Grippe und Erkältung.

Gemäss homöopathischem Arzneimittelbild eignen sich die Wirkstoffe zur Therapie von Grippe und Erkältung.
Information für den Fachhandel: Bitte Bon mit Kassenbeleg aufbewahren. Wird durch den Aussendienst der Firma Similasan AG vergütet.
Dies sind zugelassene Arzneimittel. Bitte lassen Sie sich beraten. Similasan AG
Selbsthilfe Nacken in Not? Das entspannt
Wer viel vor dem Bildschirm sitzt, kennt das Problem: Der Nacken schmerzt. Mit Polarity kann man sich auch gut selber behandeln, wie Therapeutin
Sunahla Sthioul zeigt: «Reiben Sie die Handflächen etwa eine Minute fest gegeneinander. Fühlen Sie das Energiefeld?
Legen Sie nun die linke Hand auf den Nacken, die rechte unterhalb des Halses auf Schlüsselbeinhöhe. Atmen Sie dabei tief ein und aus. Der Nacken fühlt sich dabei sofort besser an.»
Buchtipp: «Richtig fasten, gesund essen» von Raphael Schenker, erhältlich auf exlibris.ch für Fr. 24.70
Yoga bringt Körper, Geist und Seele in Einklang. Welche Yoga-Formen es gibt und welche sich wozu eignen, erfahren Sie auf www.migros-impuls. ch/de/yoga

iMpuls ist die neue Gesundheitsinitiative der Migros.

Verspannter Nacken?
Polarity-Therapeutin
Sunahla Sthioul zeigt, wie man die Blockade löst. Wie es genau geht, lesen Sie in der Spalte links.
Erschöpft, antriebslos und ohne Motivation – die «Batterien» von Andreas Müller waren leer. Der 58-jährige Mathematikdozent litt an einem Burn-out. Dank Polarity fand er zurück ins Leben.
Text: Inge Hess Bilder: Franziska Frutiger
Polarity ist eine Komplementärtherapie, die westliche Medizin und fernöstliche Heilkünste vereint. Entwickelt wurde Polarity vom US-Arzt Randolph Stone (1890–1981).
Der Chiropraktiker, Osteopath, Natur- und Nervenheilkundler erweiterte seine Fachgebiete durch Erkenntnisse aus dem indischen Ayurveda und der Traditionellen Chinesischen Medizin (TCM).
Das Ergebnis seiner Studien waren Karten über energetische Zusammenhänge im menschlichen Körper. Sie zeigen das Fliessen der Energieströme zwischen zwei Polen auf – daher der Name «Polarity». Stone fasste seine Resultate so zusammen: «Es sollte das vordringlichste Ansinnen der Heilkunst sein, den Lebensstrom durch blockierte Körperbereiche und schmerzende Gewebe hindurch wieder ins Fliessen zu bringen.»
Die fünf Säulen
«Die moderne Polarity-Therapie beruht auf fünf Säulen: Achtsamkeit, Körperarbeit, Gespräch, ausgewählten Yoga-Praktiken sowie Ernährung und Heilfasten», erklärt Polarity-Verbandspräsident Raphael Schenker. Die Behandlung hilft bei chronischen Schmerzen genauso wie bei Herz- und Blutdruckproblemen, Verdauungsstörungen, Kopf- und Rückenschmerzen, begleitend nach Unfällen und Operationen, aber auch bei psychischen Leiden wie Depressionen, Burn-out, Prüfungsängsten und Schicksalsschlägen.
Bei Andreas Müller* zeigten sich erste Anzeichen eines Burn-outs 2008. «Die Symptome begannen schleichend. Ich war chronisch müde, konnte immer weniger nach der Arbeit abschalten und mich nicht mehr regenerieren.»
* Name der Redaktion bekannt

Einfühlung und Achtsamkeit sind Sunahla Sthioul bei der Behandlung wichtig.
Die Anforderungen an der Fachhochschule und die Versorgung seiner Familie gingen dem Vater von zwei Töchtern an die Substanz. «Ich nahm meine Bedürfnisse kaum mehr wahr.» 2010 schrieb ihn sein Arzt krank. «Da war mir klar, dass ich aktiv werden musste.»
Atem- und Energieübungen
Andreas Müller suchte die Polarity-Therapeutin Sunahla Sthioul auf. Die 52-Jährige beginnt die Behandlung jeweils mit einem einleitenden Gespräch und einer Atemübung. «Der Klient liegt auf der Liege und ich lade ihn ein, seinen Atem bewusst wahrzunehmen. Eine Reihe einfacher Übungen nimmt jeweils fünf Minuten in
Anspruch, die Klienten fühlen sich danach gleich viel besser.» Dann beginnt die eigentliche Körper- und Energiearbeit.
«Polarity hat eine sehr hohe Wirksamkeit dadurch, dass verschiedene Wahrnehmungsebenen miteinbezogen werden. Wir arbeiten bewusst mit der Wechselwirkung von Körper, Seele und Geist», erklärt die Therapeutin. Das fortlaufende Gespräch fördert den Bewusstseinsprozess und hilft, festgefahrene Verhaltensweisen zu ändern.
Sthioul motivierte Müller unter anderem dazu, seiner Leidenschaft für das Zeichnen und Malen wieder mehr Zeit zu widmen. «Dadurch kam ich auf die Idee, die lange Bahnfahrt zu meinem Arbeitsplatz zu nutzen. Durch das Zeichnen im Zug lernte ich neue Menschen kennen und wurde viel kontaktfreudiger, was sich auch auf meinen Unterricht ausgewirkt hat.» Müller bekam wieder Energie und Lebensfreude. «Meine Sichtweise auf mein Verhalten und mein Leben hat sich geändert, und ich bin wieder mehr in Kontakt mit meinen Ressourcen gekommen. Heute habe ich ein Atelier, und meine Bilder hängen in einer Ausstellung.»
Eidgenössisch anerkannt
Polarity wird seit rund 35 Jahren in der Schweiz praktiziert. Ein Grossteil der Behandlungskosten wird über die Zusatzversicherung rückvergütet. Seit 2016 kann man das eidgenössische Diplom als PolarityKomplementärtherapeut machen.
Andreas Müller ist seit 2011 sein Burn-out los. «Ich fühle mich heute gut und sehe alles viel positiver. Zudem spüre ich Anzeichen von Erschöpfung viel schneller und kann darauf reagieren, indem ich zum Beispiel eine Polarity-Behandlung buche.» MM
Mehr Infos: www.polarity-schweiz.ch

8 Tage ab Fr.
Direktflug mit Swiss & Twerenbold-Bus vor Ort Königsklasse-Luxusbus mit 90cm Sitzabstand Kleine Gruppen, max. 30 Personen
Ihr Reiseprogramm
1. Tag: Hinflug Zürich–Dublin. Individuelle Anreise zum Flughafen Zürich und Direktflug mit Swiss nach Dublin. Geführte Stadtbesichtigung.
2. Tag: Dublin–Region Galway. Wir fahren Richtung Westen nach Galway. Unterwegs besichtigen wir Clonmacnoise. Das Kloster war in seiner wechselhaften Geschichte immer wieder Ziel von Angriffen. Am Abend erreichen wir die Region Galway.
3. Tag: Galway, fakultativer Ausflug Connemara.
Heute entdecken wir die wildromantischen Landschaften von Connemara. Unterwegs besichtigen wir u.a. die Kylemore Abtei.
4. Tag: Galway–Cliffs of Moher–Tralee. Fahrt durch das Burren Gebiet zu den Cliffs of Moher. Burren heisst «riesiger Stein», was die eindrucksvolle, karge Region treffend beschreibt. Abends Ankunft in Tralee.
5. Tag: Tralee, Ausflug Ring of Kerry. Die Panoramafahrt um den Ring of Kerry ist ein Höhepunkt unserer Reise. Fahrt entlang der Küste und weiter durch den landschaftlich reizvollen Killarney Nationalpark. Wir besuchen eine Schaffarm und die weltweit für ihre Schönheit bekannten Gärten des Muckross House.
6. Tag: Tralee–Dingle Halbinsel–Charleville. Die Dingle Halbinsel ist der nördlichste der fünf Finger im Westen Irlands. Die Halbinsel ist nicht nur von farbenprächtiger Schönheit, sondern auch aussergewöhnlich reich an frühchristlichen Hinterlassenschaften. Wir reisen weiter bis nach Charleville
7. Tag: Charleville–Cashel–Clane.
Auf dem Weg Richtung Dublin besichtigen wir den Rock of Cashel. 60 Meter hoch über der Ebene auf einem Kalksteinfelsen erhebt sich eine der kirchen- und kunsthistorisch bedeutsamsten Sehenswürdigkeiten Irlands. Im Anschluss besuchen wir das Ballyowen House
8. Tag: Rückflug Dublin–Schweiz. Rückflug nach Zürich und individuelle Heimreise.
Ihre Hotels
Auf dieser Reise haben wir für Sie folgende oder gleichwertige Hotels reserviert:
Reisedaten 2018 (So – So)
1: 03.06.–10.06. 6: 15.07.–22.07. 2: 17.06.–24.06. 7: 22.07.–29.07. 3: 24.06.–01.07. 8: 29.07.–05.08. 4: 01.07.–08.07. 9: 05.08.–12.08. 5: 08.07.–15.07.
Unsere Leistungen
·Flug mit Swiss in Economy-Klasse
·Alle Flugnebenkosten (Wert Fr. 102.50)
·Fahrt mit Königsklasse-Luxusbus ab/bis Dublin –Flughafentransfer und Stadtrundfahrt Dublin mit lokalem Komfortklasse-Bus
·Unterkunft in Mittel- bis Erstklasshotels
·7 x Halbpension in den Hotels
·Ausflüge, Eintritte, Besichtigungen gem. Programm (ausg. fak. Ausflug, 3. Tag)
·Deutschsprechende Lokalreiseleitung während der ganzen Reise (3. Tag fak.)
Pro Person im DZ Katalog-Preis* Sofort-Preis
8 Tage inklusive Halbpension 2215 1995 Einzelzimmerzuschlag 260
Reduktion Reise 1 – 100 Nicht inbegriffen
Fakultativer Ausflug Connemara 65
Annullierungskosten- & Assistance-Versicherung 79
So fliegen Sie
Direktflug mit Swiss Zürich–Dublin–Zürich in Economy-Klasse. Reisedauer pro Weg 2h 15min.

Und wie immer bei allen Reisen: Audio-System auf Rundgängen, Erfahrener Reisechauffeur ab/bis Dublin Auftragspauschale von Fr. 20.– entfällt bei Online-Buchung
* KATALOG-PREIS: Zuschlag 10% auf den Sofort-Preis, bei starker Nachfrage und 1 Monat vor Abreise.

Jeannette Schaller ist
Leiterin Finanzplanung bei der Migros Bank.
Migros Bank
Wollen Sie sichergehen, dass Sie nach der Pensionierung Ihren gewohnten Lebensstandard aufrechterhalten können? Je nach Alter gibt es unterschiedliche Fragen zu klären. Wer zum Beispiel mit 50 Jahren oder noch früher auf die Pensionierung blickt, befasst sich am besten mit der alles entscheidenden Frage: Wird das Geld für einen angenehmen Ruhestand reichen? Falls die Antwort Nein ist, spricht man von einer Vorsorgelücke. Eine 50jährige Person kann das durch drei Massnahmen korrigieren:
1. Berufstätigkeit verlängern
Das ordentliche Rentenalter liegt in der Schweiz bei 64 Jahren für Frauen und bei 65 für Männer, doch das System ist flexibel: Frühpensionierungen sind ab 58 möglich, andererseits lässt sich der Ruhestand aber auch um bis zu fünf Jahre aufschieben.
Für eine 50jährige Person verbleiben somit je nach Geschlecht bis zu 19 beziehungsweise 20 Jahre, um AHV und Pensionskasse zu äufnen.
2. Einkommen steigern
So, wie man in den letzten Arbeitsjahren das Arbeitspensum reduzieren oder auf die bisherige Führungsfunk
Orselina ob Locar no: Ferien2-Zi-Whg, Wohnküche, ruhig, Terrasse + Balkon, Panoramasicht, Fr 65-74.- 044 941 32 81
3*, 4* o. 5* Hotels in Bad Wörishofen, Kleinwalsertal, Oberstdorf, Fischen, Füssen, Oberstaufen, incl. Hin- u. Rückfahrt im 9-Sitzer Pkw ab/zur Haustür, z.B. 7 Tage inkl. HP für nur 579,- € Fordern Sie heute noch unverbindlich Ihren Katalog an 0049 / 8376 / 929272 Seniorenausflug Keller GmbH, Alpenblickstr. 17, D-87477 Sulzberg im schönen Allgäu

Legenden gross 9.45pt (252_ LT_stumpf_QS_x08 (Endbetrag in CHF während Anzahl Jahren)
Wer bei einem Jahreseinkommen von 80 000 Franken jährlich 5 Prozent spart, hat nach 15 Jahren 60 000 Franken zur Verfügung (ohne Zinseszinseffekte).
Sparquote 5%
Sparquote 10%
Sparquote 20%
Quelle: Migros Bank
tion verzichten kann, ist auch das Gegenteil möglich: Man macht einen Karriereschritt mit Lohnerhöhung oder fährt das Pensum hoch. Das hat einen grossen Einfluss auf Budget und Altersvorsorge.
3. Sparen
Wenn Sie neben dem obligatorischen Sparen (AHV und bei einer Anstel
3. Februar bis 12. März 2018 7 Nächte HP im Doppelzimmer Standard ab CHF 805.00 pro Person Einzelzimmerzuschlag CHF 10.00 pro Tag
Unsere Leistungen: ❆ WillkommensAperitif ❆ reichhaltiges Frühstücksbuffet ❆ 4-Gang Abendessen mit Wahl des Hauptgangs ❆ 1 grosses HO TE L PONT RE SI NASpezialitätenbuffet ❆ gratis Abholdienst vom Bahnhof Pontresina (08:00 – 18:00) ÖV (Bus / RhB) im Oberengadin Gratis

lung zudem BVG) auch privat sparen, können Sie in die steuerlich besonders attraktive Säule 3a (gebundene Vorsorge) einzahlen, sich zusätzlich in die zweite Säule (BVG) einkaufen oder in der Säule 3b frei sparen –beispielsweise mit einem Sparkonto oder mit Wertpapieranlagen. MM
Mehr zum Thema: blog.migrosbank.ch
Thermalkuren & Zahnarzt-Besuch 9 Tage – wöchentl. Fahrten – immer Sa. bis So. Im 3*/4*Hotel Verlangen Sie Unterlagen info@bus-trip-reisen.ch 078 796 52 25




Fahren Sieein Jahr lang gratisAutobahn! Jahres wechselist Vignet tenwechsel!

Eiskeim (z.B. Stauboder Russpartikel)
Schneeflocken sind hauchdünn und fein. Und bei genauerer Betrachtung zeigt sich, wie formvollendet und speziell jede einzelne ist.
Text: Yvette Hettinger Illustration: Jan Kruse
Beim Heranwachsen eines Eiskristalls können sich Arme an den Ecken bilden.
Wenn Wassermoleküle sich anlagern, entsteht ein sechseckiges Plättchen.
Wie entsteht eine Schneeflocke?
Eine einzelne Flocke besteht aus vielen Schneekristallen. Ein Schneekristall entsteht, wenn sich in kalter Luft (etwa zwischen –4 und –20 Grad) Wasserdampf oder unterkühltes Wasser an einem sogenannten Eiskeim anlagert. Ein solcher Eiskeim kann ein Staubkorn, ein Russpartikel oder ein Bakterium sein. Irgendwo in grosser Höhe kommen Eiskeim und Wasser zusammen und bilden den Schneekristall, der auf seinem Weg in Richtung Erde wächst. Welche Form er dabei entwickelt, hängt von der Temperatur ab:
Tiefe Temperaturen etwa fördern die Plättchen- und Prismenform.
Unglaublich: Jeder Schneekristall hat seine eigene, unverwechselbare Form. Eins ist aber immer gleich: Die Kristalle sind sechseckig und symmetrisch.
Und wann entstehen Schneeflocken? Man könnte meinen, je kälter, desto besser, aber dem ist nicht so: Unter –30 Grad ist die Luft nämlich meist zu trocken, als dass sich nennenswerte Mengen Schneekristalle bilden könnten.

Schau mal genau hin: Wenn es schneit, zieh dir eine dunkle Mütze oder Jacke über und geh nach draussen. Ist es schön kalt, bleiben die Schneeflocken einen Moment lang auf den Kleidern liegen, und du kannst die Kristalle erkennen, aus denen die Flocken bestehen. MM
Durch veränderte Temperaturen verändert sich die Art, wie Wassermoleküle sich anlagern.
Während die Eiskristalle viele verschiedene Temperaturzonen durchqueren, können ganz unterschiedliche Formen von Kristallen entstehen.


«Werde nie erwachsen. Es ist eine Falle.» Kennst du diese Warnung vom Kinderhelden Peter Pan? Sie klingt, als ob Erwachsensein nur Unfreiheit brächte. Das muss nicht sein. Ich versichere dir, dass wir im Leben grosse Freiheiten haben. Wir müssen aber auch den Mut haben, sie zu nutzen. Dabei ist jede Lebensphase wichtig. Du durchläufst Kindheit und Jugend, Erwachsensein und Alter wie einen Kreislauf, so, wie du durch die Jahreszeiten gehst. Das ist von der Natur her so angelegt. Man kann diese


Phasen verzögern, aber aufhalten kann man sie nicht.
Die Kindheit gleicht dem Frühling: Sie ist voller Kreativität und Leichtigkeit. Dein Lebenssamen spriesst. Du wächst. Durch dieses Werden kommst du dir selbst auf die Schliche: Dank ständiger neuer Erfahrungen erkennst du immer mehr, warum du hier bist. Darum geht der junge Mensch auch in die Welt hinaus – um sich in ihr zu verwirklichen. Schliesslich wird es Sommer: Du schöpfst aus dem




In den Winterferien knipst Nina ein Foto nach dem andern. Wie schön doch die verschneite Landschaft aussieht. Im zweiten Foto haben sich jedoch sieben Unterschiede eingeschlichen. Kreise sie ein.










Vollen, folgst idealerweise deiner Berufung. Im Herbst des Lebens erntest du. Hoffentlich Gutes.
Und dann wollen wir auch noch einen stimmigen Winter. Darum sorgen wir vor: Wir leben so, dass wir im Alter innerlich reich sind und dass uns die äussere Welt nicht mehr zu kümmern hat. So werden weise, alte Leute geistig wieder leicht – wie die Kinder – und lachen über die Welt. Als ob sie die Bühne eines grossen Schauspiels wäre. MM

Eine Mutter erklärt die Welt: Journalistin Gabriela Bonin (50) beantwortet Kinderfragen.

Zahnstocher sind ideal, um die Zähne zu reinigen, wenn die Zahnbürste nach dem Essen nicht gerade zur Hand ist. Aber Zahnstocher sind noch für ganz andere Dinge nützlich: nämlich zum Spielen. Kannst du die Zahnstocher-Rätsel lösen?
























Wie viele Dreiecke sind in diesem Stern enthalten?










Lösungen:

Der Hund blickt nach rechts. Lege zwei Hölzchen um, so dass der Hund nach links blickt.

Lege ein Holz dazu und du hast eins weniger.


Hier erwarten dich:
• lustige Spiele
3.
Lösungen: 1. Es sind 20 Dreiecke enthalten (12 kleine, 6 mittlere und 2 grosse).
• tolle Basteltipps & Malvorlagen
• spannende Geschichten und vieles mehr ... Entdecke die fantastische Welt der Lilibiggs










326

Sie Eisenbahnromantik da, wo im 18. Jahrhundert die erste Dampfmaschine erfunden wurde und die ersten Eisenbahnstrecken der Welt entstanden sind. Entsprechend können Sie sich auf dieser Reise auf einige Eisenbahnerlebnisse der Superlative freuen. Gleichzeitig erleben wir die fantastischen Landschaften der Cotswolds und des Snowdon Nationalpark, die herrlichen Gärten von Bodnant uns Sissinghurst, begeben uns auf Spuren der Beatles in Liverpool und besichtigen York mit dem grössten Eisenbahnmuseum der Welt.
Ihr tolles Reiseprogramm:
1. Tag, Samstag – Anreise nach Lille Fahrt im komfortablen Extrabus nach Lille zur Zwischenübernachtung. Nachtessen im Hotel.
2. Tag, Sonntag – Dover – Sissinghurst Castle – Swindon
Bei der Überquerung des Ärmelkanals erwarten uns herrliche Blicke auf die Cliffs von Dover. Kurz später stossen wir auf das Sissinghurst Castle aus dem 15. Jahrhundert. Freuen Sie sich auf einen Traum in Weiss: den berühmte „White Garden“, der in England so populär ist wie kein zweiter. Übernachtungsort im Raum Swindon.
3. Tag, Montag – Cotswolds & Severn Valley Railway
Lassen Sie sich heute morgen in den Cotswolds von den sanften Hügelketten und den malerischen Ortschaften mit honigfarbenen Häusern verzaubern. In Kidderminster erwartet uns die Severn Valley Railway für eine herrlich nostalgische Panoramafahrt nach Bridgnorth – tolle Fotomomente garantiert. Übernachtung im Raum Birmingham.
4. Tag, Dienstag – Bodnant Gardens & Welsh Food Centre
Heute morgen passieren wir die Grenze zu Wales. Mit Bodnant Gardens starten wir den Tag mit einem absoluten Höhepunkt – die Gärten gehören zweifelsohne zu den eindrucksvollsten in Grossbritannien. Später kosten wir regionale Produkte im Bodnant Welsh Food Centre – en Guetä! Für die nächsten zwei Tage ist unser Hotel in Nordwales der ideale Ausgangspunkt.
5. Tag, Mittwoch – Snowdon Mountain Railway & Ffestiniog Railway Heute erwartet uns der atemberaubend schöne Snowdonia-Nationalpark. Von Llanberis bringt uns die bekannte Snowdon Mountain Railway bis auf den Gipfel des Mount Snowdon – fantastisch! Wieder unten im Tal unternehmen wir eine herrliche Fahrt mit der Ffestiniog Railway, der ältesten aktiven Schmalspurbahn der Welt.
6. Tag, Donnerstag – Liverpool, die Beatles & East Lancashsire Railway Auf den Spuren der Beatles zeigen wir Ihnen heute bei einer tollen Stadtführung Liverpool (Eintritt Beatles Museum inbegriffen). Am Nachmittag wartet eine weitere romantische Zugfahrt auf uns. Von Heywood fahren Sie mit der East Lancashire Railway durch das wunderschöne Irwell Valley nach Rawtenstall. Übernachtung im Raum Leeds.
7. Tag Freitag – York & das Eisenbahnmuseum Freuen Sie sich im zauberhaften York auf wunderschöne Fachwerkhäuser, gepflasterte enge Gassen und reich verzierten Stadttore! Nach der Führung können Sie im schönen Eisenbahnmuseum letzte Eindrücke der britischen Bahngeschichte sammeln bevor wir zum Hafen nach Hull fahren, wo uns das Fährschiff für die Überfahrt erwartet. Übernachtung und Nachtessen an Bord.
8. Tag, Samstag – Heimreise Am Morgen erreichen wir Rotterdam/Zeebrügge von wo aus wir die Heimreise antreten.
Noch mehr sparenbis 100% REKA-Checks! Organisation: Holiday Partner, 8852 Altendorf
Limitierte Plätze! Sofort buchen & profitieren! Tel. 0848 00 77 88

✓ Fahrt im komfortablen Extrabus
✓ Fährüberfahrt Calais – Dover
✓ Fährüberfahrt Hull-Rotterdam/Zeebrügge (Basis 2 Bett-Kabine Innen, mit 1 x Übernachtung inkl. Halbpension)
✓ 6 Übernachtungen in Frankreich, England & Wales in guten und gehobenen Mittelklassehotels inkl. Halbpension
✓ Zugfahrt mit der «Severn Valley Railway» (Kidderminster - Bridgnorth)
✓ Zugfahrt mit der „Snowdon Mountain Railway“ (Hin- und zurück)
✓ Zugfahrt mit der «Ffestiniog Railway» (Blaenau Ffestiniog - Porthmadog)
✓ Zugfahrt mit der «East Lancashire Railway» (Heywood – Rawtenstall)
✓ Eintritt Sissinghurst Castle Gardens
✓ Eintritts Bodnant Gardens
✓ Bodnant Welsh Food History Tour
✓ Stadtführung in Liverpool
✓ Eintritt Beatles Museum in Liverpool
✓ Stadtführung in York
✓ Eintritt National Railway Museum York
✓ Eigene Schweizer Reiseleitung während der ganzen Reise
- Alles schon dabei! Wählen Sie Ihr Reisedatum: 8 Reisetage ab nur
Reise a) 16. - 23. Juni 2018 Reise b) 15. - 22. September 2018
Unser Sonderpreis für
Preis pro Person im Doppelzimmer in guten und gehobenen Mittelklassehotels Fr. 1699.-
Nicht inbegriffen/zusätzlich wählbar: Aussenkabine für Fährüberfahrten: Fr. 40.Einzelzimmerzuschlag (Rundreise): Fr. 380.Einzelkabinenzuschlag Innen (Fähre): Fr. 45.Einzelkabinenzuschlag Aussen (Fähre): Fr. 85.Buchungsgebühr Fr. 20.- pro Person
Sie wählen Ihren Bus-Einsteigeort: Aarau, Basel, Bern, Luzern, Pfäffikon SZ, St. Gallen, Sargans, Thun, Winterthur , Zürich
Die Lazarus-Kirche in Larnaca ist eine der Sehenswürdigkeiten Zyperns.

Exklusives Angebot von Hotelplan:
Geniessen Sie acht Tage Erlebnisferien auf Zypern mit 100 Franken Rabatt.
Die drittgrösste Mittelmeerinsel bietet für alle etwas: Auf Zypern befinden sich ruhige Buchten mit Sandstrand, imposante Felsformationen und Berge bis zu einer Höhe von fast 2000 Metern. Viele historische Bauten und Ausgrabungsstätten zeugen von der langen Geschichte und von den zahlreichen Völkern, die Zypern in der Vergangenheit besiedelt haben.
Das sind die Highlights der Reise:
• die LazarusKirche
• das TroodosGebirge
• die historische Stadt Paphos
• entspannte Tage am Strand
So verläuft die Reise: Während der 8tägigen Erlebnisreise wohnen Sie im Hotel Limanaki
Beach in Ayia Napa. Auf den geplanten Ausflügen besuchen Sie unter anderem die LazarusKirche in Larnaca, deren Grundmauern aus dem 9. Jahrhundert stammen, sowie das vulkanische TroodosGebirge, die grösste und höchste Gebirgskette der Insel. Eine Tagestour führt Sie nach Paphos, das mit seiner 2000 Jahre alten Geschichte zum UnsecoWeltkulturerbe zählt.
Das ist inbegriffen: Sieben Übernachtungen im Hotel Limanaki Beach, Ayia Napa, Ausflüge im klimatisierten Reisebus mit lokalem, Deutsch sprechendem Reiseleiter gemäss Ausschreibung sowie der Direktflug mit Edelweiss Air oder einer vergleichbaren Fluggesellschaft in der EconomyKlasse. MM
Informationen: Buchen und profitieren
Reisedaten:
7. 4.–14 4. 2018
26 5.–2. 6. 2018
27 10.–3. 11 2018
10 11.–17 11 2018
Preis pro Person: ab Fr. 890.–, inklusive Rabatt für Neubuchungen bis 28 Februar 2018
Infos und Buchung: Tefefon: 0848 82 11 11 www.hotelplan.ch/ o126842
Tipp: Wir empfehlen das KombiVersicherungspaket der Europäischen Reiseversicherungs AG. Es gelten die Allgemeinen Vertrags und Reisebedingungen der MTCH AG. Preisund Programmänderungen jederzeit vorbehalten. Preisstand 12 1. 18






9.80 Hit 4er-Pack

Cucina & Tavola Küchentücher im 4er-Pack erhältlich in diversen Farben, 50 x 70 cm, z.B. lila, gültig bis 5.2.2018








Cucina & Tavola Muffinförmchen 2 verschiedene Einhorn-Sujets, 30 Stück 3.90 Hit
Bei allen Angeboten sind bereits reduzierte Artikel ausgenommen.
ANGEBOTE GELTEN NUR VOM 23.1. BIS 5.2.2018, SOLANGE VORRAT







Cucina & Tavola Melamin-Becher Einhorn pro Stück 3.90




Cucina & Tavola Henkelbecher Einhorn erhältlich in verschiedenen Sujets, pro Stück 3.90



Cucina & Tavola Servietten Einhorn erhältlich in 2 verschiedenen Sujets, 33 x 33 cm, 50 Stück 3.90




Lösen Sie das Kreuzworträtsel und gewinnen Sie eine von 5 Migros-Geschenkkarten im Wert von je 100 Franken. Für die grüne Zusatzlösung winken Ihnen 5 MigrosGeschenkkarten im Wert von je 50 Franken.




So nehmen Sie teil:
Hauptpreis (blaues Lösungswort)
Tel: 0901 560 041 (Fr. 1.–/Anruf) SMS : Senden Sie MMD1 gefolgt vom Lösungswort, Ihrem Namen und Ihrer Adresse an die 920 (Fr. 1.–/SMS). Bsp.: MMD1 SOMMER
Hans Muster, Musterweg 22, 8000 Musterdorf Internet www.migrosmagazin.ch/wettbewerbe
Post karte: (A-Post): Migros-Magazin, Kreuzworträtsel, Postfach, 8074 Zürich Zusatzpreis (grünes Wort)
Tel: 0901 560 065 (Fr. 1.–/Anruf) SMS : Senden Sie MMD5, gefolgt vom Lösungswort, Ihrem Namen und Ihrer Adresse an die 920 (Fr. 1.–/SMS) Bsp.: MMD5 WINTER. Hans Muster, Musterweg 22, 8000 Musterdorf Chancengleiche WAP -Teilnahme ohne Zusatzkosten http://m.vpch.ch/MMD12315 (gratis übers Handynetz) Teilnahmeschluss: Sonntag, 28.1.2018, 24 Uhr




Rätsel

Hauptpreis: Alex Vogel, Aesch BL; Verena Eggli, Erlenbach ZH; Regina Burri, Bern; Elisabeth Heiniger, Zell LU; Roswitha Rast, Watt ZH
Zusatzpreis: Marcel Cuendet, Rorschacherberg SG; Ruth Plaz, Basel; Elisabeth Kengelbacher, St. Gallen; Sira Meier, Dietlikon ZH; Walter Stahel, Pfäffikon ZH
Teilnahmebedingungen: Über die Verlosung wird keine Korrespondenz geführt. Der Rechtsweg ist ausgeschlossen. Keine Barauszahlung. Computergesteuerte Massenteilnahmen sind nicht gewinnberechtigt. Die Mitarbeiter der Migros-Medien sind von der Teilnahme ausgeschlossen. Gewinner werden schri lich benachrichtigt und mit Namen und Wohnort verö entlicht.




Aktion gültig auf das gesamte Sortiment von Grether’s Pastilles.



Drei Monate lang reifen Grether’s Pastillen, um ihre wohltuende Wirkung für Hals und Stimme zu entfalten. Mit der Original- Rezeptur von 1850 werden ausgesuchte, hochwertige Rohstoffe wie pflanzliches Glyzerin, natürlicher Johannisbeersaft und die Rotalge Agar-Agar nach Schweizer Manufaktur-Manier verarbeitet.
Was lange reift, das tut auch gut. Seit 1850.
Doetsch Grether AG • CH-4002 Basel • www.grethers-pastilles.ch MADE
Erhältlich in grösseren Migros-Filialen.

ANGEBOTE GELTEN NUR VOM 23.1. BIS 5.2.2018, SOLANGE VORRAT




DOE_Anzeige_Blackcurrant_209x141_Migros_DF.indd 1
















4.70 statt 5.90 20%

Grether’s Pastilles Blackcurrant ohne Zucker 60 g-Dose



5.80 statt 7.30 20%
Grether’s Pastilles Blackcurrant ohne Zucker 100 g-Beutel








Schmutzig










Plastikabfallver schmut zt dieMeere.UnsereOzeane drohenzugigantischen Mülldeponien zu werden –mit tödlichenFolgenfür dieMeeresbewohner. Unterstützen Sie unsere Kampagne fürsaubere Meere:oceancare.org







Ermitteln Sie für jede Quizfrage den richtigen Lösungsbuchstaben. Der Reihe nach in die acht Lösungsfelder eingetragen, ergibt sich das Lösungswort.
1. In welchem dieser Wörter kommt kein Buchstabe doppelt vor?
G Autofahrt L Telefon M Faltenrock
2. Welcher Fluss verläuft zwischen der schweizerisch-französischen Grenze? R Saane O Doubs A Aare
3. Wie hoch ist die Körpertemperatur eines gesunden Menschen?
I 30°–32° L 36°–37° U 37–41°
4. Wie nennt sich eine GPS-Schnitzeljagd? E Geocaching F G-Orienteering B Geotrekking
5. Bei welchem Tier wachsen «Rosenstöcke»?
S Pferd I Giraffe K Hirsch
6. Welche Tiere wohnen in riesigen Mengen auf der japanischen Insel Ōkunoshima?
U Hasen A Mäuse T Schlangen
7. Welche Münze war im 17. bzw. 18. Jahrhundert in den Niederlanden im Umlauf? N Crazie E Deut I Laurel
8. Wo befindet sich der Hugi-Gletscher? D Wallis R Island L Antarktis
Quiz & Paroli
3 × 100 Franken zu gewinnen
So nehmen Sie teil:
Tel: 0901 560 042 (Fr. 1.–/Anruf)
SMS : Senden Sie MMD2, gefolgt vom Lösungswort, Ihrem Namen und Ihrer Adresse an die 920 (Fr. 1.–/SMS).
Bsp.: MMD2 TASTSINN. Hans Muster, Musterweg 22, 8000 Musterdorf
Postkarte (A-Post): Migros-Magazin, Quiz, Postfach, 8074 Zürich
Internet www.migrosmagazin.ch/ wettbewerbe
Teilnahmeschluss:
Sonntag, 28.1.2018, 24 Uhr
Teilnahmebedingungen: Auf der ersten Rätselseite
Au ösung Nr. 3: ATHLETEN
Gewinner Nr. 2:
Claudia Kleiner, Suberg BE; Heinz Cavalli, Fislisbach AG; Lydia Berger, Luzern
Füllen Sie die zehn Wörter in das Rätselgitter ein. Die Lösung ergibt sich aus den Buchstaben in den Feldern 1-5.
Füllen Sie die zehn Wörter in das Rätselgitter ein. Das Lösungswort ergibt sich aus den Buchstaben in den Feldern 1 bis 5:
Au ösung Nr. 3: KREIS
Gewinner Nr. 2: T.K., ZH; Frieda Albisser, Luzern; Lotte Brenner, Oberwil BE
3 × 100 Franken zu gewinnen
So nehmen Sie teil:
Tel: 0901 560 043 (Fr. 1.–/Anruf)
SMS : Senden Sie MMD3, gefolgt vom Lösungswort, Ihrem Namen und Ihrer Adresse an die 920 (Fr. 1.–/SMS).
Bsp.: MMD3 OSTEN. Hans Muster, Musterweg 22, 8000 Musterdorf
Postkarte (A-Post): Migros-Magazin, Paroli, Postfach, 8074 Zürich
Internet www.migrosmagazin.ch/ wettbewerbe
Teilnahmeschluss: Sonntag, 28.1.2018, 24 Uhr
Teilnahmebedingungen: Auf der ersten Rätselseite




Ihr Reiseunternehmen im Rhonetal mitpfiffigen Ideen…
ternehmen im Rhonetal

Kaffee und etwas Feinem vom Beck und geniessen n der Plan ung bis zur Durchführung derReisen Kultur und Geschichte der reizvollen Destinationen eschwertes, ent spanntes undein erlebnisreiches
Reisen erleben und geniessen ine lückenlose Organisation und Qualität von der Planung bis zur Durchführung derReisen Reiseprogramme vermitteln Ihnen Geheimnisse, Kultur und Geschichte der reizvollen Destinationen nseren Reisecarssorgen wirdafür,dassSie ein unbeschwertes, entspanntes undein erlebnisreiches dürfen.
.eine Klasse für sich
Bei jederReise begrüssenwir Sie mit Kaffee und etwas
1. Tag Schweiz – Trier

und etwas Feinem vom Beck d genies sen g bis zur Durchführung derReisen und Geschichte der reiz vollen Destinationen. ertes, ent spanntes undein erle bnisreiches
Ihr Reiseunternehmen im Rhonetal mitpfiffigen Ideen… ...eine Klasse für sich
besser als…. und günstiger !
Ihr Reiseunternehmen im Rhonetal mitpfiffigen Ideen… ...eine Klasse für sich
Gestärkt vom feinen Frühstücksbuffet an Bord, laden wir Sie zum Stadtrundgang durch Cochem ein. Eine Zierde für die Stadt sind auch das 1739 im Barockstil erbaute Rathaus, der Marktplatz mit Martinsbrunnen und die alten, mit Moselschiefer gedeckten FachwerkGiebelhäuser in den engen bergi-gen Gassen.
Reisen erleben und geniessen
§ Fahrt im exklusiven „GBS BISTRO-Liner"
Reiseun mitpfiffigen
In unserem exklusiven "GBS Bistro-Liner" fahren Sie heute in das moselfränkische Trier. Geniessen Sie den Aufenthalt in dieser wunderschönen Stadt. Wie wäre es mit einer Stadtrundfahrt im „Römer-Express“? Die älteste Stadt Deutschlands hat einiges an Sehenswürdigkeiten zu bieten. Anschliessend bringt Sie der Bus zum Hafen, wo die MS Swiss Crystal bereits auf Ihre Ankunft wartet. Nach der Einschiffung und Begrüssung geniessen Sie das Abendessen an Bord. Das Schiff lichtet im Laufe des Abends den An-ker und nimmt Kurs auf TrabenTrarbach, welches in den frühen Morgenstunden des nächsten Tages erreicht wird.
onetal
Setra416 HDH 5*****
Reisen erleben und geniessen
für sich etwas Fe inem vom Beck d genies sen
Setra416 HDH 5*****
Unsere Leidenschaft ist,eine lückenlose Organisation und Qualität von der Planung bis zur Durchführung derReisen einzubringen. Interessante Reiseprogramme vermitteln Ihnen Geheimnisse, Kultur und Geschichte der reizvollen Destinationen Bestens aufgehobenin unseren Reisecars sorgen wirdafür,dassSie ein unbeschwertes, entspanntes undein erlebnisreiches Reisevergnügen geniessen dürfen.
Während des Mittagessens legt das Schiff für einen Erkun-
anschliessend in Cochem ab und nimmt direkten Kurs auf Koblenz, welches am Abend erreicht wird. Nach dem Abend-essen haben Sie noch Zeit dungsspaziergang, z.B. dem Ufer entlang zum Dreiländereck.
ose Organisation und Qualität von der Planung bis zur Durchführung derReisen ramme vermitteln I hnen Geheimnisse, Kultur und Geschichte der reizvollen Destinationen. eren Reisecarssorgen wirdafür,dassSie ein unbeschwertes, entspanntes undein erlebnisreiches
Nach dem Frühstück entdecken Sie auf einem geführten Rundgang die Jugendstilstadt, welche um die Jahrhundertwende die zweitgrößte Weinhandelsstadt Europas nach Bordeaux war. Riesige Kelleranlagen unter der Stadt zeugen vom Reichtum der damaligen Zeit. Heute lädt diese Unterwelt mit über 30 Kellern zur spannenden Entdeckung der Geschichte des historischen Weinbaus ein. Anschliessend Mittagessen auf der MS Swiss Crystal und Weiterfahrt nach Beilstein, welches in den Abendstunden erreicht wird. Nach dem Abendessen auf dem Schiff haben. Sie noch Zeit, für individuelle Spaziergänge
Im Jumbo Anhänger hat es Platz für bis zu 40 Fahrräder &jedes wird mit zwei grossen Lederkissengeschützt
Im Jumbo Anhänger hat es Platz für bis zu 40 Fahrräder &jedes
jederReise begrüssenwir Sie mit Kaffee und etwas Feinem vom Beck
lich betreut.VertrauenSie auf
e: Ein



Mit herzlichen Gr

Eschmattenweg 9 / 3952 SustenTel.+ 4127 www.gbs.reisen E-mail : info@gbs.reisen

Peter Wirz


sowie
Unsere Leidenschaft ist,eine lückenlose Organisation und Qualit einzubringen. Interessante Reiseprogramme vermitteln Ihnen Geheimnisse, Bestens aufgehobenin unseren Reisecars sorgen wirdafür,dassSie Reisevergnügen geniessen dürfen. besser als…. und günstiger !
Setra416 HDH 5*****
§3 Nächte / 2 Tage Flussfahrt auf der komfortablen MS Swiss Crystal ****, Basis Doppelkabine (Smaragddeck) mit DU/WC/ Klimaanlage
Unsere Leidenschaft ist,eine lückenlose Organisation und Qualität von einzubringen. Interessante Reiseprogramme vermitteln Ihnen Geheimnisse, Bestens aufgehobenin unseren Reisecars sorgen wirdafür,dassSie ein Reisevergnügen geniessen dürfen. besser als…. und günstiger !
erleben
erleben
Reiseunternehmen mitpfiffigen Setra416 HDH 5*****
Reisen erleben und geniessen
Setra 431 DT4****
Setra 431 DT4****
enzu garantieren , werdenSie auf unserenReisen persönlich betreut.VertrauenSie auf unsere Erfahrung te und erholsame Ferientage. Wir sorgen dafür, dassSie denhektischen Alltag hinter sich lassen und d U che nehmen können. Einwandfreies Fahren, interessante Information sein, ge rt ebenfalls zu unseren Qualitäten. , erIhrenSie Verein, Jahrgänger oder Schule auf einer Reise bei uns will
rgen dafür, dassSie denhek freies Fahren, intere iner Reise bei
Unsere Leidenschaft ist,eine lückenlose Organisation und einzubringen. Interessante Reiseprogramme vermitteln Ihn Bestens aufgehobenin unseren Reisecars sorgen wirdafür,dassSie Reisevergnügen geniessen dürfen. besser als…. und günstiger !
rchführung derReisen d Geschichte der reiz vollen Destinationen. tes undein erlebnisreiches
Nach dem Frühstück an Bord erfolgt die Ausschiffung. Weiterfahrt im GBS BISTRO-Liner über die schöne Panoramaroute, den Rebbergen des Rheins entlang und durch die Gegend der Loreley nach Rüdesheim. Mittagshalt in der malerischen Stadt, welche durch ihre Lage und die lebensfrohe Drosselgasse bekannt ist. Anschliessend erfolgt die gemütliche und bequeme Rückreise ins 13 Sterne Land, wo wir uns am Abend von Ihnen verabschieden werden.

erenReisen pers ch betreut.VertrauenSie auf unsere Erfahrung rgen dafür, dassSie denhek tag hinter sich la nwand ante Informationsvermit ein perfekterGastgeberzu sein, gehört ebenfalls zu unseren Qualit Wir freuen uns jetztschon, Sie oderIhren Verein, Jahrgänger oder Sc uns will en. Ihr Reiseunternehmen im Rhonetal mitpfiffigen Ideen… ...eine Klasse für
Bei jederReise begrüssenwir Sie mit Kaffee
Bei jederReise begrüssenwir Sie
Bei jederReise begrüssenwir Sie mit Kaffee und etwas Feinem vom Beck
Setra416 HDH 5*****
§ 3 x herrliches Frühstücksbuffet
§ 2 x reichhaltiges Mittagessen an Bord
Unsere Leidenschaft ist,eine lückenlose Organisation und Qualität von der Planung bis zur Durchführung derReisen einzubringen. Interessante Reiseprogramme vermitteln Ihnen Geheimnisse, Kultur und Geschichte der reizvollen Destinationen Bestens aufgehobenin unseren Reisecars sorgen wirdafür,dassSie ein unbeschwertes, entspanntes undein erlebnisreiches Reisevergnügen geniessen dürfen.
§ 3 x exquisites Abendessen an Bord
Bei jederReise begrüssenwir Sie mit Kaffee und etwas Feinem vom Beck
§ Kofferservice an Bord
§ Stadtführung Traben-Trarbach, Cochem
§ EU-Strassensteuer und Hafentaxen
§ Erfahrene Reisebetreuung vor Ort
Ev. anfallende Kurtaxen sind im Preis nicht inbegriffen und vor Ort zu bezahlen.
Setra 431 DT4****
Im Jumbo Anhänger hat es Platz für bis zu 40 Fahrräder &jedes wird mit zwei grossen Lederkissengeschützt
Im Jumbo Anhänger hat es Platz für bis zu 40 Fahrräder &jedes wird mit zwei grossen Lederkissengeschützt
Im Jumbo Anhänger hat es Platz für bis zu 40 Fahrräder &jedes wird mit zwei grossen Lederkissengeschützt
Doppelkabine Smaragddeck 899.-
Doppelkabine Rubindeck +120.-
Einzelkabine Smaragddeck auf Anfrage
UmIhr Wohlbefindenzu garantieren, werdenSie auf unserenReisen für genussvolle, entspannte und erholsame Ferientage. Wir Kursaufdas Schöne und Unvergessliche nehmen können. ein perfekterGastgeberzu sein, gehört ebenfalls zu unseren Wir freuen uns jetztschon, Sie oderIhren Verein, Jahrgänger
Landeswährung EURO Reisedokumente: Sie benötigen eine gültige ID oder Reise pass
erenReisen persönlich betreut.VertrauenSie auf unsere Erfahrung r sorgen dafür, dassSie denhektischen Alltag hinter sich lassen und Einwandfreies Fahren, interessante Informationsvermittlung sowie s zu unseren Qualitäten. , Jahrgänger oder Schule auf einer Reise bei uns willkommen zuheissen.
Bei uns können Sie auch mit oder
PS: Auf Anfrage können Sie auch mit WIR oder reka bei uns bezahlen!
beza
Die Geschenkidee: Ein Reisegutschein
Usere Reisen finden Sie auf www.gbs.reisen


Mit herzlichen Gr Peter Wirz besser als…. und günstiger !
Bei it oder bezahlen
Die Geschenkidee: Ein Reisegutschein

Usere Reisen finden Sie auf www gbs reisen

Die Geschenkidee: Ein Reisegutsche
UmIhr Wohlbefindenzu garantieren, werdenSie auf unserenReisen pers für genussvolle, entspannte und erholsame Ferientage. Wir sorgen dafür, Kursaufdas Schöne und Unvergessliche nehmen können. Einwandfreies ein perfekterGastgeberzu sein, gehört ebenfalls zu unseren Qualitäten. Wi uns jetztsc erIhren Vere oder Schu
UmIhr Wohlbefindenzu garantieren, werdenSie auf unserenReisen für genussvolle, entspannte und erholsame Ferientage. Wir sorgen Kursaufdas Schöne und Unvergessliche nehmen können. Einwa ein perfekterGastgeberzu sein, gehört ebenfalls zu unseren Qualit Wir freuen un , Jahrgänger oder

Mit herzlichen Gr Peter Wirz

Usere Reisen find www gbs
od zahlen. dee: Ein Reisegutschein


Eschmattenweg 9 / 3952 SustenTel.+ gbs.reisen E-mail



Füllen Sie die leeren Felder mit den Zahlen 1 bis 9. Dabei darf jede Zahl in jeder Zeile, jeder Spalte und in jedem der neun 3 × 3-Blöcke nur ein Mal vorkommen. Die Lösungszahl ergibt sich aus den blauen Feldern von links nach rechts.
Au ösung Nr. 3: 315
Gewinner Nr. 2: Ruth Arnold, Wolfenschiessen NW; Christian Bertin, Basel; Elisabeth Hunziker, Reinach AG; Michel Geiser, Lamboing BE; André Savoy, Tatroz FR
Bimaru Brücken
Die Zahl bei jeder Spalte oder Zeile bestimmt, wie viele Felder durch Schi e besetzt sind. Diese dürfen sich nicht berühren und müssen vollständig von Wasser umgeben sein, sofern sie nicht an Land liegen.

Impressum
MIGROS-MAGAZIN
vormals: Wir Brückenbauer, Wochenblatt des sozialen Kapitals, Organ des Migros-Genossenschafts-Bundes, Migrosmagazin.ch
Auflage/Leserschaft: Beglaubigte Auflage: 1 554 258 Ex. (WEMF 2017)
Leserschaft: 2 373 000 (WEMF, MACH Basic 2017-2)
Adresse Redaktion und Business Limmatstrasse 152, Postfach 1766, 8031 Zürich, Telefon: 058 577 12 12 Fax: 058 577 12 08 redaktion@migrosmagazin.ch
Herausgeber Migros-Genossenschafts-Bund
Leitung Direktion
Migros-Medien
Lorenz Bruegger Publizistische Leitung Monica Glisenti
Leitung Redaktionen
Migros-Medien Franz Ermel
Sudoku
So nehmen Sie teil:
Tel: 0901 560 044 (Fr. 1.–/Anruf)
SMS : Senden Sie MMD4, gefolgt von der Lösungszahl, Ihrem Namen und Ihrer Adresse an die 920 (Fr. 1.–/SMS).
Bsp.: MMD4 123. Hans Muster, Musterweg 22, 8000 Musterdorf Postkarte (A-Post): Migros-Magazin, Sudoku, Postfach, 8074 Zürich Internet www.migrosmagazin.ch/ wettbewerbe
Teilnahmeschluss: Sonntag, 28.1.2018, 24 Uhr
Teilnahmebedingungen: Auf der ersten Rätselseite
Jeder Kreis stellt eine Insel dar. Die Zahl darin gibt an, wie viele Brücken dort enden. Brücken sind nur zu horizontal oder vertikal benachbarten Inseln erlaubt. Diese dürfen mit einfachen oder doppelten Brücken verbunden werden. Am Schluss sollen alle Inseln miteinander verbunden sein. Verboten: Kreuzungen, diagonale Brücken und mehr als zwei Linien.
Leitung Ressort
Gesellschaft & Familie
Sabine Lüthi a.i., Daniel Sidler a.i., Reto Vogt a.i.
Leitung Ressort Health & Beauty
Roberto Zimmermann a.i.
Leitung Ressort Food
Roberto Zimmermann
Leitung Produktion
Remo Leupin
Leitung Business Rolf Hauser
Leitung Beratung & Verkauf
Thomas Brügger
Abonnemente: Sonja Frick
abo@migrosmagazin.ch
Tel.: 058 577 13 00, Fax: 058 577 13 01
Druck: NZZ Media Services AG, Tagblatt Print
PUNKTEN. SPAREN. ERLEBEN.
Die Cumulus-Mastercard bietet viele Vorteile. Sie zahlen sowohl für die Haupt- als auch für die Zusatzkarte keine Jahresgebühr. Auch in den Folgejahren nicht. Zudem bezahlen Sie an immer mehr Orten kontaktlos und sammeln weltweit Cumulus-Punkte.
Fuerteventura steht für herrliche, fast endlos lange Sandstrände, ganzjährig angenehme Temperaturen und Sonne pur. Ob Wassersport, Erholung oder Party – geniessen Sie mit Migros Ferien eine Auszeit auf der vielfältigen Kanareninsel.
ANGEBOT


Aktionsdauer: bis 31. März 2018





Pro tieren: Beantragen Sie jetzt Ihre kostenlose Cumulus-Mastercard mit 3000 Cumulus-Punkten Startbonus. Füllen Sie einfach den Onlineantrag unter www.cumulus-mastercard.ch/mmagazin aus und senden Sie diesen zurück. Ihre Vorteile:
– keine Jahresgebühr, auch in den Folgejahren
– kostenlose Zusatzkarte
– weltweit Cumulus-Punkte sammeln
– kontaktloses Bezahlen
Hinweis: Das Angebot gilt nur für Neukunden. Herausgeberin der CumulusMastercard ist die Cembra Money Bank AG.
Weitere Informationen: www.cumulus-mastercard.ch
ANGEBOT









Aktionsdauer: vom 22. Januar bis 5. Februar 2018
für Abreisen zwischen dem 22. Januar und dem 31. Oktober 2018
Pro tieren: Buchen Sie jetzt Ihre Fuerteventura-Ferien unter www.migros-ferien.ch/d-103 oder wählen Sie die Gratis-Nummer 0800 88 88 12. Geben Sie bei der Reservation Ihre CumulusNummer an und pro tieren Sie während der Aktionsdauer von 10-fachen Cumulus-Punkten.
Hinweis: Bei Migros Ferien erhalten Sie pro 2 Franken Umsatz ein Cumulus-Punkt.
Weitere Informationen: www.migros-ferien.ch
Die ganze Welt von Cumulus und den Newsletter nden Sie unter www.migros.ch/cumulus Bei Fragen kontaktieren Sie bitte die Cumulus-Infoline: 0848 85 0848
2 x








2 NÄCHTE, 2 x FRÜHSTÜCK



















Tauschen Sie Ihre blauen Cumulus-Bons telefonisch 0848 85 0848 oder unter www.migros.ch/cumulus-extra ein und buchen Sie unter www.swisshotels.com/cumulus oder 0848 84 84 48. Die detaillierten Einlösebedingungen nden Sie unter www.migros.ch/cumulus-extra/hotelleriesuisse. Angebot gültig bis 15. April 2018 oder gemäss Hoteldetails unter www.swisshotels.com/cumulus. Auch für Einzelreisende und Familien buchbar. Bei einer Übernachtung in einem Hotel mit Famigros-Logo erhalten Mitglieder von Famigros eine tolle Überraschung für ihre Kinder.




«Papi
Die Skifahrerin Denise Feierabend hat die Selektionskriterien für die Olympischen Winterspiele erfüllt. Für einen Start in Südkorea schöpft sie Kraft bei Aufenthalten im Kloster Engelberg und von ihrem verstorbenen Vater – seine Anwesenheit spürt sie in jedem Rennen.
Text: Andreas Bättig Bilder: Mischa





Mein Lieblingsprodukt
«Die Blévita-Cracker mit Sesam sind ideal als Trainingssnack auf der Piste. Sie sind nicht so trocken wie andere ähnliche Produkte.»
1 Mein Kraftort «Engelberg ist für mich ein Ort, an dem ich Energie tanke. Ich mag die Engelberger. Sie sind ein bodenständiges Volk. Ich besuche oft das Kloster, um für meinen Papi eine Kerze anzuzünden: Er ist bei einem Gleitschirmunfall ums Leben gekommen.»
2 Mein Hobby «Ich bin polysportiv. Im Sommer wandere und bike ich gern, im Winter skate ich mit den Langlaufski durch die Wälder und geniesse die Ruhe in der Natur.»
3 Meine Teesammlung «Ich trinke sehr gern Tee. Im Winter wärmt er so schön.
Name Denise Feierabend (28) Sternzeichen Widder Lebenslauf «Ich bin in Engelberg aufgewachsen und habe dort die Sportmittelschule besucht. Dass ich seit acht Jahren Profiskifahrerin sein kann, ist ein grosses Privileg. Es gibt einfach nichts Besseres, als an einem verschneiten Tag, bei schönem Wetter und glitzerndem Schnee, auf der Piste zu sein. Bereits in meinem ersten Weltcuprennen in Zagreb 2008 konnte ich in die Punkte fahren. Zu meinen grössten Erfolgen gehört der Sieg im Slalom an den JuniorenWeltmeisterschaften in GarmischPartenkirchen 2009. Bei der HeimWM in St. Moritz im Februar 2017 verfehlte ich als Vierte nur knapp das Podest in der Kombination. Im Februar möchte ich an den Olympischen Spielen in Pyeongchang antreten.»
Morgens mache ich mir einen Grüntee zum Aufwachen, abends einen Kräutertee zum Einschlafen.»
4 Meine Kochkünste «Während der Wettkampfsaison essen wir oft in Hotels. Deshalb geniesse ich es, wenn ich zu Hause selber kochen kann.»
5 Mein Buch «So ein E-Reader ist einfach praktisch. Man kann viele Bücher gleichzeitig mitnehmen und im Hotelzimmer bei Dunkelheit lesen, wenn die Zimmernachbarin schon schlafen will.»
6 Meine Familie «Meine Mutter Irene (55), ihr Lebenspartner Willy Spaar (68) und meine Schwester Michèle (25) sind die wichtigsten Menschen in meinem Leben. Und während der Wettkämpfe spüre ich, dass mein verstorbener Papi bei mir ist. Ich weiss, dass er bei jedem Rennen von oben zuschaut.» MM





2.90
Fasnachtschüechli gross
6 Stück, 216 g





Bei allen Angeboten sind M-Budget und bereits reduzierte Artikel ausgenommen.






3.20
Fasnachtschüechli Kakao 200 g Mini-Fasnachtschüechli (ohne italienische), 90 g 1.55 statt 1.95 20% ANGEBOTE GELTEN NUR VOM 23.1. BIS 29.1.2018, SOLANGE VORRAT


